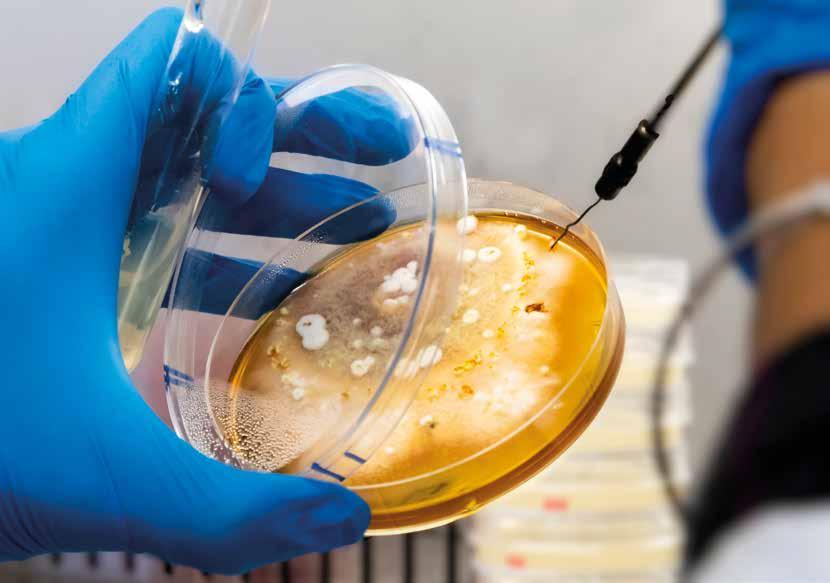

RAPPORTO



CENTRO TRASFERIMENTO TECNOLOGICO
Fondazione Edmund Mach Email info.ctt@fmach.it Telefono 0461 615461 www.fmach.it/CTT
Claudio Ioriatti
CURATORE
Erica Candioli
FOTOGRAFIE
Archivio FEM-CTT e autori, Archivio IDESIA, Roberta Cainelli, Giovanni Cavulli, Matteo de Concini, Matteo Festi, Franca Ghidoni Pag. 103: Francesco Gubert
REFERENZE PUBBLICAZIONI
Biblioteca FEM
PROGETTO GRAFICO ED EDITORIALE
IDESIA - www.idesia.it
ISSN 20-37-7541
© 2022, Fondazione Edmund Mach
Via Edmund Mach 1, 38098 San Michele all’Adige (Trento)
Prefazione 7
LE RELAZIONI 9
Il 2021 del Centro Trasferimento Tecnologico 10
Il trentennale percorso verso la sostenibilità della viticoltura trentina 20 Andamento climatico 2021 24
La gelata perfetta 26 L’annata frutticola 28
Come risponde il biota del suolo alla conversione di un frutteto integrato al biologico? 30
Studio dell'interazione tra ammendanti e sostanza organica del suolo: il progetto Hydrorg 34 Esperienza di diradamento dei frutti con intervento meccanico 36
Valutazione dell’impatto della strategia Farm to Fork sulla melicoltura trentina con il metodo dell’azienda ordinaria 39
Aphelinus mali, la vespetta introdotta dalle Americhe un secolo fa per il controllo biologico dell’afide lanigero 43
Moria del melo: analisi delle indagini e delle attività finora condotte 47
Il rilievo del PAD per valutare il rischio di infezioni primarie di ticchiolatura 51 Concluso il progetto PEI AGRI Pflanzenschutz 54
L’accreditamento del Laboratorio di Diagnosi Fitopatologica nel nuovo regime fitosanitario di protezione delle piante 55
Ottimizzare la qualità delle mele con le nuove tecnologie di conservazione 58 Attività di sperimentazione su antonomo della fragola 64
Controllo biologico di Drosophila suzukii mediante rilasci del parassitoide Ganaspis brasiliensis 66
La maggiore età della Certificazione GLOBALG.A.P. 69
L’annata produttiva e fitosanitaria 2021 in viticoltura 72
Fitoplasmi della vite ed insetti vettori: attività di monitoraggio e sperimentazioni 74 Corsi patentini, sempre più online 77
Come modulare in cantina le peculiarità aromatiche del Sauvignon Blanc 79
La birra, caratteristiche, criticità e servizi offerti dal laboratorio di analisi della Fondazione Mach 81
Caratterizzazione aromatica del Distillato di Genziana: un prodotto Trentino marchiato IG 84
Il progetto Prati Primiero 86
Il bollettino fenologico delle specie prative: l’attività di monitoraggio sui prati trentini 90
Esperienze di maturazione controllata di letami bovini e caprini 94
Le api e l'ambiente: un equilibrio da monitorare 98
Monitoraggio della diffusione del bivalve alloctono Corbicula fluminalis nel Lago di Caldonazzo 101
Il burro di malga, prodotto sostenibile, tradizionale e dalla preziosa variabilità 103
Chimosina animale o genetica? Un metodo innovativo per identificarne l’origine 106
L-Teanina: l'analisi isotopica per la tutela di questo prezioso alleato della salute 109
Naturale formazione di Mepiquat nel cacao 111
115
Piattaforma servizi: messaggistica tecnica 116
I dati dei servizi e delle attività 118
Le aziende clienti 2021 122 Riconoscimenti 123
Pubblicazioni 2021 124
Articoli pubblicati su riviste scientifiche con fattore d’impatto 124 Articoli pubblicati su riviste tecnico-scientifiche e divulgative 138
Altre pubblicazioni, inclusi i contributi a convegni pubblicati 141
Monografie e capitoli di libro 145
Atti delle giornate tecniche 146
Prodotti editoriali 147
Pubblicazioni periodiche 147
Approfondimenti monografici del Centro Trasferimento Tecnologico della Fondazione Edmund Mach 148
Monografie 151 Eventi organizzati 2021 152 Formazione per adulti 153
Insegnamento 154
Tesi discusse nel 2021 156 Affiliazioni a società scientifiche/accademie 158
Partecipazione comitati e gruppi di lavoro 160
Il personale del CTT 2021 162
La Fondazione Edmund Mach 165
Sono da poco trascorsi trent’anni dalla prima applicazione dei “Protocolli d’intesa”, strumenti di autodisciplina promossi con grande lungimiranza dalla Provincia Autonoma di Trento e accolti con altrettanta consapevolezza dal sistema agricolo trentino, al fine di promuovere una agricoltura moderna al servizio del consumatore e dell’ambiente. Si trattava all’epoca di strumenti fortemente innovativi che hanno fatto del sistema agricolo trentino un precursore nel comprendere il bisogno di dar vita ad un percorso di “sviluppo sostenibile” che coniugasse la sostenibilità economica delle imprese agricole con l’esigenza di salvaguardare la salute umana e il valore rappresentato dal nostro territorio. Un percorso perlappunto, non un traguardo definitivo costituito da uno specifico set di pratiche colturali, piuttosto una direzione verso obiettivi sempre più ambiziosi seguendo, o meglio anticipando, le dinamiche socio-economiche che investivano il mondo agricolo.
Un percorso che è stato possibile grazie all’attività di un servizio di consulenza strutturalmente e funzionalmente immerso in un contesto di innovazione tecnica, dal quale ha potuto attingere la conoscenza necessaria per comprendere l’evoluzione dei fenomeni che hanno investito l’agricoltura trentina, e dotarsi degli strumenti tecnici più idonei per fronteggiare le nuove sfide in un’ottica di sostenibilità.
È in questo contesto che nasce anche la 13a edizione del Rapporto del Centro di Trasferimento Tecnologico volta a far conoscere le attività più significative svolte nell’annata di riferimento, frutto dell’interazione sinergica fra il personale impegnato nella consulenza tecnica e i tecnologi-sperimentatori.
Essendo obbiettivo del Centro l’individuazione, la validazione e il trasferimento dell’innovazione tecnologica finalizzata ad elevare il grado di sostenibilità delle nostre produzioni, è stato evidenziato, anche in questa edizione, in appositi riquadri il contributo dell’attività rendicontata nel perseguimento della sostenibilità; una sorta di piccole tessere di un grande mosaico che si estende alle nuove impegnative sfide che attendono il mondo agricolo. Cambiamenti climatici, organismi invasivi, limitazioni legislative, dovranno essere affrontati in un contesto sfavorevole di costi di produzione crescenti. L’attività che qui viene rappresentata è una testimonianza tangibile delle professionalità e delle competenze presenti nel Centro di Trasferimento Tecnologico, sulle quali l’agricoltura trentina potrà contare per proseguire, anche nel prossimo futuro, su quel virtuoso percorso intrapreso trent’anni orsono.
Claudio Ioriatti Dirigente del Centro Trasferimento Tecnologico Fondazione Edmund MachGuida alla lettura
Accanto a questo simbolo gli autori mettono in evidenza come i risultati degli studi e delle sperimentazioni condotte contribuiscono nel concreto al miglioramento della sostenibilità, dal punto di vista ambientale, economico, sociale.
Nel 2021 è stata attivata la modalità Formazione a distanza (FAD) per l’erogazione dei corsi di formazione per le abilitazioni per acquisto e uso/vendita dei prodotti fitosanitari e consulenza (patentino), attraverso l’implementazione di una piattaforma e-learning dedicata, che ha permesso la partecipazione di oltre 3.400 utenti. I corsi comprendevano anche il completamento del percorso formativo a crediti, gestito da FEM per il comparto frutticolo e viticolo trentino. Anche i corsi di aggiornamento per gli agricoltori su tematiche inerenti la Produzione Integrata che hanno dato origine ai crediti formativi, validi per il rinnovo del patentino, sono stati svolti per la prima volta in modalità videoconferenza, per circa 2.800 partecipanti.
Sempre per quanto riguarda la formazione e informazione si citano le produzioni editoriali (5 approfondimenti monografici, 9 Notiziari Fondazione Mach Notizie) e le attività di comunicazione tecnica per agricoltori con ulteriore incremento delle attività on-line mediante video-approfondimenti e video-conferenze ed eventi in streaming. Abbiamo gestito la comunicazione attraverso la piattaforma servizi messaggistica tecnica ed e-commerce (per corsi di formazione, servizi web, consulenza, distribuzione di libri) di cui disponiamo. Sono state rilasciate interviste radio-televisive e abbiamo partecipato a rubriche televisive su argomenti tecnico-divulgativi.
Il personale del Centro collabora con il Centro Istruzione e Formazio-

ne FEM e con il Centro Agricoltura Alimenti Ambiente dell’Università di Trento nella gestione dei corsi sia per studenti dell’istruzione secondaria, per il primo insediamento di imprenditori agricoli, che nell’ambito della formazione universitaria, affiancando i docenti incaricati o assumendo direttamente la responsabilità della docenza. Il personale del CTT è stato impegnato nei corsi universitari fornendo 380 ore di didattica e 110 di supporto alla didattica 1.030 svolte nei diversi corsi di indirizzo: tecnico, formazione professionale, brevetto imprenditore e formazione superiore verde e bevande per il Centro Istruzione e Formazione.
Per quanto riguarda i servizi analitici, diagnostici e di sorveglianza sanitaria, in termini generali questi servizi si contraddistinguono per l’elevato contenuto di innovazione potendo contare su strumentazione all’avanguardia e su conoscenze scientifiche di prima mano, spesso frutto della sperimentazione interna. I servizi analitici (chimici e microbiologici) offerti sono per lo più prodotti nell’ambito di processi già accreditati, mentre per quelli diagnostici fitopatologici il processo di accreditamento (ACCREDIA), iniziato nel corso del 2020, è stato raggiunto a ottobre
2021. Entro la scadenza dell’aprile 2022, indicata come data ultima dal Reg EU 2017/625, è prevista l’ulteriore implementazione dell’analisi di patogeni di specifico interesse per il settore agricolo della PAT al fine di essere riconosciuti come laboratorio ufficiale per il Servizio fitosanitario nazionale. Nel 2021 si è registrato un significativo incremento della domanda relativa alle analisi sulla biodiversità (micro e macro invertebrati) dei suoli, all’individuazione degli ecotipi di ape e alla melissopalinologia.
Sono proseguite e implementate circa una cinquantina di specie le attività di monitoraggio sugli organismi nocivi di quarantena e non, di interesse agrario e forestale, condotte su incarico dell’Ufficio fitosanitario provinciale. Nel 2021 particolare impegno è stato dedicato nel gestire alcune emergenze quali il colpo di fuoco, gli scopazzi su melo e la flavescenza dorata su vite e nel collaborare con il Servizio foreste della PAT per il monitoraggio del bostrico tipografo nelle foreste martoriate dalla tempesta VAIA. Si è partecipato attivamente all’elaborazione del PEAP 2021-2027 (Piano energetico-ambientale provinciale) in collaborazione con APRIE, UniTN e FBK. È in corso un approfondimento per la valutazione del potenziale di

produzione di biometano in Trentino al fine dell’immissione nella rete di distribuzione nonché strategie di chiusura della filiera agro alimentare e zootecnica attraverso lo sfruttamento degli scarti per produzione di biogas in impianti di trattamento. Sono proseguiti i confronti con APPA e APRIE sui temi trattati nel PEAP ed ulteriormente sviluppati nell’approfondimento elaborato nel corso del 2020 per conto di UNITN. Abbiamo collaborato alla definizione della conseguente attività di indagine sui possibili scenari impiantistici realizzabili presso specifici contesti territoriali. Abbiamo partecipato attivamente agli accordi di programma promossi da APPA circa la gestione dei fitofarmaci nelle acque: obbiettivo comune è attuare misure di gestione sostenibile al fine di ottenere un miglioramento dello stato qualitativo dei corpi idrici riducendo l’impatto derivato dall’attività agricola. In particolare, si è proceduto ad individuare sostanze impattanti sull’ecosistema acquatico di principi attivi utilizzati in produzione integrata, organizzare momenti di confronto e azione con vari attori della provincia di BZ relativamente ai corsi idrici di rilevanza sovra-provinciale e attivare un dottorato di ricer-

ca su nuovi campionatori di residui di pp.aa per il campionamento dei corsi di acqua.
Abbiamo partecipato alle riunioni del Tavolo di Lavoro ‘Gestione sostenibile degli effluenti zootecnici’, promosso da APPA per l’attuazione di misure per una gestione sostenibile degli effluenti zootecnici al fine di ottenere un miglioramento dello stato qualitativo dei corpi idrici riducendo il possibile impatto derivato dall’attività zootecnica.
Per quanto riguarda la foraggicoltura, abbiamo predisposto un programma di lavoro articolato su 11 azioni specifiche, che mira a valorizzare la produzione e l’utilizzo di risorse foraggere locali, garantire una maggiore territorialità e tipicità delle produzioni e ad incrementare la sostenibilità del sistema foraggero zootecnico trentino. Abbiamo inoltre dato il contributo alla definizione dell’allineamento tecnico-operativo FEM-PAT analizzando le criticità del settore foraggero-zootecnico trentino attraverso l’individuazione delle cause all’origine di specifici problemi e delle possibili soluzioni da mettere in atto per raggiungere determinati obiettivi.
Il CTT prosegue la gestione delle oltre 100 stazioni agrometeorologiche
della rete su tutto il territorio provinciale, con la relativa archiviazione e diffusione di dati su sito web e App e la gestione del sistema di allerta per le gelate primaverili con circa 2.000 utenti che usufruiscono del servizio e quasi 140.000 sms inviati nel 2021, annata da considerarsi straordinaria per il numero di notti di gelo e le temperature raggiunti. È stato fornito il servizio di consulenza tecnica di base agli agricoltori operanti nei principali settori: frutticoltura (melo, ciliegio, piccoli frutti), viticoltura, olivicoltura, zootecnia (bovini e caprini) e acquacoltura, a seguito di sottoscrizione di specifiche convenzioni con i principali consorzi rappresentativi dei singoli settori (APOT, CONCAST, ASTRO, Cantine diverse cooperative e private) e per singole aziende.
La consulenza tecnica in viticoltura ha interessato circa 1.500 ha e si è concretizzata attraverso l’emissione di 40 avvisi tecnici di difesa integrata, 4 incontri con i soci delle cantine aderenti al servizio, 10 incontri con i tecnici delle cantine, l’esecuzione del monitoraggio per la Flavescenza dorata su circa 300 ha e quello per le principali fitopatie (peronospora, black rot, mal dell’esca, ecc.) a campione su tutto il territorio provinciale.
La consulenza in frutticoltura ha interessato tutti i soci di APOT e altre realtà come AFLOVIT, CIO e agricoltori privati, per le colture di melo, drupacee e piccoli frutti fornendo informazioni tecniche tramite diverse modalità: incontri di gruppo, avvisi tecnici, video-tutorial, incontri personali, visite in campo, ecc. Alla base dell’elaborazione del consiglio tecnico c’è una intensa e puntuale attività di monitoraggio del territorio al fine di verificare la presenza di fitopatie in relazione allo stato fenologico delle colture. Tutte queste informazioni sono raccolte e archiviate tramite una applicazione per smartphone all’uopo predisposta che consente anche l’immediata condivisione delle osservazioni con tecnici e sperimentatori del CTT. Sono stati eseguiti anche dei controlli mirati per aree
destinate a produzione per l'export in paesi asiatici.
In taluni settori, quali quelli della produzione biologica, dell’enologia e della conservazione della frutta è stata offerta anche una consulenza specialistica, basata su attività dimostrative di campo ed analitiche in laboratorio volte a trovare soluzioni tecnologiche a specifiche problematiche di processo. Per i settori minori quali l’orticoltura, i cereali da panificazione, l’apicoltura e l’olivicoltura si è mantenuto un servizio di consulenza gratuito. Relativamente al settore zootecnico è stata fornita consulenza tecnica agli allevatori sui temi della consulenza economica e monitoraggio dei bilanci aziendali, foraggicoltura, costruzioni, cerealicoltura, alimentazione, gestione del latte, veterinaria e benessere animale e consulenza per gli ovi-caprini. Il servizio è rivolto a tutte le aziende zootecniche trentine che ne fanno richiesta (singolarmente o in forma associata - es. caseifici sociali), ai proprietari e ai gestori degli alpeggi presenti sul territorio provinciale. I contenuti dell’attività di consulenza, aggiornamento e approfondimento tecnico vengono definiti e aggiornati in accordo con il Servizio Agricoltura, il Servizio Politiche e Sviluppo Rurale e l’Agenzia Provinciale per i Pagamenti in Agricoltura nell’ambito di incontri di allineamento tecnico-operativo tra FEM e PAT.
Nell’ambito della tecnologia della trasformazione e caratterizzazione compositiva, è proseguita e si è in parte ampliata l’attività di consulenza enologica per le piccole e medie aziende trentine e quella relativa alla trasformazione lattiero-casearia delle produzioni di malga. Per questo settore, le attività di supporto ai produttori sono continuate con la consulenza ai produttori di malga e con il supporto tecnico ed organizzativo del concorso di formaggi di malga della Valsugana, in collaborazione con la Fondazione de Bellat e la CCIAA di Trento; quest’attività ha contribuito anche la realizzazione di una caratterizzazione microbiologica e chimica di alcuni prodotti montani.
Sono continuate le attività di supporto alla produzione territoriale del comparto ortofrutticolo nella determinazione della data di raccolta e delle condizioni ottime per massimizzare la qualità dei frutti in conservazione, entrambe su base varietale e zonale. Nel settore della gestione dei reflui e delle biomasse, è stata fornita consulenza specialistica e tecnica su incarico/convenzione agli impianti provinciali/regionali di trattamento dei rifiuti organici ed effluenti zootecnici, effettuando una valutazione qualitativa dei processi biologici condotti e dei prodotti ottenuti (valutazioni biologiche, chimiche, agronomiche e ambientali). Sono stati redatti o aggiornati i PUA per gli impianti a biogas agricoli. È stata fornita consulenza scientifica su progetto Upfield -HTC, finanziato con L.6/99, svolgendo attività sperimentale in laboratorio e in serra. È stato realizzato uno studio per la verifica della degradazione delle bioplastiche durante il compostaggio per conto di NOVAMONT SpA. Sulla base della convenzione con Istituto Tutela Grappa e Consorzio Vini è stato svolto uno studio di fattibilità per l’individuazione di soluzioni tecniche e tecnologiche idonee per la gestione e la valorizzazione degli scarti organici che residuano sul territorio trentino dalle cantine che effettuano la trasformazione dell’uva e dalle distillerie che lavorano le vinacce. Su incarico del Comune di Ledro è stato effettuato uno studio di fattibilità per la gestione dei reflui zootecnici. Si è proceduto all’adeguamento e collaudo del nuovo pilota (compostaggio e digestione anaerobica) a umido con test di funzionamento a freddo e a caldo.
Crescente è stata anche l’attività di consulenza per amministrazioni pubbliche e privati cittadini rispetto alla gestione del verde urbano, delle alberate e del relativo rischio di schianto o deperimento per presenza di fitopatologie o di altri fattori antropici o del cambiamento del clima. Per quanto riguarda la consulenza per le certificazioni di prodotto e di sistema, sono stati svolti gli audit
interni nelle aziende associate di O.P. Melinda, La Trentina, Società Frutticoltori Trento (SFT), Sant’Orsola ed altre realtà non inserite nel contesto cooperativo operanti nel sistema frutticolo trentino per il mantenimento della certificazione GLOBALG.A.P. e dei suoi moduli aggiuntivi GLOBALG.A.P. Risk Assessment on Social Practice (GRASP = Welfare) e Farm Sustainability Assessment (GGFSA = sostenibilità). Su richiesta delle principali Organizzazioni di Produttori sono stati eseguiti ulteriori audit in relazione a quanto richiesto dalla Grande Distribuzione Organizzata (Coop Italia e Conad). In quest’ambito è anche continuata l’attività di verifica documentale ed analitica dei protocolli di difesa integrata del melo. Su richiesta di APOT sono stati elaborati e revisionati circa 300 Documenti di Valutazione dei Rischi, compresa l’integrazione rischio biologico da Sars Cov 2. Per quanto riguarda il “trasferimento dell’innovazione”, abbiamo partecipato a diversi PEI (Partenariati Europei per l’Innovazione) attivati sui fondi PSR della provincia di Trento, della provincia di Bolzano e delle regioni Lombardia, Friuli ed Emilia Romagna. Le attività svolte riguardavano la validazione in campo di tecnologie e strategie di coltivazione volte all’incremento della qualità delle produzioni salvaguardando il patrimonio ambientale. A titolo di esempio, ricordiamo la valorizzazione della polvere di siero di latte in ambito fitoiatrico, lo studio di tecnologie a basso impatto sia aziendali che consortili per la prevenzione dell’inquinamento puntiforme e diffuso di prodotti fitosanitari, la comparazione di diverse tecnologie per la difesa attiva dalle gelate primaverili, la messa a punto di strategie per il recupero della fertilità di suoli degradati mediante fitorimedio, la mitigazione della deriva da fitofarmaci e la determinazione delle perdite di efficacia del rame sulla vegetazione della vite. È stato infine sperimentato un prototipo di macchina per diradamento meccanico.
Nell’ambito della sperimentazione agronomica, l’obbiettivo generale
delle attività è l’incremento della sostenibilità delle produzioni agricole. Per poter agire nella giusta direzione è innanzitutto necessario conoscere limiti e potenzialità delle attuali modalità di coltivazione, attraverso monitoraggi territoriali (biologici e chimici) che mettano in evidenza gli effetti diretti e collaterali della produzione agricola. Dall’attività di monitoraggio è emersa anche la presenza di nuovi organismi dannosi come alcune virosi del ciliegio, una nuova forma di ticchiolatura del melo (Venturia asperata), o la rinnovata dannosità dell’antonomo della fragola, verso le cui avversità sono state studiate delle modalità di controllo e gestione compatibili con la redditività della coltura. Sono continuate le osservazioni sull’efficacia delle irrigazioni sottochioma per la riduzione del volo di ascospore di ticchiolatura e conseguente riduzione della gravità delle infezioni. In taluni casi l’attività di sperimentazione è stata indirizzata alla validazione in campo od in azienda di nuove modalità di produzione o di soluzioni tecnologiche innovative propedeutiche al trasferimento nel contesto produttivo. Si sono messe a punto le tecniche agronomiche per la gestione delle nuove varietà di melo, è stata condotta la valutazione tecnico
economica delle nuove forme di allevamento del melo (multiasse, guyot) per diverse varietà e combinazioni di densità e sono state messe a dimora nelle aziende di Termon e Maso delle Part le nuove varietà APOT su portinnesti resistenti ad avversità biotiche e abiotiche. è proseguita l’attività iniziata nel 2020 per la valutazione delle cause e potenziali rimedi per la gestione in campo e durante la conservazione della patina bianca. Sono state realizzate altresì sperimentazioni mirate a valutare gli effetti durante la conservazione delle ferite sul frutto nella comparsa delle sintomatologie associate al riscaldo superficiale e del potenziale utilizzo in campo di inibitori della maturazione volti a modulare la data di raccolta. Tali attività spesso vengono condotte nell’ambito di convenzioni con aziende private, sia quali fornitrici dell’innovazione sia in quanto interessate alla validazione della proposta tecnologica nella propria azienda. È il caso delle alternative meccaniche al diserbo chimico, in particolare per evitare l’uso del glifosate, l’effetto degli ammendanti sulla fertilità del suolo, l’efficacia di bioprodotti in alternativa ai fitofarmaci di sintesi per il controllo dello scafoideo della vite, dell’eriosoma del melo e della cimice asiatica.

Sono state condotte esperienze di strategie di difesa dalle malattie fungine volte a ridurre la presenza di residui alla raccolta. In attesa dello stabilizzarsi dell’equilibrio ecologico fra i fitofagi e i loro antagonisti, è stata verificata l’efficacia di strategie di difesa che combinavano il controllo della cimice asiatica con quello di altri fitofagi emergenti e non. È continuata l’attività di selezione clonale e sanitaria della vite, la validazione in campo e in cantina delle principali cultivar di viti resistenti agli oomiceti patogeni, la messa a punto di schede agronomiche per la coltivazione e conservazione delle nuove varietà di fragola e di mirtillo. Su mirtillo è proseguita la sperimentazione per verificare l’adattabilità alla coltivazione fuori suolo (contenitori, soluzioni nutritive), le ottimali modalità di potatura e le potenzialità produttiva. È proseguita la valutazione di portinnesti, forme di allevamento e varietà di ciliegio, studiandone la suscettibilità alle gelate, verificando l’efficacia dei sistemi di protezione attivi dal gelo e valutando il miglioramento qualitativo determinato dall’impiego di fitoregolatori dall’implementazione del diradamento manuale e dall’uso di concimi fogliari. Relativamente all’albicocco, sono continuate le valutazioni varietali in diversi ambienti di coltivazione ed è stato studiato il fenomeno del recovery da ESFY realizzando un nuovo impianto ottenuto da materiale recovery. Sono state intraprese sperimentazioni enologiche su alcune nuove tecniche e tecnologie recentemente approvate dall’Organizzazione Internazionale della Vite e del Vino con l’obiettivo di anticipare le potenziali ricadute a livello tecnologico, prima dell’approvazione definitiva da parte della Commissione Europea. L’approccio sperimentale e semi-industriale realizzato assieme alla capillarità delle attività del Centro (consulenza enologica, collaborazioni industriali sperimentali, laboratorio di analisi, giornate tecniche) potrà garantire una efficace disseminazione dei risultati.
Si è fornito supporto alla individuazione delle varietà di asparago da coltivare, epoche e tecniche di difesa fitosanitaria finalizzata all’ottimizzazione della produzione in funzione della correlazione temperatura-terreno-crescita.
In materia di suolo è stata attivata una collaborazione con Università della Campania per valutazione del carbon footprint in relazione a diverse gestioni del vigneto, è stata effettuata una valutazione delle frazioni della sostanza organica in suoli viticoli a diversa gestione agronomica, sono continuate le valutazioni sulla fertilità chimica e biologica del suolo e sulla dinamica dell’azoto minerale confrontando frutteti e vigneti in conduzione integrata con altri in condizione biologica, sono state fatte delle valutazioni agronomiche sugli ammendanti (digestato e letame) somministrati al meleto, confrontando mediante lisimetri le perdite di nutrienti con quelle realizzate in un meleto fertilizzato chimicamente. È stato attivato un monitoraggio dell’azoto minerale prontamente disponibile in un centinaio di frutteti trentini al fine di meglio indirizzare il consiglio tecnico relativo ai fabbisogni nutrizionali del melo in primavera. Si è approfondito l’uso agronomico del digestato sui prati permanenti, attraverso un’analisi dell’intero ciclo dei nutrienti (refluo-vegetazione-suolo). In collaborazione con Libera Università di Bolzano sono state eseguite analisi delle emissioni di CO2, CH4, NH3, N2O da suoli ammendanti con digestato e letame. È stato messo a punto un Indicatore di sostenibilità economica (IST Latte) per il settore zootecnico validando bilanci triennali ed elaborando i dati per la produzione di indici di costo su 80 aziende individuate come campione. Per quanto riguarda la difesa delle colture, nel corso del 2021 è proseguito il progetto “Lotta Biologica” finalizzato all’implementazione del controllo biologico classico per la cimice asiatica e per la Drosophila suzukii. I risultati sono ancora preliminari, ma già molto incoraggianti in quanto possiamo affermare fin d’ora che a
seguito dei rilasci il parassitoide oofago T. japonicus si è insediato in gran parte degli ambienti oggetto dei lanci ed è sopravvissuto al primo inverno. Nel caso della drosofila, è continuata l’attività di monitoraggio delle popolazioni, rilevando l’entità del danno sulle produzioni e la diffusione dei due parassitoidi alloctoni, Leptopilina japonica riscontrata in Europa nel 2019 e Ganaspis brasiliensis rilasciato per la prima volta in Italia nell’agosto del corrente anno.
Nell’ambito della trasformazione e caratterizzazione compositiva, sono stati attivati studi sulla variabilità qualitativa chimica e microbiologica enologicamente inducibile dei vini attraverso l’utilizzo di coadiuvanti enologici e delle variabili di processo, nonché studi preliminari sulla qualità microbiologica di prodotti lattiero-caseari. È stato attivato uno studio finalizzato alla tracciabilità della vanillina ed etilvanillina che mira a definire su diversi fronti (aroma di legno nei vini, di vanigliato in budini e creme, estratti per cucina, ecc.), la composizione e origine naturale di questi composti che sono tra gli additivi alimentari più costosi e utilizzati a livello internazionale. Nel settore della conservazione dei prodotti carnei si sono sviluppati metodi per la caratterizzazione dei
conservanti da prodotti vegetali e l’impatto sulla formazione di nitriti e nitrosamine. Nel settore dei coadiuvanti alimentari prosegue l’attività di tracciabilità dell’origine dei formaggi grana e dei coadiuvanti a base di chitosano impiegati negli alimenti e bevande. È proseguita l’attività sperimentale di valutazione di nuove varietà di vite enologica e caratterizzazione delle varietà tolleranti alle malattie fungine coltivate in trentino, ampliando la collaborazione con gli stakeholder (Unità di miglioramento genetico FEM CRI e Unità viticoltura CTT; Associazione Vivaisti Trentini) in termini di servizio, di indirizzo e di divulgazione dei risultati (territoriale, nazionale ed internazionale). L’attività pluriennale ha contribuito alla registrazione di 5 nuove varietà al catalogo nazionale della vite, nonché al finanziamento di un progetto competitivo internazionale H2020 (Susfood-CoreOrganic) volto alla valutazione delle potenzialità spumantistiche di alcune di queste varietà prodotte con protocolli biologici. In collaborazione con L’Agenzia provinciale per la protezione dell’ambiente, l’Università di Trento e i Consorzi frutticoli e vitivinicoli provinciali, si è attivato un’indagine che mira alla messa a punto di un nuovo sistema

strumentale di monitoraggio dei livelli di inquinamento chimico di origine agricola. Dopo Vaia è divenuta urgente una valutazione dei fenomeni di degradazione del legname abbattuto al suolo. Lo studio, avviato con un dottorato in collaborazione con UNI Campobasso e Calabria, mira a indagare i fenomeni di degradazione chimica e micotica del legno in bosco. Gli apoidei sono degli insetti chiave negli ecosistemi per il loro ruolo nell’impollinazione delle specie vegetali coltivate e naturali. Da alcuni decenni le api sono in grave crisi, a causa di una serie di fenomeni che contribuiscono a indebolire e decimare sia le popolazioni di ape da miele che gli altri apoidei. Grazie all’acquisizione di specifici finanziamenti su bandi competitivi, è stato possibile attivare studi sull’impatto dei diversi fattori alla base del declino delle api e degli apoidei, le modalità per contrastare l’impoverimento genetico delle colonie allevate e le tecniche di allevamento che rafforzino le colonie rispetto alla parassitizzazione dell’acaro Varroa destructor Nel corso del 2021 erano attivi 9 dottorati di ricerca tutti cofinanziati da agenzie esterne. Due studi riguardano il controllo delle specie aliene invasive che affliggono la frutticol -
tura trentina: la cimice asiatica e la Drosophila suzukii. Nel primo caso il programma intende migliorare l’efficacia dei sistemi di monitoraggio e lo sviluppo del controllo biologico tramite la tecnica dell’insetto sterile (collaborazione con Ospedale S. Chiara di Trento), nel secondo caso la ricerca riguarda la biologia delle riproduzione del dittero con particolare riferimento alla precedenza spermatica nelle femmine poliandriche e lo sviluppo di tecniche di controllo biologico (collaborazione con Università del Molise e Università di Pavia). Una terza borsa di dottorato ha come oggetto l’indagine su off-flavours solforati in vino. L’attività, sviluppata anche con il supporto di un progetto di dottorato cofinanziato FEM e in collaborazione con l’Università di Auckland (NZ), si prefigge di indagare la genesi e degradazione di prodotti solforati di grande impatto olfattivo negativo nei vini. In particolare, sono investigati i polisolfuri, che agiscono da “serbatoio” di acido solfidrico, composto altamente degradativo della qualità sensoriale durante l’invecchiamento. Due dottorati hanno come oggetto di studio il controllo diretto e indiretto delle infezioni di ticchiolatura del melo attraverso induzione di eiezione

precoce delle ascospore, lo sviluppo di una tecnologia per il monitoraggio da remoto del volo delle ascospore, lo studio dei ceppi genetici diffusi nel nostro territorio e la selezione di materiale vegetale resistente. Altri tre progetti di dottorato sono relativi a tematiche di interesse enologico ed in particolare il primo è uno studio che mira a comprendere l’incidenza sulla produzione dei tioli di enzimi presenti in formulati enologici e attivi nei lieviti e delle formulazioni nutrizionali per il lievito. Cerca inoltre di definirne la variabilità inducibile tecnologicamente in cantina nella produzione di vini rossi e rosati. Le attività di sperimentazione si inseriscono nella progettualità di un dottorato cofinanziato FEM/Oenobrands. Un secondo riguarda lo Spumante classico Trentino: dalla pedologia ai profili sensoriali. Col supporto finanziario di Cavit, prende avvio uno studio di dottorato finalizzato a integrare le informazioni di tipo pedologico, già raccolte nelle carte dei suoli viticoli provinciali (PICA), con la descrizione chimica fine e sensoriale dei vini. L’obiettivo è quello di comprendere la variabilità inducibile dalla gestione agronomica sull’espressione sensoriale degli spumanti classici del Trentino. In particolare, verranno monitorati i parametri fenologici, idrici, nutrizionali e vegeto-produttivi e i profili compositivi chimici che maggiormente impattano sulla caratterizzazione sensoriale e sulla shelf-life del vino. Infine, il terzo riguarda la qualità e salubrità dei vini. In collaborazione con l’Università di Palermo e numerose cantine italiane è stata approfondita l’ecologia di Brettanomyces sp. il principale lievito alterativo del vino. Sono stati indagati i più innovativi strumenti di contrasto (Chitosani, Ozono) in termini di efficienza e impatto con il vino grazie a tecnologie analitiche chimiche e microbiologiche avanzate. Un ultimo progetto di dottorato, attivato nel 2021 in collaborazione con il Centro di Sperimentazione Laimburg ha come obiettivo l’indagine del ruolo di Orientus ishidae (Matsumura, 1902)
(Hemiptera: Cicadellidae) nell’epidemiologia di Candidatus Phytoplasma mali, agente causale degli “Scopazzi del melo". Questa cicalina originaria dell’Asia è stata trovata recentemente positiva al fitoplasma agente causale della malattia degli Scopazzi. In particolare, O. ishidae nel 2020 ha prodotto per la prima volta preoccupanti infestazioni nei meleti della Valsugana che, come ha dimostrato un recente studio della FEM, provocano ingenti danni fogliari e diffusa filloptosi. Il progetto intende stabilire la capacità o meno di trasmettere il fitoplasma, definire il danno effettivo diretto causato dalle punture di Orientus ishidae e definire una strategia di difesa efficace, legata al contesto paesaggistico e gestionale.
Diversi settori del CTT collaborano a numerose attività di sperimentazione mettendo a disposizione competenze specifiche in progetti finanziati su bandi nazionali ed europei. Fra questi gli studi volti a intensificare in maniera sostenibile l’acquacoltura tramite la verifica delle potenzialità di nuovi ingredienti da inserire nella dieta dei salmonidi (SHUSHIN, GAIN), la verifica dell’efficacia nuovi bioprodotti a basso impatto per la gestione della peronospora (RELACS), impatto del cambiamento climatico nella filiera vitienologica nel bacino mediterraneo (MEDCLIV), la produzione di fertilizzanti da digestato via HTC (Upfield-HTC - L.6/99), lo studio della storia genetica della bovina di razza Rendena e degli abitanti della Val Rendena attraverso lo studio del loro DNA mitocondriale (RENDENAGEN), lo studio della biodiversità agraria e alimentare associata alle produzioni agricole di montagna, la sua conservazione in situ e la tutela del paesaggio agrario (BIOAGRIMONT - finanziamento MIPAF), attività sperimentale su co-compost da idrochar + digestato da FORSU (HYDRORG), lo sviluppo di un modello di rimboschimento da attivare in caso di tempesta e disastro che colpisce le foreste, per accelerare la ricrescita delle piante e la conseguente ricreazione dell’ecosistema (VAIA).
Fin dalla sua costituzione il Centro Trasferimento Tecnologico opera nei diversi comparti agro-forestali svolgendo attività di sperimentazione, di servizio e di consulenza finalizzata all’implementazione di processi produttivi sostenibili dal punto di vista economico, ambientale e sociale. In questo senso garantisce continuità, concretezza ed attualizzazione alla ricerca, promossa sul finire degli anni Ottanta, di armonizzazione e sinergia fra le diverse sensibilità ed interessi della comunità trentina sul tema dell’interazione fra agricoltura, ambiente e salute.
Nel settore viticolo, l’interesse per la riduzione degli input a rischio di impatto ambientale risale ai primi anni ‘90. Era infatti il 21 febbraio 1990, quando fu sottoscritto il primo pro -
tocollo di autodisciplina per la viticoltura integrata, promosso dall’Assessorato all’Agricoltura della Provincia di Trento. La gestione operativa veniva attuata dalle associazioni dei produttori e dalle cooperative di settore alle quali spettava l’onere di comminare le eventuali sanzioni, mentre alla Provincia Autonoma di Trento era attribuito l’onere di accertare il rispetto delle norme di autodisciplina previste dal disciplinare di produzione. Il disciplinare si prefiggeva la “ valorizzazione non solo del prodotto vino, ma anche dello stesso territorio di produzione nel rispetto dell’ambiente, del produttore e del consumatore” attraverso la riduzione generalizzata dell’impatto ambientale dell’attività viticola, ed in particolare dell’impiego di antiparassitari, e il riconosci -

Il trentennale percorso verso la sostenibilità della viticoltura trentinaCLAUDIO IORIATTI
mento di standard di viti-enologia biologica.
Le linee guida sulle quali si basava il disciplinare scaturivano dall’esperienza maturata nel ventennio precedente relativamente alla limitazione dell’impiego di fitofarmaci in agricoltura. Fermo restando la necessaria disponibilità degli operatori, il supporto all’iniziativa veniva assicurato dall’azione capillare della assistenza tecnica dell’Ente di Sviluppo dell’agricoltura Trentina (ESAT) e dall’attività di ricerca e sperimentazione condotte dall’Istituto Agrario e dalla Stazione Sperimentale Agraria e Forestale di San Michele all’Adige.
Nel corso degli anni le linee guida per la produzione integrata e l’articolazione del disciplinare si sono gradualmente modificate adattandosi alle mutate normative locali e nazionali. Dal 2016 il Consorzio Vini del Trentino, che raggruppa la maggior parte dei viticoltori trentini, ha aderito al sistema di qualità nazionale per la produzione integrata (SQNPI) e per conto dei propri soci viticoltori, si è fatto carico della verifica del rispetto dei requisiti di produzione integrata mediante un rigoroso piano di controllo. Nel 2021 erano oltre 5.500 i viticoltori certificati, aderenti a 16 cantine sociali e a 25 cantine private, che con i loro vigneti rappresentavano il 78% della superficie viticola trentina. Questa certificazione volontaria mira tutt’oggi in primis a ridurre al minimo la pressione dei trattamenti fitosanitari e a razionalizzare la fertilizzazione nel rispetto dei principi ecologici, economici e tossicologici secondo quanto previsto dalla Direttiva Europea 128/2009.
Nei trent’anni trascorsi dalle prime esperienze pionieristiche di produzione integrata possiamo senz’altro affermare che sono generalmente aumentate le pratiche virtuose volte a salvaguardare la salute individuale e collettiva, così come si è accresciuta la sensibilità dei produttori, unitamente a quella dei consumatori, nei confronti dell’impatto ambientale diversamente dovuto alle varie forme di attività agricola.
L’introduzione di innovazioni tecnologiche nelle strategie fitosanitarie, e le conseguenze del cambiamento climatico sulla biocenosi del vigneto, hanno comportato variazioni talvolta significative dell’importanza relativa delle avversità biotiche che insistono sulla viticoltura trentina. Talune di esse, di rilevanza primaria negli ultimi decenni del secolo scorso, si sono di gran lunga ridimensionate nel corso di questi tre ultimi decenni, per essere talora rimpiazzate da nuovi agenti patogeni e/o artropodi fitofagi, mentre altre, per una congerie di fattori climatico-ambientali e colturali, hanno assunto maggiore virulenza e reso il proprio controllo più difficile, anche per la mancanza di nuovi adeguati mezzi di contenimento. Analizzando nel dettaglio, per cinque importanti problematiche, quali le tignole, la cicalina verde, gli acari, la botrite e le malerbe, si sono realizzati concreti e significativi progressi nella direzione di un maggior livello di sostenibilità (Ioriatti et al. 2004 Redia 87:117-128; Ioriatti et al. 2008 Areawide Pest Management: Theory and Implementation: 208-225; Ioriatti e Lucchi 2016 J. Chem Ecol. 47(7):571-583). Le modifiche di strategia fitosanitaria che ne sono seguite hanno comportato in qualche caso l’insorgenza di nuovi problemi di ordine entomatico, dovuti a fitofagi considerati secondari, come le cocciniglie, che hanno richiesto un adattamento dei programmi di difesa integrata in parte tuttora in corso (Delaiti et al. 2015 L’Inf. Agr. 31:54-57; Cocco et al. 2021 J. Pest Sci. 94(2):153185) Del tutto nuovo, per contro, risulta il confronto con gli insetti esotici, polifagi, invasivi H. halys e D. suzukii (Ioriatti et al. 2015 J. Econ. Entomol. 108(3):1148-1155; Ioriatti et al. 2018 J. Econ. Entomol. 111(1):283292; Panizza et al. 2019 12a GTVV Atti delle GT:11) così come il rapporto con i limitati ritrovamenti di sintomi attribuibili a G. bidwellii (Mattedi et al 2022 L’Inf. Agr. 13:2-6). In tutti questi casi la situazione può positivamente dirsi nel complesso sotto controllo e per ora non desta problemi. Si è in -
vece fatta decisamente più difficile la gestione del mal dell’esca, della peronospora e soprattutto della FD, per il cui controllo integrato, efficace e sostenibile, rimangono ad oggi diversi ostacoli da superare (Lucin et al. 2021 Vite e Vino 3: 36-44; Bottura et al. 2021 L’Inf. Agr. 4:37-40; Gelmetti et al. 2020 Terra Trentina 65(3):55-57).
Il contesto appena descritto si è evoluto in parte sicuramente sulla spinta di considerazioni tecniche fondate sui principi della protezione integrata preconizzata dall’International Organization for Biological Control (IOBC) in parte sotto la pressione dell’opinione pubblica e della domanda di una viticoltura più rispettosa dell’ambiente e della salute della popolazione che vive in prossimità delle aree vitate. La viticoltura trentina, che per la sua stretta interconnessione con le zone abitate può essere a ben ragione definita una viticoltura urbanizzata, è stata fortemente condizionata nella sua evoluzione verso una “sostenibilità integrale” proprio dalla necessità di dover tener conto di queste componenti socio-economiche critiche. Essa ha dimostrato una non comune sensibilità verso le esigenze del mondo extra-agricolo, rappresentato non solo da residenti, ma anche dai numerosi turisti ospiti delle tante strutture recettive che hanno sede in Trentino. Si sono infatti introdotti ulteriori criteri di valutazione nella scelta dei fitofarmaci da utilizzare, in particolare relativamente all’impatto sulla salute umana, affidandosi a un rigoroso esame della documentazione scientifica condotto dall’Istituto Superiore della Sanità al fine di attribuire il livello rischio (basso, medio o alto) per la popolazione esposta. Il miglioramento delle modalità di distribuzione dei fitofarmaci, grazie allo sviluppo di tecnologie innovative che consentissero di ottimizzare dosi e volumi della miscela antiparassitaria in ragione dello sviluppo della chioma, ha senz’altro contribuito a ridurre i quantitativi di fitofarmaci impiegati e a mitigarne la deriva oltre il confine dell’appezzamento (Mescalchin et al, 2011 L’Inf. Agr. 67(21s):5-8).
Significativo è stato anche l’impegno per la promozione della “viticoltura biologica” che copre ormai oltre il 13,5% della superficie viticola provinciale. Un sistema di conduzione del vigneto il cui impegno verso la sostenibilità non si limita solo a una difesa fitosanitaria esente da prodotti organici di sintesi, ma che riguarda in primis un’opportuna regolazione della vigoria della pianta e una attenta gestione della fertilità del suolo, preservando la biodiversità edafica e favorendo l’accumulo di sostanza organica attraverso la pratica del sovescio (Mescalchin et al. 2014 L’enologo 50(5):75-80; Lucin e Gobber 2020 L’Inf. Agr. 34:46-49).
Nonostante questi positivi risultati, si ritiene che un ulteriore incremento della superficie a conduzione biologica sia molto difficile, in quanto dovrebbero essere interessati vigneti meno vocati, a causa del clima e delle condizioni del terreno più favorevoli alle infezioni da peronospora. L’ostacolo principale è, infatti, dovuto alla limitazione delle quantità di rame che possono essere utilizzate ogni anno e alla mancanza di alternative efficaci per combattere la peronospora.
Una potenziale soluzione potrebbe essere l’utilizzo di ibridi resistenti alla peronospora, già disponibili da anni, ma fino ad ora poco impiegati a causa delle limitazioni poste dalla normativa. Solo da poco se ne è autorizzato l’impiego in diverse regioni italiane anche a seguito dei buoni risultati ottenuti con le più recenti selezioni. In Trentino la superficie investita con ibridi resistenti è limitata a poco più di 100 ettari, ma anche grazie alla registrazione di nuove varietà ottenute dal programma di breeding della FEM, l’interesse dei viticoltori verso questa nuova opportunità è in decisa crescita (Bavaresco e Squeri 2022 BIO Web of Conferences 44:06001; Stefanini 2020 13a GTVV Atti delle GT:8-9). Una significativa riduzione dei pesticidi senza l’uso di varietà resistenti sembra molto difficile, in quanto benché siano allo studio prodotti e tecnologie in grado potenzialmente di essere alternative all’impiego del
rame per il controllo della peronospora, esse non saranno senz’altro disponibili a breve termine e comunque devono ancora dare completa dimostrazione della loro effettiva efficacia. L’altro grande problema fitosanitario che interessa la viticoltura e che ostacola un alto livello di sostenibilità sia nella conduzione biologica che integrata è rappresentato dalla gestione della più volte richiamata FD e in particolare il contenimento del suo principale insetto vettore, S. titanus. Una delle linee di ricerca più affascinanti e promettenti finalizzate al controllo di questo vettore (principale, ma non l’unico) è rappresentata dallo sviluppo di una tecnica di controllo basata sulla “confusione vibrazionale” (Nieri et al. 2022 Entomol. Gen. 42(2):167-183). L’ambito di funzionamento è analogo a quello della confusione sessuale per mezzo di sostanze feromonali, ma in questo caso l’accoppiamento è impedito, o meglio ostacolato, dalla produzione di segnali vibrazionali che interferiscono nella comunicazione intraspecifica tra maschi e femmine. L’emettitore può essere alimentato dalla rete fissa o, come nella nuova versione, da pannelli solari che lo rendono autonomo.
In conclusione, dall’esperienza di questi trent’anni di viticoltura integrata possiamo affermare che, se è stato possibile promuovere un maggior grado di sostenibilità, è altrettanto vero che ciò ha richiesto un costante monitoraggio e adattamento delle strategie
di difesa alle mutevoli condizioni climatiche e al cambiamento delle tecniche agronomiche. A tutt’oggi, nessuna soluzione è da considerarsi definitiva. Alcuni problemi si ripresentano dopo anni e risultano costituiti dal ritorno a livelli di significatività economica da parte di avversità biotiche “secondarie” e/o non più controllate da prodotti fitoiatrici selettivi. Altri derivano dalla presenza nelle aree viticole trentine di nuovi fitofagi alieni invasivi che richiedono o possono richiedere almeno localmente trattamenti insetticidi aggiuntivi. Gli uni e gli altri, come del resto tutti quelli che afferiscono al complesso dei nemici della vite, risentano più o meno fortemente, per altro in parallelo alla vite stessa, dei cambiamenti climatici in atto. A tutto ciò si aggiunge, sul fronte delle dinamiche di scenario, la pressione sociale e il quadro delle nuove normative sempre più stringenti a tutela della salute umana, dei prodotti agro-alimentari e dell’ambiente in generale.
È pertanto di fondamentale importanza e cautela non dare per scontati e definitivi i risultati raggiunti e in attesa che la ricerca metta a disposizione nuovi strumenti e strategie per una gestione via via più sostenibile del vigneto, è indispensabile indirizzare la conduzione del suo agro-ecosistema tenendo presente che quanto maggiore sarà l’equilibrio vegeto-produttivo dell’impianto tanto più resiliente esso risulterà all’aggressione di vecchie e nuove avversità biotiche.

Le temperature nel 2021 mostrano molte analogie con quanto riscontrato nel 2019. Infatti, la primavera è stata fredda, mentre il caldissimo mese di giugno ha condizionato l’intera stagione viticola. La piovosità totale si è attestata su valori medi. Si riportano alcune curiosità sui dati registrati nel 2021: la giornata più fredda è stata l’11 gennaio, mentre la più calda il 21 giugno, e il 3 gennaio è stata quella più piovosa, con 83 mm di pioggia. L’anno è iniziato con gennaio che ha presentato una temperatura media di oltre 1 °C inferiore rispetto alla serie storica dei venti anni precedenti: da molto tempo non si registravano medie negative inferiori a zero. Febbraio è stato un mese “caldo”, con temperature ben superiori alla media di quasi 2 °C, trend che negli ultimi anni si conferma con costanza. Marzo ha visto temperature leggermente inferiori alla media con minime notturne spesso sottozero. Aprile è stato un mese freddo, così come maggio, entrambi con oltre 1 °C in meno rispetto alla corrispondente media. Nelle notti tra il 6 e 7 aprile, ma soprattutto tra il 7 e 8 aprile, le temperature minime a 50 cm da terra hanno toccato temperature fino a -6/-7 °C e con durata delle temperature inferiori a zero anche di 12 ore consecutive. Nonostante ciò, le
produzioni agricole hanno risentito meno delle gelate rispetto a quanto ci si poteva aspettare, a causa del ritardo fenologico e quindi della minor suscettibilità ai danni da gelo. Infatti, i meli erano in uno stadio precedente la fioritura, e la vite, nelle zone più precoci, era nella fase di gemma cotonosa. La coltura che ha risentito di più dei danni da freddo nel nostro territorio è stata il ciliegio. Giugno invece è stato il mese più caldo dell’anno, con temperatura di 3 °C superiore alla media. Un andamento simile tra aprile e giugno si era verificato nel 2019. A luglio le temperature sono state in media, mentre ad agosto inferiori, e quindi l’estate ha avuto un andamento altalenante, contraddistinta da frequenti variazioni di temperatura. A luglio sono stati frequenti gli episodi temporaleschi accompagnati da venti e intense grandinate su tutto il territorio provinciale; ad inizio e fine agosto si sono registrati fronti freddi di temperatura mentre, a cavallo del 15 agosto, si è verificata una settimana molto calda. Settembre è stato più caldo di oltre un grado rispetto alla media. Ottobre è stato più fresco e novembre leggermente più caldo rispetto alla media, così come dicembre.
Le piogge del 2021 sono state simili a quelle del 2019, anche se distribuite
in maniera diversa. L’inverno è stato piovoso con gennaio che ha registrato mediamente 170 mm di pioggia e febbraio 70 mm. Sommando anche dicembre 2020, siamo in presenza di uno degli inverni più piovosi. Marzo invece è stato secco, il che rappresenta un’altra anomalia rispetto alla normalità, che vede solitamente inverni secchi e primavere piovose. A marzo sono caduti meno di 10 mm di pioggia e anche ad aprile le piogge sono state meno abbondanti della media (50 mm). Maggio, assieme a luglio, è stato uno dei mesi più piovosi con 170 mm di pioggia caduta. Giugno ha visto poche precipitazioni, con 50 mm di pioggia concentrati nella prima settimana. Luglio è stato invece il mese più piovoso con quasi 200 mm di pioggia, altra anomalia climatica del 2021. In alcune

zone del Trentino a luglio si sono registrate quantità di pioggia che sfiorano i 400 mm. Ad agosto sono caduti circa 90 mm di pioggia concentrati quasi tutti nei primi 5 giorni. A settembre la pioggia caduta si è attestata sui 60 mm. Tra il 17 agosto e il 16 settembre, a parte un breve episodio, non è piovuto praticamente mai e questa fase ha favorito una gestione della vendemmia e della raccolta delle mele abbastanza tranquilla, anche se le premesse di inizio agosto non erano tali, anzi molta era la preoccupazione per la diffusa marcescenza dell’uva a causa delle continue piogge estive. Ad ottobre le piogge sono state inferiori alla media e a novembre superiori. Dicembre è stato un mese sostanzialmente secco, con un unico evento nevoso, l’8 dicembre.
2 Andamento della piovosità nel 2021 in confronto con la media 1983-2020
L’effetto del cambiamento climatico è assai evidente anche sullo sviluppo delle colture arboree più diffuse in Trentino e in particolar modo sul melo. La fioritura di questa coltura in Val d’Adige avviene mediamente nella prima decade di aprile con un anticipo di circa 10 giorni rispetto ai primi anni Ottanta. Con questo anticipo il melo si trova ad uno stadio sensibile alle gelate già da fine marzo e nei primi giorni di aprile, periodo in cui i ritorni di freddo sono assai probabili. La primavera 2021 è stata particolarmente anomala, con temperature oltre la media nell’ultima decade di marzo che hanno favorito lo sviluppo vegetativo in Val d'Adige. A partire dal 5 aprile un’importante ondata di freddo ha colpito l’Italia e il centro Europa con venti freddi provenienti da nord che, oltre ad abbassare di molto la temperatura, hanno contribuito a ridurre notevolmente l’umidità relativa dell’aria e ad asciugare ulteriormente un terreno già asciutto dalla carenza di precipitazioni nel mese di marzo.
In quei giorni la coltura del melo si trovava allo stadio di inizio fioritura in Valle dell’Adige, mentre nelle zone di collina si era allo stadio di bottoni rosa - mazzetti divaricati.
Nella notte tra il 6 e il 7 aprile, dopo una prima fase in cui un leggero vento ha mantenuto la temperatura di poco sopra lo 0 °C, si è verificata la
Figura 1
Temperatura a bulbo asciutto e bagnato nella notte dell’8 aprile 2021. Per diverse ore la temperatura è rimasta a circa -8 °C

prima gelata che ha visto le temperature arrivare a -3 °C in pochissimi minuti. Sono di conseguenza stati azionati gli impianti antibrina nei frutteti dotati di questo sistema. Durante la giornata del 7 aprile il vento da nord ha continuato a soffiare, apportando ulteriore aria fredda e determinando temperature diurne molto basse per il periodo. Nel corso della serata il vento si è calmato quasi ovunque già a partire dalle ore 19, con conseguente repentino calo termico, costante durante tutta la serata e la notte. Il cielo, completamente sereno, ha favorito il fenomeno dell’inversione termica contribuendo al costante calo della temperatura. All’alba dell’8 aprile, nelle zone tipicamente più fredde, la temperatura del termometro a bulbo bagnato a 50 cm è arrivata fino a - 8,5 °C (Fig. 1) e la temperatura asciutta rilevata a 2 metri di altezza ha segnato un minimo notevole, -5 °C. In tutti i frutteti con gli impianti antibrina l’attivazione è avvenuta mediamente alle ore 20 del 7 aprile continuando con l’aspersione fino alla mattina inoltrata. La gravità del fenomeno e la copertura nuvolosa avvenuta nelle prime ore del giorno ha condizionato la fase di spegnimento degli impianti che sono rimasti attivi fino alla tarda mattinata. Il rilevamento delle temperature delle stazioni agrometeo della Fondazione Mach anche nei frutteti “sotto antibrina” ha certificato la portata straordinaria dell’evento. Le temperature raggiunte sono risultate più rigide rispetto alle gelate del 2017, arrivando al limite della protezione dei sistemi antibrina, che notoriamente garantiscono la difesa ottimale con temperature fino a -6/-7 °C.
Nonostante l’abbondante copertura irrigua, nella zona di Mattarello-Romagnano le temperature nei frutteti irrigati è comunque scesa sottozero arrivando a -3 °C a 50 cm e a -1 °C a 2 metri di altezza. La temperatura così rigida ha determinato la formazione di molto ghiaccio opaco (Foto 2) se-
16
gnale che si sono congelate le più piccole particelle di acqua durante il tragitto verso la pianta, rendendo vana la produzione di calore che, come è noto, è l’effetto di difesa dal gelo. Infatti, in diverse situazioni, nei frutteti irrigati si sono successivamente evidenziati dei danni alle piante e ai fiori con bruciature della vegetazione soprattutto sulle file di bordo o dove gli irrigatori avevano una portata ridotta o un sesto troppo largo. L’evento di gelata del 6-8 aprile 2021 e l’entità dei danni rilevati nei giorni successivi dai tecnici FEM, hanno messo in evidenza ancora una volta l’efficacia della difesa antibrina sovrachioma e hanno confermato per il melo la scarsa efficacia di metodi alternativi (candele, irrigatori a ridotto consumo d’acqua, ecc.) che per ovvi motivi “fisici” non riescono a difendere le colture con temperature inferiori a -3/-4 °C. La Fondazione Mach è impegnata da anni nell’assistere gli agricoltori nella gestione di questa problematica.


1.800
1.071
90.701 melo e 46.312 ciliegio
Oltre 16.000
Vengono effettuati incontri formativi e ad inizio stagione viene divulgato un notiziario dedicato con le indicazioni per una corretta gestione degli impianti antibrina e la descrizione dei servizi digitali forniti da FEM. Durante le giornate di gelo vengono emesse, in collaborazione con Meteotrentino, delle previsioni specifiche che mirano a prevedere al meglio il fenomeno dell’inversione termica, causa principale delle gelate nel nostro territorio. Gli agricoltori possono monitorare costantemente l’andamento della la temperatura delle stazioni meteo di interesse, che viene aggiornata ogni 2 minuti e che è visualizzabile sul sito internet (https://meteo.fmach.it) o più facilmente sulla app “MeteoFEM”. Le diverse stazioni meteo inviano in automatico degli SMS di allarme agli agricoltori quando la temperatura scende sotto una determinata soglia che viene costantemente adattata dai tecnici della FEM a seconda della fase fenologica.
Foto 1 Impianti di irrigazione sovrachioma con funzione antibrina
Foto 2 Formazione del ghiaccio opaco sul fiore
La stagione vegetativa 2021 è stata precoce, leggermente in anticipo rispetto anche al 2020, già caratterizzata da un risveglio vegetativo anticipato. Questa è una tendenza che si osserva con maggior frequenza negli ultimi anni, come evidente dalla figura 1. L’anticipo vegetativo espone le piante a un maggior rischio di gelate tardive. Nel 2021 si sono avuti abbassamenti di temperatura nei primi giorni di aprile (fra il 6 e il 9) che hanno coinciso con l’inizio della fioritura del melo nelle zone precoci. Tuttavia, la difesa antibrina del fondovalle e la conformazione orografica delle zone di collina hanno contenuto i danni, che comunque sono stati osservati. Grazie alla buona allegagione, la percentuale di fiori sani rimasti in pianta ha permesso di avere una produzione discreta per la maggior parte delle varietà, come Golden D., mentre un
certo calo si è osservato solo per Red Delicious e Renetta Canada.

La primavera è stata caratterizzata da una pressione della ticchiolatura abbastanza contenuta, con una sola infezione prima della fioritura e voli ascosporici ridotti.
A partire dall’ultima settimana di aprile si sono verificati numerosi eventi piovosi che in diverse occasioni hanno determinato infezioni di ticchiolatura. In particolare, le infezioni del 1-2 maggio e quelle del 11-12 maggio sono state le più importanti della stagione. Per le altre patologie si segnalano qualche caso di oidio, per l’andamento abbastanza asciutto della prima parte della stagione e la diffusione di varietà più sensibili, e qualche episodio di colpo di fuoco in Val di Non, su impianti giovani, ed alcuni casi in Valsugana come conseguenza del forte attacco del 2020.
La problematica maggiore del 2021 è stata la recrudescenza di episodi di moria del melo che si è protratta anche in estate, osservati in alcune zone della Val di Non e della Valsugana, con presenza di frutteti anche fortemente colpiti. Per aumentare la conoscenza sulla diffusione e sull’entità del problema è stata organizzata un’indagine che ha coinvolto centinaia di produttori, in collaborazione con APOT.
La difesa verso i principali fitofagi del melo, come gli afidi cenerognolo e lanigero, è stata condotta senza particolari problemi, ed anche la pressione della cimice asiatica è stata minore rispetto al 2020. Sono continuati i lanci del parassitoide Trissolcus japonicus che ha manifestato una buona azione di parassitizzazione e un aumento della sua diffusione. Sono comunque stati necessari degli interventi insetticidi di contenimento in alcune aree frutticole quali il fondovalle, la bassa Val di Non e in alcuni frutteti di altre zone.
Fra gli insetti di recente comparsa su melo si ricorda la cicalina mosaico (Orienthus ishidae), vettore di fitoplasmi della vite, che è stata oggetto di indagine nel corso del 2021 attraverso il monitoraggio operato dai tecnici consulenti FEM-CTT. È inoltre in corso un progetto, supportato da APOT, per chiarire l’eventuale ruolo di questo insetto come vettore degli scopazzi, fitoplasmosi in aumento in alcune aree della provincia.
Per le altre specie frutticole l’annata è stata nella norma, con una leggera riduzione della produzione per il ciliegio, a causa dei danni da freddo in alcuni impianti e qualche danno da cimice in zone collinari. Si è osservata una certa recrudescenza di acari negli impianti coperti, mentre non si registrano grossi problemi dovuti a malattie fungine. Per fragola e piccoli frutti le produzioni sono state soddisfacenti; tuttavia, si segnalano alcune criticità come l’aumento di antonomo per la fragola e la presenza crescente di eriofide su mora.
Figura 1
Data di fioritura di Golden D. a Trento sud dal 1982 al 2021. In rosso sono segnalate le annate caratterizzate da gravi gelate primaverili
Lo studio delle comunità edafiche del suolo e la disponibilità di indici di qualità permettono di valutare e dimostrare come già dai primi anni dall’adozione di pratiche agricole più sostenibili ci sia un aumento della ricchezza del microbiota, rafforzando la sostenibilità e la resilienza del suolo nelle regioni storicamente agricole.
 EMANUELA COLLER
EMANUELA COLLER
RAFFAELLA
MORELLI SARA ZANONICLAUDIA
MARIA OLIVEIRA LONGA* MARCO IPPOLITOFRANCESCA CIUTTI
CRISTINA CAPPELLETTI
ROBERTO ZANZOTTI
DANIELE PRODORUTTI
* Centro Ricerca e InnovazioneFondazione Edmund Mach
The use of conservation and sustainable practices could restore the abundance and richness of soil organisms in agroecosystems. The aim of this study was to establish whether and how different living soil communities reacted to the conversion from integrated to organic orchard management. The metataxonomic approach was applied for fungi and bacteria and the determination of biological forms for diatoms and microarthropods. Our results showed that the different taxa reacted to the management changes at different speeds. Fungi responded quickly to the changes, suggesting that changes in agricultural practices have a greater impact on fungal communities. Bacteria and microarthropods were affected to a greater extent by abiotic parameters and to a lesser extent by management practices. Although the diatom composition showed seasonal fluctuations, the higher H’ (Shannon index) value in the organic system suggested that diatoms could have potential for monitoring changes in soil.
Nei sistemi agricoli, la frazione più rappresentativa della biodiversità è ospitata nel suolo. Essa è costituita
da un’ampia gamma di organismi coinvolti in numerosi processi ecologici. L’agricoltura intensiva, l’uso di
Come risponde il biota del suolo alla conversione di un frutteto integrato al biologico?
agrofarmaci, erbicidi e fertilizzanti minerali possono influenzare la qualità del suolo e la diversità biologica. Tuttavia, le pratiche sostenibili riducono l’impatto negativo sugli agroecosistemi, ripristinando l’ambiente e aumentando l’abbondanza e la ricchezza del microbiota del suolo. La sensibilità delle comunità edafiche ai cambiamenti ambientali e alle diverse pratiche agricole rende la loro caratterizzazione importante per definire la salute e la qualità dei suoli. All’interno del microbiota del suolo, funghi e batteri sono le componenti dominanti in grado di adattarsi alle condizioni ambientali, regolando la loro attività metabolica, la biomassa e la struttura della comunità. Un’altra componente biotica rilevante è quella dei microartropodi che, grazie alla loro capacità di rispondere agli stress, ai cambiamenti delle condizioni ambientali, alle proprietà del suolo e alle pratiche agronomiche, sono validi indicatori della salute del suolo. In tema di monitoraggio ecologico e valutazione della qualità dei suoli, recentemente sono state proposte, come indicatore di qualità, le comunità algali del suolo
ed in particolare le diatomee, le quali sembrano sensibili ai disturbi antropici e alle pratiche agronomiche.
Nel meleto a gestione integrata della Fondazione De Bellat (cv. Gala, loc. Spagolle), nella primavera 2018 è iniziato il monitoraggio del suolo (chimica e comunità viventi), pianta e frutti per valutare i cambiamenti che si verificano durante la fase di conversione a biologico. Il meleto è stato suddiviso in due parcelle: in una è continuata la gestione integrata (INT), mentre l’altra è stata convertita alla gestione biologica (BIO). Lo studio delle comunità (funghi, batteri, diatomee e microartropodi) ha previsto l’analisi della struttura, la determinazione dei generi più rappresentativi, degli indici di biodiversità e dell’indice di dissimilarità. I campionamenti sono stati fatti in tre momenti: a tempo zero (T0 - primavera 2018), dopo 6 mesi (T1) e dopo 18 mesi (T2).
In figura 1 sono riportati i risultati relativi alla struttura della comunità del suolo. La coltivazione frutticola
Figura 1
Distribuzione dei generi più rappresentativi di a) funghi, b) batteri, c) diatomee e d) microartropodi per le due parcelle BIO e INT nel tempo (T0, T1 e T2). Le lettere diverse tra le parentesi indicano differenze significative tra i tempi all’interno della stessa gestione (test di Wilcoxon con correzione BY, p-value=<0,05)
Tabella 1
Indici di biodiversità e qualità del suolo per funghi, batteri, diatomee e microartropodi per le parcelle BIO e INT ai tempi T0, T1 e T2. Lettere diverse tra le parentesi indicano differenze statisticamente significative (p≤0,05) tra tempi di campionamento per la stessa parcella
prolungata ha selezionato, per ogni comunità, dei generi caratteristici. Per i funghi sono stati analizzati 267 generi e tra quelli più rappresentativi sono presenti alcuni generi responsabili di malattie da reimpianto, marciumi radicali e cancri (es. Mortierella, Tetraclidium, Cylindrocarpon e Nectria). Per i batteri sono stati trovati 408 generi e i più frequenti sono risultati Nitrososphaera e Gp16. Risultati interessanti sono emersi dal rapporto tra due gruppi di batteri (P/A, P: Proteobatteri, A: Acidobatteri). Tale rapporto fornisce un’indicazione sulla disponibilità degli elementi nutritivi del suolo (valore limite: 0,5). Più il rapporto P/A risulta superiore a 0,5 e maggiore è la disponibilità degli elementi nutritivi. Nel nostro studio, i valori P/A della tesi INT sono rimasti costanti (T0: 0,77, T2: 0,78) mentre nella tesi BIO sono aumentati (T0: 0,78, T2: 0,82), suggerendo come questa pratica migliori la disponibilità delle risorse nutrizionali. Per le
diatomee, sono stati trovati 38 generi e un’alta variabilità tra i campioni. Il genere Mayamaea era maggiormente presente nella gestione BIO, mentre in INT vi era una variazione nel tempo di Hantzschia (diminuzione) e Nitzschia (incremento). Per gli artropodi sono stati analizzati 11.789 individui appartenenti a 16 taxa e i più abbondanti sono stati Acari, Collemboli ed Imenotteri adulti.
Gli indici di biodiversità analizzati (Tabella 1) sono: “S” (numero di taxa presenti), “S.Chao1” (numero assoluto di specie, in base al numero di specie rare), “J” (indice di uniformità/ evenness: grado di omogeneità della distribuzione dei singoli individui nelle varie specie della comunità), “H’” (indice di Shannon. Esso fa risaltare le specie rare poiché considera sia la ricchezza in specie sia la loro uniformità). Per gli artropodi, inoltre, sono stati considerati anche l’abbondanza
S 967 ± 21 994 ± 26 896 ± 45 902 ± 30 (b) 968 ± 27 (ab) 977 ± 47 (a)
S.Chao1 1722 ± 40 (a) 1696 ± 40 (ab) 1518 ± 77 (b) 1572 ± 52 1631 ± 43 1662 ± 73
H’ 4,5 ± 0,1 4,6 ± 0,1 4,3 ± 0,2 4,3 ± 0,1 (b) 4,5 ± 0,1 (ab) 4,6 ± 0,2 (a)
J 0,66 ± 0,01 0,66 ± 0,01 0,64 ± 0,02 0,64 ± 0,01 (b) 0,66 ± 0,01 (ab) 0,67 ± 0,02 (a)
S 5916 ± 92 (a) 5802 ± 162 (ab) 5463 ± 149 (b) 5991 ± 74 (a) 5863 ± 105 (ab) 5686 ± 103 (b)
S.Chao1 11784 ± 212 (a) 11385 ± 403 (ab) 10562 ± 34 (b) 11933 ± 180 11244 ± 26 11204 ± 253
H’ 7,33 ± 0,03 (a) 7,38 ± 0,04 (a) 7,16 ± 0,06 (b) 7,33 ± 0,05 (ab) 7,42 ± 0,04 (a) 7,28 ± 0,04 (b)
J 0,84 ± 0,00 (b) 0,85 ± 0,00 (a) 0,83 ± 0,01 (b) 0,84 ± 0,00 (b) 0,86 ± 0,00 (a) 0,84 ± 0,00 (b)
S 7 ± 2 6 ± 1 8 ± 2 5 ± 1 6 ± 1 6 ± 1 S.Chao1 7 ± 2 6 ± 1 8 ± 2 5 ± 1 7 ± 1 7 ± 1
H’ 1,20 ± 0,07 (a) 0,84 ± 0,05 (b) 1,12 ± 0,07 (a) 1,16 ± 0,03 (b) 1,1 ± 0,1 (ab) 1,31 ± 0,03 (a)
J 0,65 ± 0,05 0,50 ± 0,04 0,58 ± 0,06 0,73 ± 0,02 0,64 ± 0,07 0,71 ± 0,03
Abundance 9776 ± 4563 3503 ± 1041 3611 ± 415 9751 ± 3804 6643 ± 1719 7305 ± 1197 QBS 114 ± 10 (a) 76 ± 10 (b) 118 ± 10 (a) 127 ± 9 (ab) 116 ± 10 (b) 148 ± 9 (a) S 8,0 ± 0,7 (a) 6,0 ± 0,6 (b) 8,0 ± 0,5 (a) 8,7 ± 0,7 (ab) 7,5 ± 0,5 (b) 9,9 ± 0,5 (a)
S.Chao1 11 ± 2 7 ± 1 10 ± 1 10 ± 1 11 ± 2 11 ± 1 H’ 1,3 ± 0,1 (ab) 0,9 ± 0,2 (b) 1,4 ± 0,1 (a) 1,4 ± 0,1 1,1 ± 0,1 1,4 ± 0,1 J 0,62 ± 0,07 0,53 ± 0,06 0,65 ± 0,03 0,66 ± 0,06 0,57 ± 0,05 0,63 ± 0,04
e l’indice di qualità biologica del suolo “QBS”. Quest’ultimo si basa sulla capacità dei vari taxa di resistere agli stress in funzione del loro grado di adattamento alla vita nel suolo. Maggiore è il grado di adattamento e minore è la loro capacità di abbandonare il suolo in condizioni sfavorevoli, di conseguenza, la presenza/assenza degli organismi più adattati è indicativa del livello di disturbo del suolo. Per i funghi, al T0 si partiva da una situazione simile tra le due parcelle. Nel tempo, i valori degli indici del BIO sono incrementati e al T2 le differenze tra le due gestioni sono risultate significative. Per i batteri e gli artropodi, invece, non sono state riscontrate differenze tra le due gestioni, mentre sono state evidenziate differenze tra tempi di campionamento (tra T0 - primavera e gli altri due momenti - autunno). Per quanto riguarda le diatomee, gli indici di biodiversità sono incrementati nel tempo e al T2 sono risultati significativamente maggiori in BIO.
L’indice di dissimilarità o indice di “Bray-Curtis” (Fig. 2) quantifica la differenza a livello di composizione della comunità tra le due gestioni nel corso del tempo. Può assumere valori tra 0 (i due campioni hanno la stessa composizione) e 1 (i campioni sono totalmente dissimili).
Per la comunità fungina, tra integrato e biologico il valore dell’indice di Bray-Curtis è aumentato significa-
tivamente nel tempo. La comunità batterica aveva mostrato valori di dissimilarità più bassi rispetto a quella dei funghi, mentre per gli artropodi l’indice aveva valori maggiori e più dispersi. In entrambe queste comunità la differenza tra T0 e gli altri due tempi era risultata significativa. Le diatomee, come i microartropodi, avevano grande dispersione dei valori, ma non risultavano differenti tra le annate.
Il monitoraggio ha evidenziato come la comunità fungina ha reagito prontamente al cambiamento di gestione ed i valori degli indici di biodiversità nella parcella biologica sono aumentati rispetto a quelli della gestione integrata. La comunità batterica e quella dei microartropodi, invece, sono state influenzate più dalla stagione che dalle pratiche agricole. Le diatomee si sono rivelate promettenti per il monitoraggio dei cambiamenti nel suolo. Questo studio ha dimostrato come, nel breve periodo dal cambio di gestione, le componenti della comunità del suolo rispondono in modo diverso. Il lavoro è ancora in corso allo scopo di caratterizzare il cambiamento del microbiota del suolo anche nel lungo periodo dal cambio di gestione. Lo studio “Soil Communities: who responds and how quickly to a change in agricultural system?” è stato pubblicato su Sustainability (Coller et al. 2021 Sustainability 14(1),383).
Figura 2
Indice di dissimilarità (Bray-Curtis) per funghi, batteri, diatomee e microartropodi tra le due parcelle (INT e BIO) nel tempo (T0, T1 e T2). In alto, le lettere diverse indicano differenze significative tra i tempi nel confronto biologico-integrato per ogni comunità (test di Wilcoxon con correzione BY, p-value=<0,05)
La sostanza organica del suolo è una riserva di carbonio e una sua attenta gestione contribuisce alla riduzione dei gas serra oltre che alla fertilità. L’utilizzo di scarti di filiera per la produzione di ammendanti da restituire al suolo è un esempio di economia circolare e sostenibilità ambientale.
 BERTOLDI DANIELA BONA ANDREA CESCHINI ANDREA CRISTOFORETTI SILVIA SILVESTRI
BERTOLDI DANIELA BONA ANDREA CESCHINI ANDREA CRISTOFORETTI SILVIA SILVESTRI
Il progetto HYDRORG “Metodi di studio dell’interazione tra ammendanti e sostanza organica del suolo: il caso dell’Hydrochar”, co-finanziato dalla Fondazione “Valorizzazione Ricerca Trentina” (2° Bando Eccellenze 2021) e sviluppato in collaborazione con l’Università degli Studi di Milano si pone l’obiettivo di studiare le caratteristiche di un hydrochar (HC) ottenuto da fanghi agro-industriali e di indagare gli effetti del solo HC e di una miscela HC+compost sulle proprietà agronomiche del suolo, in particolare sulla sostanza organica e la fertilità, in confronto al solo compost. L’hydrochar è un prodotto solido ottenuto attraverso un processo di carbonizzazione idrotermica che avviene a temperature tra 180 e 220 °C,
in acqua e in pressione. Questa recente tecnologia permette di trattare biomasse ad elevata umidità ottenendo un prodotto ricco di carbonio e altri nutrienti e per questo potenzialmente interessante per un impiego come ammendante o per aumentare lo stoccaggio di carbonio nei suoli. Tuttavia, precedenti studi hanno mostrato come il trattamento termochimico e la composizione stessa della biomassa di partenza, portino alla formazione di un prodotto con caratteristiche fitotossiche. Allo scopo di ridurre i possibili effetti tossici, l’hydrochar è stato testato anche in miscela 50:50 con compost e dopo maturazione in cumulo areato. Gli effetti sulle caratteristiche chimiche del suolo dei materiali in studio
Studio dell'interazione tra ammendanti e sostanza organica del suolo: il progettoDANIELA
(HC, compost, HC+compost dopo maturazione) sono stati valutati dopo 30 giorni di incubazione nel suolo alle dosi raccomandate misurando vari parametri: emissione di CO2, attività respiratoria, pH, carbonio organico, azoto totale e minerali, fosforo totale e assimilabile, potassio e magnesio scambiabili e capacità di scambio cationico. Il carbonio è inoltre stato studiato in modo più approfondito mediante spettrometria di risonanza magnetica nucleare, per distinguerne le diverse forme. Infine, è stata effettuata una prova di germinazione con lattuga per testare la presenza di sostanze fitotossiche.



I primi risultati, in fase di pubblicazione su rivista scientifica internazionale, evidenziano che il terreno aggiunto di HC è caratterizzato da un iniziale maggior contenuto di fosforo e di azoto totale e ammoniacale rispetto al terreno addizionato con compost ma dopo 30 giorni, si ha un calo dell’azoto totale e ammoniacale.
L’aggiunta al terreno della miscela HC+compost ha portato ad un aumento del fosforo assimilabile e ad un più alto indice di crescita della lattuga rispetto al solo compost. Dopo questa breve fase iniziale del progetto, sono state allestite ulteriori prove di incubazione in condizioni controllate che verranno monitorate per almeno un anno per seguire nel tempo gli effetti dei prodotti in studio sulle proprietà agrochimiche del suolo, conoscenze utili sia per la produzione di ammendanti di maggior qualità sia per una più consapevole gestione dei suoli non solo in termini di fertilità, ma anche da un punto di vista ambientale.

La regolazione della carica con l’intervento meccanico permette di ridurre l’utilizzo di prodotti di sintesi per il diradamento e offre maggiori strumenti per la frutticoltura biologica.
PANTEZZI JONATHAN PASQUALINI* ANDREA GUERRA* CHRISTIAN IOB* DAMIANO MOSERLa regolazione della carica dei frutti è una pratica fondamentale per ottenere produzioni di qualità nel melo. Tradizionalmente viene eseguita con l’utilizzo di molecole e prodotti commerciali che aumentano la naturale cascola dei fiori e dei frutticini in eccesso rispetto al corretto numero che la pianta può supportare. Accanto all’utilizzo di prodotti di sintesi si è sviluppata anche la tecnica “meccanica”, più utilizzata soprattutto nel settore biologico poiché sono previste limitazioni nell’uso di molecole di sintesi. La tecnica meccanica utilizza dei flagelli che, girando ad elevata velocità, strappano i fiori evitando lo sviluppo dei frutticini. Accanto al modello di macchina diradante Darwin, maggiormente diffusa, nel corso di una prova spe -
rimentale è stato provato anche un prototipo denominato Floris, prodotto dalla ditta Agroxx, con il quale sono state diradate alcune piante di tre diverse varietà (Gala, Golden D. e Fuji) secondo uno schema sperimentale adatto a questo tipo di confronti (Pantezzi et al. 2022 Hacta hort. 1344:87-92). La prova è stata condotta nell’azienda sperimentale di Maso delle Part nel fondovalle dell’Adige nel comune di Mezzolombardo. Sono state eseguite alcune strategie di diradamento, messe a confronto con un testimone non diradato, e successivamente sono state raccolte e calibrate singolarmente alcune piante per ogni tesi per valutare l’effetto del diradamento sulla produzione per pianta. Dalle osservazioni effettuate si è evidenziato in

Esperienza di diradamento dei frutti con intervento meccanicoTOMMASO * Unità ricerca e sperimentazione agronomica nella frutticoltura - Fondazione Edmund Mach
generale un effetto positivo di tutti gli interventi diradanti rispetto al testimone e le strategie più efficaci, come mostrato nelle tabelle 1, 2 e 3,
sono risultate perlopiù quelle con l’intervento chimico e con quello meccanico eseguito con la macchina diradante Darwin.
Variabile a confronto Chimico Darwin Florix 1 Florix 2 Test non diradato
Allegagione (%) 62,5 a 69,5 a 99,0 ab 90,4 ab 118,1 b
Produzione (kg/pianta) 26,8 b 19,3 a 24,8 b 27,5 bc 31,9 c
Numero medio frutti per pianta 161,5 b 108,6 a 167,4 b 183,2 b 226,6 c
Peso medio del frutto (g) 166,5 b 178,3 a 149,1 c 150,3 c 141,5 c
Produzione inferiore a 70 mm (%) 20,2 ab 10,5 a 33,8 cd 29,1 bc 41,3 d
Produzione fra 70-80 mm (%) 58,0 ab 55,2 ab 57,1 ab 64,0 b 53,2 a
Produzione maggiore di 80 mm (%) 21,8 b 34,3 c 9,0 a 6,9 a 5,5 a
Rapporto tra produzione e vigoria della pianta (kg/cm2 area tronco) 1,6 ab 1,1 c 1,4 a 1,6 ab 1,8 b
Rapporto tra produzione e vigoria della pianta (Numero frutti/cm2 area tronco) 9,6 a 6,1 c 9,7 a 10,8 ab 13,0 b
Area della sezione del tronco (cm2) 17,3 a 17,8 a 17,7 a 17,9 a 18,5 a
Tabella 1
Confronto tra le strategie diradanti su varietà Gala*
Tabella 2 Confronto tra le strategie diradanti su varietà Golden D.*
Allegagione (%) 40,5 a 39,9 a 48,4 a 50,4 a 95,5 b
Produzione (kg/pianta) 24,93 b 16,58 c 27,42 b 28,92 ab 33,60 a
Numero medio frutti per pianta 116,33 b 89,00 b 155,17 a 165,67 a 184,75 a
Peso medio del frutto (g) 214,76 b 187,71 a 179,02 a 175,83 a 187,03 a
Produzione inferiore a 70 mm (%) 3,15 b 12,03 a 10,13 a 11,48 a 8,17 ab
Produzione fra 70-80 mm (%) 23,42ab 33,10 c 51,15 a 50,89 a 49,10 a
Produzione maggiore di 80 mm (%) 73,44 c 54,87 b 38,72 a 37,63 a 42,73 a
Rapporto tra produzione e vigoria della pianta (kg/cm2 area tronco) 1,16 a 0,67 b 1,22 a 1,19 a 1,16 a
Rapporto tra produzione e vigoria della pianta (Numero frutti/cm2 area tronco) 5,43 a 3,58 b 6,90 a 6,76 a 6,39 a
Area della sezione del tronco (cm2) 21,72 a 26,5 a 24,0 a 25,2 a 31,32 b
Allegagione (%)
121,6 a 111,0 a 171,9 b 78,9 a
Produzione (kg/pianta) 23,2 a 31,8 a 32,2 a 25,0 a
Numero medio frutti per pianta 98,2 a 164,1 b 171,8 b 114,8 ab
Peso medio del frutto (g) 252,4 b 197,3 a 209,3 a 224,4 a
Produzione inferiore a 70 mm (%) 1,8 a 8,7 a 7,8 a 4,6 a
Produzione fra 70-80 mm (%) 17,9 a 38,7 a 39,2 a 27,0 a
Produzione maggiore di 80 mm (%) 80,3 b 52,5 a 52,9 a 68,3 b
Rapporto tra produzione e vigoria della pianta (kg/cm2 area tronco) 0,9 a 1,5 b 1,2 ab 1,0 a
Rapporto tra produzione e vigoria della pianta (Numero frutti/cm2 area tronco) 3,8 a 7,9 c 6,4 bc 4,4 ab
Area della sezione del tronco (cm2) 26,7 b 21,1 a 27,1 b 26,5 b
* Va letta in senso orizzontale: a lettera diversa corrisponde una differenza statisticamente significativa.
Tabella 3
Confronto tra le strategie diradanti su varietà Fuji*
L’intervento con il modello Floris in generale ha dimostrato un effetto minore rispetto alle altre tesi; tuttavia, poichè l’entità del diradamento va commisurata alla carica presente in pianta, alle caratteristiche delle varietà, sia in termini di predisposizione alla cascola naturale che al ritorno a fiore, questo aspetto può essere considerato comunque adeguato. In ogni caso, agendo su velocità di avanzamento e di rotazione dei flagelli è possibile regolare l’intensità del diradamento al fine di adeguare correttamente la carica e ridurre così i successivi passaggi manuali. Il vantaggio dell’intervento meccanico è indubbiamente quello di poterne

controllare l’effetto in breve tempo, senza dover aspettare la cascola fisiologica che si ha con l’uso di sostanze ormonali. Oltre a questo, il diradamento meccanico, che va eseguito in una fase fenologica precoce, ha un’azione maggiore sul ritorno a fiore per l’anno successivo.
Va evidenziato anche che con il modello a bracci indipendenti è possibile agire a diverse altezze della pianta mentre, inclinando i singoli rotori, dovrebbe essere possibile modificare l’entità dell’asportazione dei fiori. Andranno comunque proseguite le esperienze per mettere a punto l’azione della macchina adattandola in base alle necessità del diradamento.
Valutazione dell’impatto della strategia Farm to Fork sulla melicoltura trentina con il metodo dell’azienda ordinaria
The Farm to Fork strategy and its impact on agricultural production in the EU: analysis of two case studies in Trentino

Through the Farm to Fork strategies forming part of the EU Green Deal, the European Commission presented its vision for promoting greater sustainability of agricultural systems by 2030, but through the reduction in input provided by the programme, which in particular regards crop protection products (-50%) and fertilizers (-20%). FEM participated in a multidisciplinary team (EU) to examine the feasibility and possible consequences of the reduction of the input in apple and vine production, two of the ten crops considered. By identifying a number of model farms that adopt integrated and organic production programs in Trentino, three new management scenarios were examined and compared to the current model. This study provided some agronomic information and insight into the productive consequences on apple of these strategies.
Il Green Deal, deliberato dalla Commissione Europea nel dicembre 2019 per far fronte alla sfida del cambiamento climatico, fissa per l’Unione
Europea l’obiettivo di ridurre le emissioni nette di gas a effetto serra del 55% entro il 2030, rispetto al 1990, per poi azzerarle entro il 2050. Il per-
L'analisi dei possibili impatti che l’applicazione della strategia Farm to Fork determinerà a livello di azienda agricola è fondamentale sia per i responsabili politici che per le parti interessate, al fine di avviare un dibattito basato su dati realistici sulla futura sostenibilità economica della produzione agricola nell'UE.
GINO ANGELI GIORGIO DE ROSTabella 1
Obiettivi della strategia F2F a livello di azienda agricola
corso per raggiungere tali obiettivi generali è stato articolato in una serie di strategie e obiettivi settoriali, per l’agricoltura la strategia Farm to Fork (F2F), promossa dalla Commissione nel maggio 2020 per garantire un sistema alimentare equo, sano e rispettoso dell’ambiente (Tab. 1). Relativamente alle produzioni vegetali gli obiettivi della strategia F2F prevedono di dimezzare entro il 2030 in tutta Europa l’uso di agrofarmaci e fertilizzanti di sintesi e di portare al 25% del totale la superficie coltivata con il metodo biologico. Entro dicembre 2023 la Commissione è tenuta a presentare una proposta legislativa per regolare nel concreto l’azione F2F. È stato chiaro da subito che gli ambiziosi obiettivi definiti dalla strategia comporteranno un cambiamento epocale delle politiche agricole, alimentari e di mercato dell’UE.
Quale sostenibilità economica con l’attuazione delle misure F2F
Gli impatti che ci si possono attendere sono rilevanti a livello microeconomico, sulle singole aziende agricole, come anche a livello macroeconomico, sugli equilibri dei mercati globali delle derrate alimentari, considerato che l’UE è un importante produttore agricolo non solo per il consumo interno, ma svolge un ruolo da protagonista sul sistema internazionale. L’analisi di tali possibili impatti è fondamentale sia per i responsabili politici che per le parti interessate, al fine di avviare un dibattito basato su dati realistici e coerente sulla futura produzione alimentare nell’UE. CropLife Europe e altri partner hanno commissionato uno studio al quale la
1
Fondazione E. Mach ha partecipato su coinvolgimento dell’Università di Wageningen (W. Ec. Research) per valutare come gli obiettivi della strategia F2F incideranno a livello di azienda agricola.
L’indagine (Bremmer et al. 2021 Wag. Ec. Res. Report 150:70) ha analizzato gli impatti su 10 colture vegetali, 5 annuali (frumento, colza, mais, barbabietola da zucchero, pomodori) e 5 poliannuali (mele, uva, olive, agrumi e luppolo), nella realtà agricola di 7 Paesi membri (Finlandia, Francia, Germania, Italia, Polonia, Romania e Spagna). Per ciascuna produzione vegetale sono stati analizzati dai 2 ai 3 casi studio, costituiti da combinazioni di coltura/paese rappresentativi (per es. Italia e Polonia per il melo; Italia, Francia e Spagna per l’uva da vino). Nel complesso sono state realizzate 25 indagini, due delle quali (melo e vite) svolte in FEM.
La presente nota riferisce sulle implicazioni per la coltura del melo, a livello di azienda agricola, emerse dal caso di studio trentino (Angeli et al 2022 Inf. Agr. 33:57-60).
Le indagini erano gestite da esperti di Istituti di ricerca (7 agronomi per FEM) attraverso un articolato questionario tecnico. Per ciascun fattore della produzione analizzato si è operato proponendo la soluzione agronomica più innovativa da un punto di vista tecnico ed ecologico, ma con l’obiettivo di salvaguardare la sostenibilità economica aziendale; dunque si trattava di proporre l’introduzione di innovazioni tecnologiche e fattori della produzione, purché trasferibili nella pratica al momento della stesura del documento. Nel caso di fertilizzanti e agrofarmaci si è proposto ad esempio
Riduzione d'uso di agrofarmaci di sintesi (-50%) 2 Riduzione d'uso di agrofarmaci più pericolosi (-50% indice di rischio armonizzato - HRI)
Riduzione delle perdite di nutrienti al terreno (-50%)
Riduzione d'uso di fertilizzanti di sintesi (-20%)
Incremento della superficie a biologico (25% della sau a livello EU) 6
Incremento di biodiversità dell’agroecosistema (destinare 10% sup. a fasce fiorite, siepi, muretti a secco, sfalcio alternato, nidi artificiali, insect hotel, ecc.)
-50
Tabella 2 e 3
Perdite di resa (%) stimata (Tabella 2, sopra) e variazioni di prezzo (%) stimate (Tabella 3, sotto) per la produzione di mele in Italia e Polonia nello scenario che prevede l’adozione completa della proposta F2F
-6 -50
un maggior ricorso a concimi organici e di sostanze attive non di sintesi, a strumenti di supporto alle decisioni, all’incremento del monitoraggio fitosanitario, alla difesa semiochimica, mentre in sostituzione di alcuni erbicidi chimici si optava, laddove praticabile, all’utilizzo di attrezzature meccaniche o a una combinazione di soluzioni tecniche.
Per una azienda famigliare trentina specializzata nella produzione di mele, la stima degli scenari evidenzia diverse conseguenze pratiche. Perseguendo gli obiettivi F2F, in particolare la combinazione degli obiettivi di riduzione agrofarmaci, inclusi erbicidi e fitoregolatori, di riduzione nutrienti e di destinare un 10% di superficie con infrastrutture per favorire la biodiversità, si prospetta nell’azienda integrata una perdita di resa intorno al 23,8% (457 quintali/ha anziché 600).
In termini di prezzi si ipotizza una riduzione del 6% per le mele trentine, causa maggior deprezzamento qualitativo.
Il valore dell’indice di rischio armonizzato (HRI) in azienda a conduzione integrata si riduce a 214, rispetto al livello di 487 relativo all’attuale gestione adottata, dato che soddisfa gli obiettivi F2F di riduzione d’uso e della pericolosità di agrofarmaci.
A titolo di comparazione, l’azienda a conduzione biologica trentina manifesta attualmente un HRI di valore 799 (40% > dell’azienda IPM) e una resa complessiva di mele pari a 440 quintali (-27% rispetto all’azienda integrata); paradossalmente, emerge che applicando i parametri unionali armonizzati l’azienda biologica a melo manifesta il peggiore indice di rischio
oltre che la minore resa produttiva, anche nell’ipotesi si applicassero le strategie F2F. Da questo studio emerge che l’opzione di conversione da sistema integrato a biologico non sia vantaggiosa, né in termini di riduzione del rischio, né in termini di resa produttiva. Pertanto, l’espansione dell’area a biologico prevista dalla F2F e fissata al 25% sul totale, non risulterebbe vantaggiosa né in termini produttivi né di sicurezza ambientale. Analoghi riscontri, ma in netto peggioramento, sono emersi nel caso di studio su melo applicato in Polonia.
In relazione alle possibili conseguenze derivanti dall’applicazione della F2F nelle aziende melicole, le risultanze scaturite da questo studio forniscono alcune prime informazioni in merito, seppure la numerosità di variabili in gioco evidenziano la necessità di ulteriori valutazioni. Da segnalare ad esempio la variabile climatica, fortemente diversificata da regione a regione nell’intera area europea. Ciò si traduce nella possibilità concreta di raggiungere gli obiettivi del programma F2F per una specifica coltura vegetale in alcuni paesi, ma non in altri, o solo limitatamente e con conseguenze di molto peggiorative sulle rese e/o sulla qualità. Un secondo importante aspetto, per limitare la contrazione della resa produttiva aziendale, dunque per garantire la sostenibilità economica dell’azienda agricola, è la necessità di incrementare la ricerca applicata e il trasferimento tecnologico delle innovazioni; servirà ad es. accelerare sulla produzione di fitofarmaci di nuova generazione, sullo sviluppo di mezzi tecnici alternativi, sull’applicazione di tecno-
logie agronomiche di precisione, servirà inoltre applicare maggiormente l’innovazione digitale, la formazione e la consulenza tecnica per l’operatore in relazione dei nuovi approcci di produzione.
Certamente l’attività agricola potrà diventare sempre più sostenibile con l’ambiente, ma nella misura in cui nuovi strumenti di innovazione tecnologica, di agricoltura di precisione e non da ultimo di nuove selezioni genetiche si renderanno

disponibili. Bruxelles dovrà da un lato tener conto delle minori entrate economiche delle aziende agricole, dovute all’applicazione della F2F, e dovrà sbloccare al più presto l’iter autorizzativo delle tecniche NBT, se si intendono perseguire gli obiettivi della F2F e garantire resilienza ad un settore già sottoposto a diverse criticità emergenti.
Hanno collaborato al progetto Claudio Ioriatti, Duilio Porro, Tommaso Pantezzi, Maurizio Bottura, Roberto Zanzotti.
Aphelinus mali, la vespetta introdotta dalle Americhe un secolo fa per il controllo biologico dell’afide lanigero
Aphelinus mali, the wasp introduced from the Americas a century ago for the biological control of wooly apple aphid.
E. lanigerum and its parasitoid A. mali are an example of biological control of a pest that was accidentally introduced into Europe. Field and laboratory experiments have increased the knowledge of host and parasitoid biology and their relationship. Moreover, these studies focused on the interferences of natural control systems caused by organic or integrated pest management in different climatic areas of our territory, suggesting innovative guidelines.
L’afide lanigero del melo (Eriosoma lanigerum Hausmann) di origine Nord Americana, laddove il suo ospite principale è l’acero canadese, si è diffuso nei distretti frutticoli Europei (1926-1931) attraverso lo scambio di astoni di melo colonizzati (ospite se -
condario). Questo afide danneggia attraverso punture di nutrizione sia il sistema vascolare aereo che radicale dell’albero. E. lanigerum si caratterizza, come altre specie di afidi, per una rapida crescita riproduttiva e numerose generazioni per stagione

Conoscenze approfondite della biologia di ospite e parassitoide, del loro rapporto e delle perturbazioni apportate dal sistema agronomico nel nostro territorio, possono suggerire linee guida di gestione delle produzioni che preservino i protagonisti del controllo biologico naturale.
Foto 1 Colonie di afide lanigero sulla chioma del melo
il che ha come conseguenza la formazione di dense colonie su tronco, branche, germogli e radici che ricopre con una secrezione cerosa e filamentosa, interferendo sulla fisiologia della pianta oltre ad imbrattare la frutta, rendendola incommerciabile (Baldessari e Angeli 2018 Atti Giorn. Fitopatol. 1:141-149).

Le infestazioni possono essere controllate con l’uso di trattamenti insetticidi, generalmente in post-fioritura (giugno), tuttavia è in crescita l’interesse nell’applicazione dei principi di produzione integrata a basso impatto, anche in virtù della sorprendente azione di controllo biologico operata verso questo afide da organismi naturali, sia predatori (forficule in primis) che il suo parassitoide specifico Aphelinus mali (Haldeman) (Ioriatti et al. 2019 isbn 9781786762566).
Diversi studi europei hanno evidenziato discrepanze sull’efficacia dei predatori (Blommers 1994 Annu. Rev. Entomol. 39(1):213-241) dovute probabilmente alla variabilità dell’ecosistema meleto in ragione alla collocazione geografica di coltivazione, in particolare fra distretti del centro-sud e nord Europa. Il controllo biologico dell’afide lanigero da parte
di A mali è considerato invece dalla bibliografia scientifica come uno degli esempi di maggior interesse di controllo biologico applicato in frutticoltura (Asante et al. 1991 Entomol. Exp. Appl. 60:261-270). Questo limitatore naturale, anch’esso di origine canadese, si è acclimatato in gran parte dei distretti di produzione europei a seguito di trasferimenti mirati dai luoghi di origine avvenuti sul finire degli anni 20 del secolo scorso (Dumbleton e Jeffreys 1938 N. Z. J. Sci. Technol. 20(3):183-190).
DeBach riportava già negli anni ‘60 che A. mali fosse considerato un agente di controllo biologico di successo in oltre 40 stati e tra questi anche l’Italia. Pertanto, il sistema biologico afide lanigero/afelino è stato ampiamente studiato già in passato, poi inesorabilmente abbandonato per diversi decenni con l’avvento della chimica di sintesi.
Negli ultimi decenni la suscettibilità di alcune varietà di mele e portainnesti nanizzanti, la semplificazione degli agroecosistemi e i programmi di gestione di parassiti e malattie con agrofarmaci ad ampio spettro sono i fattori individuati come responsabili dell’inefficacia del controllo biologico naturale dell’afide lanigero (Angeli e Simoni 2006 J. Pest Sci. 79:175-179); Baldessari et al. 2007 L’Inf. Agr. 63:2022). Anche recenti tecniche agronomiche, come la rete monofila, introdotta per il controllo della carpocapsa o della cimice asiatica, può favorire le infestazioni dell’afide in quanto creano delle condizioni idonee per il suo sviluppo e riducono la possibilità di colonizzazione del fogliame della pianta da parte dei limitatori naturali. Per l’implementazione più efficace dei principi IPM e agricoltura biologica, il monitoraggio sia dell’abbondanza dei parassiti che del suo nemico naturale è ugualmente importante. La conoscenza della presenza e della fenologia stagionale di E. lanigerum e dei suoi specifici nemici naturali, A. mali, è essenziale per dettare azioni di controllo razionale. Per indagare come le variabili coinvolte nell’efficacia del controllo biolo-
Foto 3
Colonia di afide lanigero parassitizzata con evidenti mummie nere con foro di uscita del parassitoide
gico delle popolazioni dell’afide lanigero per mezzo di A. mali influiscono sull’efficacia del controllo biologico naturale, è stata condotta in provincia di Trento una sperimentazione pluriennale sul campo, a iniziare dal 2017; sono stati presi in esame frutteti a conduzione biologica e IPM della varietà Fuji. L’evoluzione della colonizzazione delle piante da parte di E. lanigeum, il volo di A. mali e la percentuale di parassitizzazione delle colo-
nie dell’afide sono stati monitorati in frutteti posti ad altitudini differenti (80-400 m e 400-850 m s.l.m.).
I risultati hanno messo in evidenza come l’altitudine di coltivazione influenzi maggiormente il rapporto afide/parassitoide, sbilanciato a favore dell’afide, rispetto ad altre variabili considerate (strategie di difesa chimica) (Fig. 1), probabilmente a causa delle condizioni ambientali più sfavorevoli al parassitoide rispetto
Figura 1
Andamento della parassitizzazione di E. lanigerum da A. mali nei diversi frutteti a conduzione biologica e integrata monitorati nel 2018

Pianura - biologico Collina - biologico Collina - integrato
Pianura - integrato
Pianura
Collina
2017 14-giu 27-giu 13 20-lug
2018 21-giu 5-lug 14 18-lug
2019 1-giu 14-lug 13 30-lug
2017 4-lug 28-lug 24 16-ago
2018 28-giu 26-lug 28 23-ago 2019 1-lug 30-lug 29 5-ago
Tabella 1
Picco della popolazione E. lanigerum (A), Picco della popolazione A. mali (B), A - B scarto (giorni) tra i due picchi (parassita e parassitoide) e data della parassitizzazione completa, rilevati in 3 anni di monitoraggi
all’afide ospite alle quote più elevate (Chiesa et al. 2019 IOBC-WPRS Bull. 146:82-84). Infatti, le temperature ideali di sviluppo e riproduzione del parassitoide (27 °C) sono superiori di qualche grado °C rispetto a quelle del suo ospite (24 °C) e questo porta nelle zone collinari ad un ritardato nella risoluzione dell’infestazione rispetto alla pianura (Tabella 1). Sperimentazioni di laboratorio hanno indagato inoltre l’effetto dei principali prodotti fitosanitari utilizzati nella gestione fitosanitaria sulla sopravvivenza di A. mali evidenziando notevoli differenze tra principi attivi (tossicità pp.aa. saggiati: debolmente tossico Clorantraniliprole; mediamente tossico Sulfoxaflor, Imidacloprid, Lam-
bda-cialotrina e Deltametrina; molto tossico Acetamiprid e Spinetoram). Lo studio della persistenza d’azione dei principi attivi, inoltre, ha fornito indicazioni anche sul migliore posizionamento degli agrofarmaci in relazione al ciclo biologico del parassitoide da preservare.
L’analisi di questi ed altri elementi ha contribuito al miglioramento delle conoscenze della biologia di ospite e parassitoide, del loro rapporto e delle perturbazioni apportate dal sistema agronomico nel territorio trentino, indirizzando verso linee tecniche di difesa innovative, funzionali a preservare i protagonisti del controllo biologico, sia in produzione integrata che biologica.

Foto 4
Colonia di afide lanigero alla ripresa vegetativa
Rapid apple decline (RAD) is a complex process that initially presents with mild and barely visible symptoms and progresses, in some cases, until the plant has died. Decline was first observed in the 1980s and has since recurred in various years, including 2021. In Trentino, since the very first observations in the early 2000s, a number of experimental studies have been conducted to analyse the phenomenon. So far, no clear solution to the problem has been identified; however, in 2021, an overall analysis of the activities undertaken was carried out, making it possible to identify the factors that can mitigate or exacerbate the decline. The possible abiotic causes include interaction between the soil and RAD, in particular associated with the percentage of organic substance and temperature fluctuations at the end of the winter. Further research and the geostatistical processing of the collected data are currently underway.
Quella che è conosciuta come moria del melo, è un fenomeno che si manifesta con un’ampia sintomatologia: inizia con sintomi poco accentuati e visibili per poi progredire a seconda dei casi fino al completo deperimento della pianta. Nel 2021 la moria è ricomparsa in maniera grave colpendo un numero elevato di frutteti. I primi sintomi si sono osservati alla ripresa vegetativa: le piante, in particolare di Gala, presentavano profonde spaccature della corteccia del fusto. Molte delle piante colpite, dopo un apparente miglioramento dovuto alle condizioni climatiche del mese di maggio, sono definitivamente deperite nel periodo estivo ed autunnale. Non è stato il primo anno in cui ci siamo scontrati con questa problematica: il fenomeno era noto anche negli anni 80 e 90,
tuttavia a partire dai primi anni 2000 la moria ha interessato un numero maggiore di frutteti e si è riproposta in diverse annate. Le 4 annate con forti morie, per intensità e diffusione sono state 2005-2009-2010 e 2021.
In Trentino, a partire dalle prime osservazioni ad inizio anni 2000, sono state messe in atto numerose indagini di campo e prove sperimentali per trovare possibili soluzioni tecniche. Ad oggi non è stata individuata una chiara interpretazione del fenomeno della moria, tuttavia nel 2021 è stata effettuata un’analisi complessiva delle attività finora svolte da tecnici, sperimentatori e ricercatori sia del CTT che del CRI, e questo ha restituito un quadro più chiaro della problematica mettendo in luce i fattori che possono mitigarla o aggravarla (Fig. 1).
MATTEO DE CONCINIFigura 1
Moria del melo: severità della problematica in Trentino a partire dai primi anni Duemila
Moria del melo: analisi delle indagini e delle attività
Figura 2 Fertilità del suolo: percentuale di sostanza organica in diverse porzioni dell’appezzamento; analisi condotta in 10 frutteti con moria in centro Val di Non
I primi anni in cui si è manifestata la moria ci si è concentrati nella ricerca di un possibile agente eziologico scatenante. In diverse occasioni si sono raccolti ed esaminati campioni di legno da piante colpite e spesso è emerso come sui tessuti analizzati vi era la presenza di diversi funghi e batteri: si trattava di specie ubiquitarie e saprofite che pur aggravando lo stato di sanità della pianta, non rappresentano la causa scatenante della moria.
Ci si è parallelamente interrogati su possibili cause abiotiche: condizioni climatiche o agronomiche che portano le piante in sofferenza. Una delle tematiche indagate è la possibile interazione tra suolo e moria, questo perché è sempre apparsa evidente una maggior incidenza del fenomeno nei casi di rinnovi con bonifiche più o meno impattanti, inoltre i casi di moria tendevano a comparire ciclicamente sempre nelle stesse zone. Nel 2007, 2009 e 2015 sono state condotte diverse analisi del suolo in frutteti con presenza di moria. Nei frutteti nei quali la moria si manifestava a “macchie”, ossia con gruppi di piante sofferenti ubicate in specifiche zone dell’appezzamento, le indagini hanno evidenziato come la percentuale di sostanza organica nella parte di frutteto in cui si concentravano le morie era mediamente inferiore rispetto alla parte indenne (Fig. 2). Nel 2009 e nel 2015 sono state eseguite analisi dei principali elementi presenti nel legno e nelle foglie di piante con sintomi di moria e di piante sane. I valori di alcuni elementi si
discostano tra pianta sana e pianta malata, con significatività differente. Tuttavia, per questi lavori di dettaglio, è difficile offrire una chiara ed univoca interpretazione, sicuramente attraverso queste analisi otteniamo la fotografia della reazione fisiologica della pianta al fenomeno della moria, ma non abbiamo indicazioni utili in merito alla sua causa.
Nel 2010 e successivamente nel 2015, tra le azioni più significative che sono state condotte ci sono le sperimentazioni in merito alla stanchezza del terreno e alla valutazione dell’effetto dell’apporto di sostanza organica nel mitigare la moria. Tutte le pratiche agronomiche testate (fumigazione, apporto di sostanza organica di diversa matrice, sostituzione del suolo) hanno avuto ricadute positive sulla produzione e crescita delle piante ma, non sopraggiungendo negli anni successivi il fenomeno della moria, non si è risusciti a valutarne il grado di efficacia nei confronti di questa problematica.
Nel corso del 2014, sono state compilate e raccolte 260 schede specifiche per il rilievo della moria in campo. L’analisi statistica di questi dati non ha restituito certezze ma ha offerto comunque alcune tendenze: alcune condizioni sono sicuramente associabili a casi di deperimento grave come la tipologia di suoli leggera e le lavorazioni del suolo impattanti al momento del reimpianto. Nel 2015 è stato condotto un monitoraggio statistico della problematica: il territorio provinciale è stato diviso in 8 macroaree, nelle quali è stato
controllato il 10% dei frutteti di età inferiore ai 6 anni. Trattandosi di un fenomeno imprevedibile negli anni e fortemente legato a frutteti o areali ben delimitati, il numero di piante colpite da moria rapportate all’intero estimo frutticolo di una macroarea, ha fatto emergere un quadro poco preoccupante della problematica.
Nel 2018, attraverso una specifica sperimentazione, sono stati controllati e mappati 17 frutteti con moria sparsi in tutto il Trentino. Sovrapponendo le mappe raccolte a terra con le immagini catturate dal drone in modo da spazializzare correttamente i dati, si è scientificamente dimostrato come il fenomeno della moria sia di aggregazione, ossia nelle vicinanze di una pianta morta vi è un’alta probabilità di ritrovarne altre più o meno sofferenti: è quindi innegabile la connessione tra moria e caratteristiche del suolo.
Nel 2021 è stato svolto un lavoro di indagine in collaborazione con l’Associazione dei produttori APOT. Sono state raccolte 280 schede di indagine e dall’analisi di queste ultime sono emerse alcune interessanti indicazioni che si possono così sintetizzare: quasi la metà dei frutticoltori dichiara che il suolo nei frutteti soggetti a moria è leggero o ricco di scheletro, e nell’80% dei casi è povero di sostanza organica e poco profondo. Inoltre solo il 30% dei frutticoltori apporta sostanza organica all’impianto per migliorare la fertilità del suolo. L’ipotesi che la moria sia causata da fattori abiotici ci ha indotto a effettuare un’analisi dei dati metereologici con l’obiettivo di valutare il ruolo del
freddo invernale. Analizzando quanto successo nel 2021, nel 2010 e nel 2009, annate accomunate da forti morie, è possibile osservare l’anomalo andamento delle temperature a fine gennaio, con alcune settimane di risalita seguite da un brusco calo perdurato per diversi giorni in tutte e 3 le annate. Il fenomeno di risalita delle temperature a fine gennaio potrebbe aver indotto le piante ad una risposta fisiologica di lenta ripresa delle attività di traslocazione della linfa, ed il successivo abbassamento ha causato il danneggiamento dei vasi linfatici. Le altre annate, caratterizzate da poca o nulla presenza di moria, hanno andamenti completamente differenti con curve di crescita delle temperature lineari (Fig. 3)
L’ipotesi che identifica come gli sbalzi di fine inverno siano cruciali per la manifestazione del fenomeno non spiega perché il danno non si manifesti in tutto il territorio. Evidentemente esistono micro-differenze climatiche e differenze pedologiche, a volte molto rilevanti, che espongono maggiormente alcuni territori a questa problematica. Per valutare questo è attualmente in corso di elaborazione una specifica analisi geostatistica. Il territorio della nostra provincia è stato diviso in aree omogenee, per le quali è possibile parametrizzare, elaborare e sovrapporre dati climatici pedologici ed i rilievi della moria. L’obiettivo è quello di costruire una mappa di dettaglio per avere una sorta di “vocazionalità” delle diverse zone frutticole alla problematica. Negli areali ad alto rischio sarà necessario mettere in atto tutte le tecniche
Temperature minime assolute settimanali registrate a Cles dal 2000 al 2020 (rappresentate dai punti blu) in confronto con il 2021 (linea arancione): si può notare nel 2021 la decisa risalita delle temperature a partire da metà di gennaio, seguita dall’improvviso e brusco calo
Foto 1
Luglio 2021: vista dall'alto di un frutteto colpito, si notano le piante che ingialliscono per poi disseccarsi completamente
agronomiche che possono mitigare la moria: apportare sostanza organica di qualità più volte durante la vita produttiva dell’impianto, favorire l’inerbimento anche del sottofilare, evitare lavorazioni del suolo impattanti e mantenere le piante in



equilibrio vegeto-produttivo. Altre pratiche potenzialmente interessanti come l’impiego di portinnesti tolleranti, necessitano di ulteriori specifiche indagini o prove di campo, da condurre in frutteti “pilota” all’interno delle aree ad alto rischio.
Foto 2
Piante che deperiscono nel periodo estivo
Foto 3
Autunno 2021: vista dall'alto di un frutteto colpito, si notano gli spazi vuoti lasciati dalle piante già estirpate, e nuove piante che disseccano
Il rilievo autunnale della ticchiolatura del melo, conosciuto anche come analisi del PAD (Potential Ascospore Dose), è una metodica sviluppata in USA e utilizzata per stimare la “quantità” di inoculo del patogeno presente nel frutteto (MacHardy et al. 1983 Prot. Ecol. 5:103-125). Si effettua sulle foglie ancora in pianta, dopo la raccolta dei frutti, e serve a fare una previsione sul rischio del verificarsi delle infezioni primarie in primavera.

Il PAD nella sua formula originaria è abbastanza laborioso da determinare ed il calcolo è stato semplificato per consentirne un utilizzo pratico in campo (MacHardy 2000 Acta Hortic. 525:123-131). Il rilievo consiste in un campionamento di tipo sequenziale e, a seconda dell’altezza media delle piante (superiore o inferiore i 2 m
circa) e della densità di piantagione (normale o alta), vengono ispezionati almeno 100 germogli (massimo 600) da gruppi di 10-20 alberi con 10-5 germogli/pianta rispettivamente. Con il susseguirsi delle evidenze sperimentali registrate in campo, sono state proposte da diversi autori alcune variazioni della metodica; tuttavia, in ogni caso rimane fondamentale garantire la rappresentatività aziendale del campione. A titolo di esempio, l’ispezione di un frutteto di 1.000 piante, scelta una direzione di avanzamento, partendo dai bordi e cercando di coprire l’intera superficie, richiede l’osservazione di una pianta ogni 100 per un totale di 10 piante e 10 germogli/pianta. Il tempo necessario richiesto è in media tra 20 e 45 minuti a seconda della situa-
MASSIMO MUCCIIl rilievo del PAD per valutare il rischio di infezioni primarie
La diagnosi precoce consente un rilievo della ticchiolatura anche su foglie infette asintomatiche e può risolvere un limite applicativo del PAD. L’eradicazione dell’inoculo rappresenta uno strumento prezioso per migliorare la sostenibilità della strategia di difesa.
Figura 1 (A e B)
Campionamento sequenziale per determinare il livello di rischio infezione; ALTO= adottare un programma di protezione completo a partire dalle punte verdi; MODERATO= sanificare e in base all’evento che si verifica per primo, adottare un programma di trattamenti dilazionato a partire da bottoni rosa con riduzione dei dosaggi e frequenza o in alternativa intervenire dopo tre infezioni lievi (valore RIMpro ≤300); BASSO= adottare un programma di protezione dilazionato
N. cumulativo di foglie colpite
+ 50 45
N. cumulativo di foglie colpite
30
20
10
40 35 25 15 5
A 10 20 30 40 50 60 0
Basso Campionare altre 10 piante Alto
Soglia di intervento di "sanificazione"
80
60
40
20
+ 100 90 70 50 30 10
N. di piante (10 germogli/pianta) B 10 20 30 40 50 60 0
N. di piante (10 germogli/pianta)
Basso Moderato Campionare altre 10 piante Alto
zione sanitaria riscontrata. In base al numero di foglie colpite, osservando sia la superficie superiore che quella inferiore, includendo anche i sintomi sospetti, lo schema riportato in figura 1 (ridisegnato su originale MacHardy) consentirà di individuare per il meleto ispezionato: A) una soglia di rischio infezione e il programma fungicida primaverile più appropriato, B) la necessità di intervenire con la sanificazione della lettiera.
È sconsigliato effettuare il rilievo del PAD quando sono presenti nel raggio di circa 30 m di distanza dal frutteto piante infette perché non adeguatamente protette, abbandonate o
spontanee. In questi casi il rischio di infezioni primarie è da considerare sempre elevato. Il rilievo inoltre non può essere eseguito quando sono stati impiegati in modo ripetuto per interventi di tipo curativo o su infezioni già esistenti, fungicidi del gruppo IBE (il patogeno in questi casi potrebbe essere ancora vitale in forma latente all’interno dei tessuti vegetali). Un nostro recente studio ha indagato la possibilità di evidenziare e di conseguenza quantificare le infezioni fogliari latenti di ticchiolatura che in autunno spesso non sono visibili (Mucci et al. 2022 Atti Giorn. Fitopat. 2:325-332). Il micelio del fungo inter-
no ai tessuti fogliari, se vitale è capace di riattivare la crescita in forma saprofitaria e porterà alla formazione delle strutture svernanti, preludio agli attacchi nella successiva stagione vegetativa. La metodica prevede l’immersione di foglie asintomatiche per circa 3 minuti in una soluzione di soda caustica (NaOH) al 5%. In caso di positività della reazione, la comparsa di macchie scure irregolarmente circolari evidenzia le aree infette (Foto 1).
Il ruolo delle infezioni invisibili nelle foglie senescenti ad oggi non è stato ancora sufficientemente chiarito ma con molta probabilità queste contribuiscono in modo importante nel determinare il reale potenziale di inoculo presente in campo. La metodica proposta risulterà utile in termini pratici per effettuare una valutazione più precisa del potenziale infettivo presente in campo.
Il presente lavoro è stato svolto con la collaborazione di Graziano Giuliani.
Foto 1
Infezioni secondarie di ticchiolatura apparse dopo immersione di foglie asintomatiche di melo in una soluzione di soda caustica al 5% per 3'

Quando la pulizia dell’irroratrice non viene realizzata correttamente, a seguito della contaminazione puntiforme da prodotti fitosanitari, è causa dello scadimento qualitativo di alcuni corpi idrici. Per questo, il progetto PEI “Pflanzenschutz” (finanziamento FEASR) che ha coinvolto l‘Unione Agricoltori e Coltivatori diretti dell’Alto Adige (Südtiroler Bauernbund), la Fondazione Edmund Mach, il Centro di Sperimentazione Laimburg, il Centro di consulenza per la frutti-viticoltura dell’Alto Adige, la Cooperativa frutticola ROEN e tre aziende agricole, ha voluto approfondire le possibili soluzioni adottabili a livello regionale per prevenire la contaminazione puntiforme da prodotti fitosanitari spesso causata da una non corretta gestione delle fasi che precedono e seguono il trattamento. FEM e i vari partner coinvolti, coordinati dal Süd-

tiroler Bauernbund, hanno soprattutto cercato di confrontarsi con vari esperti per condividere esperienze sia in ambito nazionale che estero, partendo dall’analisi della situazione normativa e tecnica locale.
Fra le principali attività di scambio in cui sono stati coinvolti ricercatori e tecnici si possono citare l’evento Sprayer Cleaning Workshop a Soprabolzano, visite di studio in alcune regioni italiane ed in Svizzera, una tavola rotonda internazionale online.
Fra i principali prodotti del progetto si evidenziano le linee guida sul lavaggio delle irroratrici, le schede tecniche sui sistemi di gestione delle acque residue ed alcuni video riassuntivi delle soluzioni individuate, reperibili sul sito del Südtiroler Bauernbund (sbb. it/it/servizi/dipartimento-innovazione-ed-energie-rinnovabili/progetti/ fitofarmaco).
Foto 1
Valutazione
In the era of climate change and globalisation, the early detection and accurate identification of pathogens and pests represent two of the most important goals of a Plant Health service. In 2019, a new regulation, Regulation (EU) 2016/2031 on protective measures against pests of plants, came into force, redefining the new phytosanitary regime in order to reduce the risk of the introduction and spread of quarantine pests within the European Union. Italian Legislative Decree No. 19/2021 brought Italian legislation into line with the new Regulation and led to the emanation of Italian Ministerial Decree No. 169819/2022, establishing the National network of laboratories. The laboratories belonging to this network must ensure high-level of the results and require accreditation in accordance with standard EN ISO/IEC 17025:2018. The FEM Diagnostic Laboratory is an official laboratory belonging to this network and obtained Accredia accreditation in 2021.
Gli aspetti fitosanitari, che riguardano la salute delle piante, sono estre -
mamente importanti per le produzioni agricole, l’approvvigionamento
L’accreditamento del Laboratorio di Diagnosi Fitopatologica nel nuovo regime fitosanitario di protezione delle pianteVALERIA GUALANDRI PAOLA BRAGAGNA CHRISTIAN CAINELLI FEDERICO PEDRAZZOLI BIANCA VICELLI GINO ANGELI
di materie prime, la sicurezza alimentare, il patrimonio forestale, gli ecosistemi naturali nonché la tutela della biodiversità.
In uno scenario mondiale caratterizzato da cambiamento climatico e globalizzazione dei mercati, aumentano i fattori di rischio per la salute delle piante. Frenare l’ingresso e limitare la diffusione di organismi nocivi nel territorio dell’Unione Europea (UE) con una diagnosi precoce e un’accurata identificazione diventano obiettivi centrali di una sorveglianza fitosanitaria da parte dei Servizi Fitosanitari. Molteplici sono infatti gli effetti che l’introduzione e l’insediamento di organismi nocivi possono determinare: dalle perdite quantitative e qualitative del raccolto, a costi aggiuntivi di produzione e per le misure di controllo, monitoraggio, contenimento ed eradicazione; così come costi aggiuntivi di raccolto e selezione, di reimpianto, ma anche perdite dovute alla necessità di coltivare piante sostitutive, effetti sulle pratiche di produzione esistenti, effetti su altre piante ospiti nel luogo di produzione, effetti sui profitti dei produttori; modifiche della domanda dei consumatori nazionali o esteri di un determinato prodotto, nonché in ultimo conseguenze sui mercati nazionali e di esportazione, e di conseguenza effetti sull’occupazione. Nel dicembre 2019 con il Regolamento UE 2016/2031 sono entrate in vigore nuove misure di protezione contro patogeni e parassiti delle piante. Il nuovo Regolamento, a sostituzione della Direttiva 2000/29/EC, ridefinisce il nuovo regime fitosanitario con lo scopo di ridurre il rischio di introduzione e diffusione dei patogeni e parassiti di quarantena nel territorio dell’UE. Obiettivo è il rafforzamento del sistema fitosanitario attraverso azioni di prevenzione, identificazione precoce e contrasto a nuovi parassiti nonché aumento/uniformità della vigilanza all’import. Questo a protezione della salute, dell’economia e della competitività del settore della produzione vegetale dell’UE, pur mantenendo una attiva politica di apertura degli scambi commerciali.
A livello nazionale è stato recepito con il Decreto Legislativo N. 19/2021 per permettere l’allineamento al nuovo regime fitosanitario in vigore nei territori dell’UE.
In questo contesto, con il Decreto Ministeriale N. 169819/2022, entrato in vigore il 17 luglio 2022, viene stabilita e regolamentata la Rete Nazionale dei Laboratori, che include i Laboratori Nazionali di Riferimento, i Laboratori Ufficiali e altri laboratori operanti sul territorio nazionale nel settore fitosanitario. Con l’intento di classificare e definire le tipologie di laboratorio che si occupano di diagnostica fitopatologica nel campo della protezione delle piante e descriverne in specifici capi l’identità, le caratteristiche minime, le attività, le modalità di designazione, sospensione e revoca.
Aspetto determinante per i laboratori afferenti alle Rete Nazionale dei Laboratori è la definizione nell’ambito del Reg. UE, del 30 aprile 2022, come data entro la quale i Laboratori Ufficiali devono ottenere l’accreditamento, rilasciato dall’ente preposto Accredia, secondo la norma EN ISO/ IEC 17025:2018 per poter effettuare analisi diagnostiche nell’ambito dei controlli ufficiali e di altre attività ufficiali uniformandosi così ai Laboratori Ufficiali di Diagnostica Fitopatologica della regione EPPO, anch’essi accreditati secondo la norma EN ISO/IEC 17025:2018
Il Laboratorio di Diagnostica Fitopatologica della Fondazione Edmund Mach è riconosciuto come Laboratorio Ufficiale dell’Ufficio Fitosanitario della Provincia Autonoma di Trento. Per conto di questo svolge analisi principalmente su materiale vegetale e terreni per la verifica della presenza di organismi nocivi per l’ambiente agrario e forestale, nell’ambito delle attività di sorveglianza e di monitoraggio del territorio e su piante e materiali vegetali destinati a nuovi impianti e all’esportazione in Paesi terzi.
In tale ambito, il Laboratorio di Diagnostica Fitopatologica della FEM effettua analisi per la rilevazione, identificazione e caratterizzazione
di batteri, funghi, insetti e acari, nematodi, virus, viroidi e fitoplasmi da quarantena e non. L’attività diagnostica spazia dalle tecniche molecolari tradizionali a quelle avanzate. Annualmente migliaia di campioni provenienti dal comparto agricoltura, sia del Trentino che nazionale, a partire dal Servizio Fitosanitario Provinciale, passando per le aziende agricole, i tecnici consulenti operativi sul territorio provinciale e i gruppi di ricerca/sperimentazione della FEM.
Il Laboratorio di Diagnostica Fitopatologica nel 2021 ha ottenuto l’accreditamento ai sensi della norma UNI CEI EN ISO/IEC 17025 dopo un percorso avviato nel 2020, sull’esempio e con il supporto del Laboratorio di Analisi chimiche e microbiologiche della Fondazione Edmund Mach, già accreditato dal 1998.
Le prove che sono state accreditate nel 2021 sono:
• Xyllella fastidiosa su foglie di Olivo con tecnica Real Time PCR
• Virus della Vite (GFLV, GLRV-1 e 3, ArMV, GVA) su floema di vite con tecnica E.L.I.S.A.
• Grapevine flavescence dorée phyto-
plasma su foglie di vite con tecnica Real Time PCR.
Se il territorio nazionale conta un totale di 41 laboratori ufficiali, solo 9 a fine 2021 hanno ottenuto l’accreditamento Accredia e il Laboratorio di Diagnosi Fitopatologica della FEM è uno di questi.
Per il Laboratorio di Diagnostica Fitopatologica l’accreditamento è un risultato che aggiunge valore all’attività analitica, grazie all’attestazione di un ente terzo, Accredia, poiché costituisce un importante passaggio per assicurare tutte le attività in termini di riservatezza, tracciabilità dei dati, preparazione degli operatori coinvolti, uso di strumentazioni adeguate, assenza di conflitto d’interessi. Tutti elementi indispensabili all’interno degli attuali requisiti europei.
Ai fini del mantenimento dell’accreditamento, i tecnici e i tecnologi in esso operanti si impegnano a partecipare a Test Performance Studies (TPS) e Proficiency Test (PT), organizzati dal laboratorio Nazionale di Riferimento, si impegnano ad una formazione continua in campo fitopatologico e allo sviluppo e alla validazione di nuovi protocolli diagnostici.
Le moderne tecnologie di conservazione riducono il naturale decadimento qualitativo delle mele consentendo una maggiore elasticità nelle operazioni di raccolta, nella ricerca di una migliore qualità intrinseca.
ZENI LORENZO TURRINI DARIO ANGELI TOMAS ROMANAs the ripening process progresses, the size, sugar content and red overcolour of apples increase, resulting in a delay in the optimal harvest time in order to obtain better commercial quality. Modern storage technologies such as Dynamic Control Atmosphere (DCA) and treatment with 1-methylcyclopropene (1-MCP) significantly reduce the natural qualitative decay of apples, allowing greater flexibility in harvesting operations than in the past. In the case of the Red Delicious apple, use of these techniques also makes it possible to limit losses due to plant diseases such as superficial scald and to maintain a good level of fruit firmness even after 150 days of storage under a controlled atmosphere. Apples with an advanced degree of ripeness at harvest (starch index >2.5) are suitable for medium to longterm storage only if subjected to treatments with 1-MCP.

La qualità delle mele che arrivano al consumatore finale dipende dall’interazione di diversi fattori (Fig. 1) e l’individuazione dell’epoca di raccolta assume una notevole importanza al fine di produrre mele con caratteristiche qualitative estrinseche ed intrinse-
che ottimali, sia per il pronto consumo che per quello dopo medio/lunga conservazione. Nel caso, per esempio, delle mele Red Delicious, esse raggiungono solitamente il loro massimo equilibrio del gusto, la giusta croccantezza e succosità della polpa
Ottimizzare la qualità delle mele con le nuove tecnologie di conservazioneFABIO
entro marzo o aprile, dopo 7-8 mesi dalla raccolta. L’avvento delle nuove tecnologie di conservazione come il trattamento con gas 1-Metilciclopropene (1-MCP) via aerosol e la gestione dell’atmosfera controllata in modo dinamico (DCA, Dynamic Controlled Atmosphere) hanno aperto nuove strade nella gestione della Red Delicious, garantendo una tenuta della qualità migliore in conservazione e il controllo del riscaldo superficiale, fisiopatia a cui Red Delicious risulta particolarmente sensibile (Foto 1). Tuttavia,
queste tecniche riducono notevolmente il metabolismo dei frutti rallentando il decadimento qualitativo in conservazione (Fadanelli et al. 2013 Acta hort. 2015.1071.96:725-730) e ritardando la degradazione degli amidi in zuccheri semplici e lo sviluppo degli aromi. Pertanto, la qualità della Red Delicious deriva dalla combinazione del grado di maturazione del frutto e dalla tecnologia di conservazione adottata.
Allo scopo di individuare la migliore qualità organolettica e commerciale
Figura 1
Fattori che incidono sulla qualità della mela a fine conservazione
Aspetti(altitudine,pedo-climaticiesposizione, gestione agronomica, andamento climatico, ecc)
Qualità a fine conservazione
Conservazione (modalità e durata)
Foto 1
Red Delicious con sintomi di riscaldo comune

Tabella 1
Tesi a confronto nella prova
per questa varietà, sperimentazioni sono state condotte nel 2018-19 presso il gruppo di post-raccolta della Fondazione Edmund Mach in cui i frutti sono stati raccolti in funzione del loro grado di maturazione in 3 diverse epoche secondo l’indice di degradazione dell’amido (Tab. 1) e sottoposti o meno a trattamenti con 1-MCP. Tutti i frutti sono stati successivamente conservati con tecnica DCA per 150 giorni. Il controllo della qualità organolettica è avvenuto a fine
conservazione attraverso la misurazione del residuo secco rifrattometrico, della durezza e del peso medio dei frutti con il laboratorio automatico Pimprenelle (Setop, Giraud Technologies) su 30 frutti mentre l’acidità titolabile e l’indice di succosità sono stati misurati su un’aliquota di succo estratto dal campione in oggetto. Sugli stessi frutti è stato rilevato anche l’indice di degradazione della clorofilla A (IDA) con l’utilizzo dello strumento non distruttivo DA meter. Le caratteData raccolta
1° raccolto 30/08/2018 2 No Sì
2° raccolto 06/09/2018 2,2 No Sì
3° raccolto 20/09/2018 3,2 No Sì
Figura 2
Box-plot di distribuzione dell’incremento giornaliero di peso della Red Delicious in Trentino misurato nel corso della maturazione (Fonte: test di maturazione in Trentino, n= 675, 8.023 frutti, 39-47 frutteti/anno, parametri misurati su 12 frutti/settimana, da 14 giorni prima della raccolta presunta fino, in alcuni casi, a 28 giorni dopo la raccolta ottimale)
Incremento g-gg
ristiche sensoriali sono state valutate attraverso un panel test con 14 assaggiatori valutando in decimi l’aspetto, la struttura e il sapore delle mele. La qualità estrinseca dei frutti è stata valutata visivamente come percentuale di sovracolore a fine conservazione su 4 casse per singolo raccolto suddividendo la produzione in 4 classi di percentuale di sovracolore rosso: 0-30%, 30-50%, 50-80% e 80-100%, mentre la tinta del sovracolore rosso è stata misurata con colorimetro Minolta nel punto più rosso di 40 frutti per ognuno dei tre raccolti utilizzando lo spazio colorimetrico L*a*b*. Il controllo della presenza di fisiopatie e patologie si è svolto a fine conservazione e dopo 15 gg di shelf life simulata allo scopo di indurre la formazione di riscaldo ed altre fisiopatie e patologie sui frutti.
Le sperimentazioni hanno dimostrato come l’impiego combinato delle due tecnologie consente di ritardare la raccolta delle mele, soprattutto nel caso di condizioni climatiche favorevoli, apportando importanti benefici in termini di qualità senza compromettere la conservabilità del prodotto. Ritardando la raccolta, l’incremento di peso medio dei frutti è stato di 1,15 grammi/frutto/giorno che, considerando un impianto in pie-
na produzione di 4.500 piante/ettaro e 60 frutti/pianta, porterebbe ad un incremento produttivo di 311 kg/ha/ giorno. L’incremento del peso è coerente con i valori della banca dati istituzionale della Fondazione Edmund Mach (min-max: 0,97-2,12 g/gg) realizzata mediamente su 39-47 frutteti di Red Delicious all’anno sparsi su tutto il territorio provinciale durante il periodo 2015-2020, con misurazione di 12 frutti per campione/settimana per 2-7 settimane, ed in particolare, con il dato medio (0,97) rilevato nell’annata 2018 (Fig. 2). Il sovracolore rosso è per la Red Delicious fondamentale per l’apprezzamento da parte del consumatore ed è legato in maniera diretta alla remunerazione per il produttore. In questa prova il frutteto ha beneficiato di temperature favorevoli nel periodo tra il primo e il secondo raccolto; si evidenzia infatti un aumento della percentuale dei frutti con sovra-colorazione rossa >80% della superficie del frutto dall’11,1% del primo raccolto al 51,8% del secondo e al 63,2% del terzo (Fig. 3). Confrontando la qualità organolettica dei frutti la differenza principale che emerge è nella durezza di quelli del raccolto tardivo trattati con 1-MCP che, nonostante il livello di maturazione avanzato, mostravano dei valori net-
Figura 3
Suddivisione delle mele in classi di percentuale di sovracolore (colonne) e misura strumentale della tinta con colorimetro Chroma meter CR-400 Minolta (linea blu). Nella freccia a destra è indicata la corrispondenza tra valori numerici e colori
Valori medi (n=30) dei parametri qualitativi in funzione dell’epoca di raccolta senza alcun trattamento post-raccolta (sinistra) e con 1-MCP (destra).
I punteggi di valutazione con lettere diverse indicano differenze significative secondo il test di Tukey, p<0,05 Figura 5 (C e D)
Panel d'assaggio delle mele senza alcun trattamento post-raccolta (sinistra) e con 1-MCP (destra)con valutazione in decimi (dato medio di 14 assaggiatori).
I punteggi di valutazione con lettere diverse indicano differenze significative secondo il test di Tukey, p<0,05
tamente migliori rispetto ai frutti non trattati (Fig. 4). Il test di Tukey (p<0,05) dimostra come la durezza dei frutti sia significativamente maggiore per tutte le tesi trattate in comparazione alle rispettive tesi non trattate con 1-MCP. Nel panel test le tesi valutate positivamente sono le tesi del 2° raccolto e solo la tesi trattata del raccolto tardivo (Fig. 5). Da evidenziare i valori ridotti del 1° raccolto a causa della pezzatura ridotta, del basso livello di colorazione rossa dei frutti e del minore sviluppo di aromi indotto soprattutto dal trattamento con 1-MCP su mele ancora acerbe come già dimostrato in altri studi di ricerca (Kondo et al. 2005 Postharvest Biol. Technol. 36:61-68). Relativamente alla comparsa di fisiopatie e patologie da conservazione, l’annata 2018 ha visto un clima particolarmente caldo du-
rante il periodo di maturazione della Red Delicious, situazione che può aumentare la suscettibilità al riscaldo comune (Merritt R. H et al. 1961 Proc. Amer. Soc. Hort. Sci. 78:24-34). Tutte le tesi a fine conservazione presentavano comunque una percentuale di frutti sani accettabile (>95%) ad eccezione della tesi non trattata 1-MCP del 3° raccolto sulla quale si evidenzia la presenza di marciumi e riscaldo comune per un totale del 7,2% (Tab. 2). In conclusione, con il progredire del processo di maturazione si è riscontrato un aumento della pezzatura delle mele, del contenuto zuccherino e del sovracolore rosso, che hanno indotto a ritardare il momento ottimale della raccolta al fine di ottenere una migliore qualità commerciale. Le moderne tecnologie di conservazione hanno ridotto notevolmente il natura-
Non trattato 96,4 1,4 0,4 0,0 1,8 0,0
1° Raccolto
2° Raccolto
3° Raccolto
Trattato 98,2 1,1 0,4 0,3 0,0 0,0
Non trattato 95,2 0,4 0,4 0,0 4,0 0,0 Trattato 99,6 0,4 0,0 0,0 0,0 0,0
Non trattato 92,8 3,4 1,3 0,0 2,5 0,0 Trattato 99,1 0,0 0,9 0,0 0,0 0,0
le decadimento qualitativo delle mele consentendo una maggiore elasticità nelle operazioni di raccolta rispetto a quanto accadeva in passato. Nel caso della mela Red Delicious, l’impiego di queste tecniche consente inoltre di

limitare le perdite dovute all’insorgenza di fisiopatie come il riscaldo comune e di mantenere un buon livello di durezza dei frutti anche dopo 150 giorni di conservazione in atmosfera controllata.
Tabella 2 Controllo visivo (n=212-277) di fisiopatie e patologie a fine conservazione (150 giorni)
Lo studio permette di affrontare la difesa della fragola da antonomo con un approccio integrato che tiene conto e valorizza le pratiche agronomiche, come lo sfalcio mirato, le piante trappola e il monitoraggio della popolazione, riducendo la necessità di utilizzare prodotti chimici.

* Collaboratori entomologi
Nel corso degli ultimi anni il coleottero Anthonomus rubi ha manifestato una crescente aggressività nei confronti delle fragole coltivate, l’attività è proseguita anche nel 2021 presso l’azienda privata Zanetti Andrea a Drena. In particolare, l’attività si è concentrata sull’effetto di alcune pratiche di gestione integrata, considerata la scarsa attività dei principi attivi disponibili su fragola. È stato osservato come, nelle condizioni di medio-elevata pressione di popolazione, la pratica dello scuotimento della vegetazione, con la raccolta dei boccioli recisi e degli adulti che cadevano, abbia permesso di ridurre in maniera significativa il danno sulla coltura. L’azienda stessa ha deciso di mettere in pratica questa tecnica di controllo, seppure richieda un elevato
numero di ore di manodopera (circa 1.400 ore/ha).
Altra tecnica integrata di controllo testata è stata la cattura massale, utilizzando trappole adesive gialle combinate con attrattivi specifici che, pur essendo efficaci nell’attirare l’insetto per un’azione di monitoraggio, non si sono dimostrate altrettanto efficaci nell’azione di cattura massale. Questa ridotta efficacia è però probabilmente dovuta all’elevato livello di popolazione presente e quindi sarebbe necessario utilizzare un numero notevole di trappole, non risultando economicamente sostenibile. Inoltre, non manifestando selettività nei confronti della entomofauna utile, sono difficilmente proponibili.
Durante la stagione 2021 si è valutato il ruolo delle fioriture di piante
spontanee presenti sotto il fuorisuolo, osservando il ruolo importante del tarassaco come pianta nutrice per l’antonomo. Per questo si è provato a gestire la fioritura del tarassaco con lo sfalcio, a confronto con situazioni non sfalciate e, pur osservando una presenza significativamente minore nei tunnel sfalciati (da 23 a 8 adulti su 100 piante di fragola), questo non è stato sufficiente per ridurre in modo altrettanto efficace e persistente il danno sulla coltura. Andrà comunque approfondita la tecnica della manipolazione del cotico per capirne meglio l’importanza nel comportamento dell’insetto.
Un’ulteriore osservazione è condotta sul ruolo delle rose ornamentali in seguito al rilievo della presenza di


antonomo, inserendole come piante-trappola nei pressi della coltivazione. Si è rilevata un’ampia variabilità nella infestazione delle diverse varietà di rose, ma in alcuni casi si sono raggiunte percentuali del 90-100% di infestazione. Questi dati incoraggianti andranno approfonditi nei prossimi anni, con la crescita dei cespugli di rose, ma una osservazione fondamentale è che dai boccioli recisi di alcune varietà di rosa non si sviluppano gli adulti, fungendo quindi da vera e propria pianta trappola per ridurre la popolazione.
È proseguita la ricerca di parassitoidi per valutare le possibilità offerte dalla lotta biologica contro antonomo, per poter operare il controllo dell’insetto a livello di agro-ecosistema.
Foto 1
Foto 1
Il controllo biologico mira a ridurre le popolazioni del carpofago che si sviluppano a spese di specie ospiti spontanee negli ambienti naturali marginali. Di conseguenza, l'intensità delle invasioni nelle coltivazioni ed il ricorso agli insetticidi per la loro gestione, saranno più contenuti.
Controllo biologico di Drosophila suzukii mediante rilasci del parassitoide Ganaspis brasiliensis

Foto 1
Adulto e pupa di D. suzukii su mirtillo
I rilasci di Ganaspis brasiliensis (Ihering) sul territorio provinciale sono stati effettuati tra fine agosto e fine ottobre 2021 in 12 località in Valsugana (siti di Vigalzano, Costasavina, S. Vito, Castelnuovo e Samone), Valle dei Mocheni (sito di Mala), Altopiano di Pinè (sito di Bedollo/loc. Piazze), Valle dell’Adige (siti di S. Michele a/A, Trento/loc. S.Rocco, Trento/parco Gocciadoro e Aldeno) e in Vallagarina (sito di Taio di Nomi) (Foto 2). I siti monitorati si trovavano a vari livelli altitudinali, caratterizzati quindi sia da componenti vegetazionali specifiche sia comuni, ma con diversa epoca di fruttificazione. Seguendo uno specifico protocollo messo a punto da un tavolo di lavoro nazionale, tutti i siti sono stati soggetti a monitoraggio pre e post-rilascio.
Queste attività avevano l’intenzione di escludere l’eventuale presenza di G. brasiliensis sul territorio trentino prima della sua introduzione, accertarne l’insediamento a seguito dei rilasci e valutare possibili interazioni con organismi autoctoni non bersaglio (in particolare Ditteri appartenenti alla famiglia dei Drosophilidae ed il complesso dei loro parassitoidi indigeni). In ciascun sito i monitoraggi sono stati condotti campionando la frutta in pianta e da terra naturalmente presente nell’area. Il numero di punti di campionamento e la durata del periodo di monitoraggio erano variabili da sito a sito in funzione della disponibilità stagionale di frutta. Nel complesso, le attività in pre-rilascio hanno evidenziato la presenza di 5 specie di
drosofila e di 7 specie di parassitoidi sfarfallate dal materiale campionato. Dalla frutta in pianta non è stato ottenuto alcun parassitoide mentre Drosophila suzukii (Matsumura) è stata l’unica specie di drosofila rilevata. Dalla frutta campionata a terra D. suzukii e Drosophila melanogaster Meigen sono state le specie dominanti seguite da Drosophila simulans Sturtevan, Drosophila immigrans Sturtevan e Drosophila subobscura Collin, mentre per quanto riguarda i parassitoidi sono stati rilevati tre parassitoidi pupali autoctoni (Trichopria cf drosophilae Perkins, Pachycrepoideus vindemiae Rondani e Vrestovia fidenas (Walker)), tre parassitoidi larvali autoctoni (Asobara tabida Nees, Leptopilina boulardi Barb et al. e Leptopilina heterotoma Thomson) ed un parassitoide larvale esotico (Leptopilina japonica Novković & Kimura) già segnalato da tecnici della FEM per la prima volta in Italia nel 2019. Nessun esemplare di G. brasiliensis è stato rilevato dai monitoraggi condotti in pre-rilascio. Al contrario, i monitoraggi effettuati a seguito della liberazione del parassitoide esotico hanno permesso di confermare l’avvenuto insediamento di G. brasiliensis nel 50% dei siti: S. Vito, Costasavina, Pinè e Trento/loc. S.Rocco, S. Michele a/A e Taio di Nomi. Il parassitoide è emerso solo da frutti
raccolti in pianta ed infestati esclusivamente da D. suzukii, confermando la sua specificità nei confronti del moscerino asiatico dei piccoli frutti. Nei 6 siti nei quali è stato rinvenuto dopo il rilascio, un totale di 89 individui sono sfarfallati da rovo selvatico (Rubus ulmifolius Schott), frangola (Rhamnus frangula Mill.) e sambuco (Sambucus nigra L.) tra le principali essenze campionate.
I monitoraggi post-rilascio hanno evidenziato la presenza delle stesse specie di drosofila e di parassitoidi campionati in pre-rilascio. D. suzukii è risultata essere la specie dominante (più del 97% degli individui) tra quelle di drosofila sfarfallate a seguito dell’incubazione della frutta campionata.
Per quanto riguarda i parassitoidi, tutte le altre specie sono state ottenute solo da campioni di frutta raccolta a terra, ad esclusione di L. japonica, emersa sia dalla frutta raccolta in pianta che dalla frutta raccolta a terra (Fig. 1).
In provincia di Trento le evidenze raccolte attraverso il monitoraggio dei siti di rilascio sembrano confermare che il parassitoide è uno specialista nei confronti di D. suzukii, che la parassitizzazione avviene su stadi di sviluppo precoci dell’ospite (larve L1 ed in parte L2) e su frutta ancora

Foto 2
Individui di Ganaspis brasiliensis al momento del rilascio
Figura 1
Composizione percentuale delle specie emerse dai campioni raccolti a S. Vito (Valsugana), sito di maggiore insediamento di Ganaspis brasiliensis nel corso dell’attività 2021
Foto 3
Tipico ambiente naturale (rovo selvatico) ai margini delle coltivazioni dove vengono concentrati i rilasci di Ganaspis brasiliensis

in pianta. Nel complesso, queste caratteristiche suggeriscono un elevato grado di separazione spaziale e temporale dell’attività di parassitizzazione di G. brasiliensis con quelle delle altre specie di parassitoidi, ad eccezione forse dell’altro esotico L. japonica
Questo comporterebbe un impatto pressoché nullo di G. brasiliensis sui parassitoidi autoctoni larvali, la cui attività di parassitizzazione verso D. suzukii è già compromessa dalla forte risposta immunitaria innescata da quest’ultima.
Some 18 years have passed since Melinda decided to undertake the path towards product certification (initially EurepGAP, subsequently GLOBALG.A.P.) in its member orchards. In the years that followed a number of important producers in the province joined the certification programme: La Trentina, Sant’Orsola, Consorzio Valli Trentine, Levico Frutta and approximately 30 producers that do not belong to the cooperative. Product certification is based on compliance with and verification of Integrated Production Regulations for the various crops, a process that laid the foundations for greater sustainability in the fruit farming sector.
Sono trascorsi 18 anni da quando l’Organizzazione di Produttori Melinda ha deciso di intraprendere il percorso della certificazione di prodotto nelle aziende frutticole associate. Nel 2005 lo standard di certificazione era denominato “EurepGAP”. Il motivo di questa scelta? Le Cooperative frutticole delle Valli del Noce risultavano già accreditate secondo la norma
ISO 9001 ma era assente la certificazione di base, quella dei produttori, indispensabile per chiudere il cerchio dell’intera filiera frutticola. Inoltre diventavano sempre più pressanti le richieste, specialmente da parte della Grande Distribuzione Organizzata, di poter disporre di produzioni agricole certificate, peculiarità da aggiungere a marchi già affermati sul mercato
I Disciplinari di Produzione Integrata delle varie colture, la certificazione GLOBALG.A.P. ed i suoi moduli aggiuntivi hanno posto le basi per una coltivazione frutticola sostenibile e sempre più rispettosa dell’ambiente, pur garantendo l’ottenimento di prodotti di alto livello qualitativo.

per una ulteriore valorizzazione a livello nazionale ed europeo. Negli anni immediatamente successivi hanno aderito al percorso di certificazione altre importanti realtà cooperative provinciali: La Trentina, Sant’Orsola, Consorzio Valli Trentine (oggi Società Frutticoltori Trento), Levico Frutta (oggi compresa in La Trentina) e circa 30 aziende non inserite nel contesto della cooperazione. La scelta della certificazione del prodotto, oltre ad essere dettata da motivazioni di carattere prettamente commerciale, rappresenta un’opportunità di crescita professionale dei principali interpreti della filiera frutticola. Infatti, già con le prime versioni, lo standard introduceva precisi e chiari riferimenti ai Disciplinari di Produzione Integrata ed alla loro fondamentale importanza: la tutela dell’ambiente, l’impiego razionale ed oculato dei prodotti fitosanitari, fino a promuovere la formazione e l’aggiornamento costante dell’agricoltore, visto come attore principale del settore. EurepGAP proponeva una linea di criteri base idonei ad integrare ed a fare interagire tutti questi importanti temi già esistenti ma, per alcuni aspetti, gestiti singolarmente e non sinergicamente, mirando al progressivo raggiungimento di produzioni
frutticole maggiormente sostenibili. In merito allo standard EurepGAP va ricordato come, per la prima volta a livello mondiale, fu applicato in alcune aziende agricole coltivatrici di prodotti ortofrutticoli in Senegal ed in Perù su indicazione di alcune note catene commerciali multinazionali operanti nel settore agricolo. Questo standard di certificazione si è evoluto nel tempo: la successiva denominazione GLOBALG.A.P, tuttora in uso, risale all’inizio dell’anno 2008. Nuovi aggiornamenti sono stati introdotti periodicamente e nel 2022 entrerà in vigore l’ultima versione 6.0 con aspetti più approfonditi inerenti la tutela ambientale e l’ottenimento di produzioni agricole sostenibili. Durante la fase di partenza sono stati organizzati corsi specifici sulla tematica, dedicati a frutticoltori, con l’intento di analizzare e spiegare tutti gli oltre duecento punti di controllo dello standard. Molti di questi requisiti risultavano già ampiamente soddisfatti grazie all’adesione ai Disciplinari di Produzione Integrata delle varie colture, dal melo al ciliegio, dalla fragola ai piccoli frutti. La risposta degli agricoltori coinvolti si è dimostrata positiva per quanto concerne l’ottemperanza ai requisiti pratici: stoccaggio in sicurezza dei prodotti fitosanitari, uso dei di -

spositivi di protezione individuale, precisione e cura nella compilazione del registro dei trattamenti, mentre sono sorte le perplessità inerenti la tenuta ed il periodico aggiornamento della documentazione aziendale, il cosiddetto “Faldone”. Questa incombenza è vista tuttora come un laborioso e poco gradevole compito burocratico, ma ogni tipologia di certificazione si fonda sui principi cardine dell’evidenza visiva e delle prove documentali. Pertanto, pur comprendendo l’aggravio determinato dalla necessità di effettuare le registrazioni aziendali (manutenzione macchinari ed attrezzature, formazione dei collaboratori, procedure igieniche, ecc.), risulta essenziale dimostrare di essere adempienti anche nei confronti di questi requisiti, molti dei quali obbligatori per legge. Attualmente, quando si parla di sostenibilità nel comparto agricolo, è fondamentale dimostrare di usare macchine destinate all’applicazione dei prodotti fitosanitari perfettamente efficienti (tarature e manutenzioni) o la cura dell’igiene durante tutte le fasi di manipolazione della frutta, solo per citare alcuni esempi. L’Unità Certificazioni Agroalimentari e Ambientali ha fornito fin dall’inizio e continua a fornire consulenza tecnica specialistica a tutte le aziende frutticole inserite nel percorso della certificazione di prodotto e dei suoi moduli aggiuntivi oggi principalmente richiesti a corredo: GLOBALG.A.P. Risk Assessment on Social Practice (GRASP per il welfare) e Food Sustainability Assessment (FSA per la sostenibilità).
Sono disponibili, comunque, altri moduli aggiuntivi per il settore ortofrutticolo: Coop Italia, Spring (gestione razionale delle acque irrigue) e il più recente modulo fondato sulla tutela delle biodiversità (Biodiversity V1.0).
L’attività di consulenza e supporto tecnico viene svolta sia per le aziende singole, sia per quelle associate. Il controllo finale per la conferma del mantenimento delle certificazioni oppure per il loro primo ottenimento viene effettuato da Enti di Certificazione accreditati.
Dato che le certificazioni di prodotto applicabili nel comparto ortofrutticolo si basano essenzialmente sui Disciplinari di Produzione Integrata delle varie colture (parte agronomica e parte difesa fitosanitaria) e sulle leggi vigenti nello Stato in cui esse si applicano (ad es. Testo Unico Sicurezza nei luoghi di lavoro, Piano di Azione Nazionale per l’uso sostenibile dei prodotti fitosanitari, Accordi provinciali come la gestione qualiquantitativa delle acque destinate al comparto agricolo, lo smaltimento dei contenitori vuoti dei fitofarmaci) si ritiene impossibile una regressione nel percorso delle certificazioni della produzione agricola poiché queste hanno posto le basi sulle quali lavorare per una migliore sostenibilità nel comparto frutticolo. Tuttavia la complessità gestionale richiesta (soprattutto burocratica per la tenuta della documentazione aziendale) renderà sempre più necessaria la costante e capillare consulenza specialistica alle aziende agricole inserite in questo percorso strategico.
The 2021 grape harvest was characterised by below-average production, with 1,096,051 q of grapes, a value similar to that of 2012, but with average qualitative levels. Heavy rain in late April favoured the first downey mildew infections. Thanks to the warm and dry weather in June, there was little bunch damage. On the valley floor and in the early production areas, the July rains brought attacks mainly on the leaves, whereas in the colder areas there were significant attacks also on the bunches. As far as powdery mildew is concerned, the fungus developed to some extent in the hillside areas in June and attacks were also recorded on the bunches of susceptible cultivars in favourable areas such as dry and windy hillsides. The Flavescence Dorée vector, Scaphoideus titanus, was present throughout the province in high quantities, although less than in the previous two years, as was the Flavescence Dorée disease, which nevertheless remains above the warning level. Awareness regarding the extirpation of symptomatic grapevines remains a matter of paramount importance.
Il 2021 in viticoltura sarà ricordato come un’annata con produzione inferiore alla media, ma con livelli qualitativi nella media, a causa delle condizioni meteo non del tutto favorevoli in prossimità della vendemmia. La produzione si è attestata su 1.096.051 q di uva, valore simile a quanto prodotto nel 2012, attestandosi tra i valori più bassi.
La proporzione tra uve a bacca bianca (76%) e a bacca rossa (24%) conferma l’inesorabile incremento delle cultivar bianche a scapito di quelle rosse.
Il germogliamento è iniziato molto in ritardo rispetto alla media di ben 12 giorni e la percentuale di germogliamento non è stata buona: il valore misurato è inferiore alla media e simile a quanto registrato nel 2012, fenomeno tipico in annate dove gli inverni sono stati rigidi. La fertilità reale misurata è stata medio-bassa e il ritardo fenologico si è confermato anche alla fioritura, con 11 giorni di ritardo. Questo trend è proseguito all’invaiatura e fino alla vendemmia che, per le basi spumante, è iniziata dopo il 30 agosto.
Per quanto riguarda la situazione fitosanitaria, le principali malattie comparse nel 2021 sono riassunte di seguito.
Peronospora: nel 2021 la piovosità di fine aprile è stata preparatoria alle
prime infezioni che si sono verificate a maggio. Il mese di giugno, caldo e asciutto, ha richiesto una difesa molto blanda e di conseguenza pochi danni ai grappoli. A luglio sono riprese con intensità le piogge che hanno determinato nei fondovalle e nelle zone precoci attacchi soprattutto sulle foglie, mentre in alta collina e nelle zone più fredde si sono riscontrati discreti attacchi anche sui grappoli. Ad agosto si riscontravano frequentemente casi di peronospora sulle foglie delle femminelle con importante caduta delle stesse e ridotta azione fotosintetica. Oidio: il fungo dell’oidio è comparso ed ha avuto un certo sviluppo nelle zone di collina nel mese di giugno. I testimoni non trattati hanno registrato ingenti attacchi. In alcune situazioni si sono registrati attacchi anche sui grappoli in cultivar sensibili di zone favorevoli come le colline asciutte e ventilate.
Botrite: la comparsa della botrite si è verificata a luglio, con i grappoli in via di maturazione. Al 5 agosto la situazione era preoccupante, fortunatamente le condizioni di agosto e settembre ne hanno ridotto l’incidenza sui grappoli.
Marciume acido: è stata riscontrata la presenza di marciume acido sulle cultivar a grappolo compatto.
Escoriosi: si sono manifestati pochi problemi, solo su alcuni vigneti, ma la malattia è in aumento.
Black rot: questo fungo sta rappresentando un problema serio, con parziale perdita di produzione in alcune vallate più umide, come la Valsugana, sulle cultivar tolleranti alle principali malattie fungine. Si ritrova anche su cultivar tradizionali come Chardonnay. Il fungo ha tratto vantaggio per il suo sviluppo dalle condizioni umide del mese di luglio. Per combattere questa patologia è stato necessario effettuare due/tre interventi da inizio fioritura a prechiusura grappolo. Mal dell’esca: la patologia, per quanto risulta dai monitoraggi effettuati, è in aumento, anche se in valori assoluti è inferiore al 2020. Le cultivar più sensibili sono Nosiola, Cabernet Sauvignon, Incrocio Manzoni, Traminer aromatico e Sauvignon bianco. Tignole: si conferma l’efficacia della confusione sessuale nel controllo delle tignole. Pochi problemi si sono riscontrati anche nei vigneti ritenuti più problematici.
Giallumi della vite: il monitoraggio sul vettore della Flavescenza Dorata Scaphoideus titanus ha stabilito che l’insetto è presente su tutto il territorio provinciale con presenza quantitativa molto elevata, anche se in riduzione rispetto alle due annate precedenti. Sono stati consigliati su tutto il territorio provinciale tre trattamenti insetticidi. Anche la presenza della malattia Flavescenza Dorata è stata riscontrata sull’intera provincia, con numeri che nel 2019 hanno raggiunto un livello soglia di guardia elevato e si sono confermati nel 2020. Nel 2021 l’incidenza è in leggera riduzione. È sempre fondamentale la sensibilizzazione del viticoltore verso l’estirpazione delle viti sintomatiche. Anche il legno nero è presente in forma endemica.
Cocciniglie: la presenza della cocciniglia Planococcus ficus si ritrova su tutto il territorio provinciale, con problematiche che sono state meno rilevanti rispetto agli ultimi anni. Il lancio di insetti utili e la confusione sessuale in alcune zone hanno dato ottimi risultati.
Fillominatori: le due specie Phyllocnistis vitegenella e Antispila oinophylla sono presenti su tutto il territorio provinciale, ma la loro presenza numerica è in riduzione.
Drosophila suzukii: la presenza di questo dittero su vite ha confermato come l’uva sia un ospite secondario.
A parte la Schiava, che ha la buccia più sottile e quindi è più sensibile, si riscontra qualche segnalazione su Cabernet Sauvignon e altre varietà in sovramaturazione. Si conferma la difficoltà del drosofilide a schiudere e a completare il ciclo su uva.

Erinosi: è stabile la presenza di questa patologia causata dall’acaro eriofide Colomerus vitis. Al momento i trattamenti a base di zolfo hanno un effetto collaterale e sono sufficienti per il suo contenimento.
Acari: si segnala l’aumento di casi in cui la presenza di acaro giallo è significativa ed in costante aumento. Il controllo degli acari predatori non è così efficace come nel passato: le cause di questa nuova pullulazione non è riconducibile solo ad un unico fattore, ma all’interazione tra le condizioni climatiche e le strategie di difesa fungicida e insetticida adottate.
GPGV: la sintomatologia riconducibile a GPGV nei vigneti di Pinot grigio e Traminer è in regresso su tutto il territorio provinciale. I nuovi impianti messi a dimora non presentano sintomatologie significative.

In 2021, the results of several years of monitoring and experimental work carried out on diseases associated with grapevine phytoplasmas and insect vectors were presented. An extensive molecular analysis (PCR) study was carried out between 2016 and 2020 to investigate the presence of Flavescence Dorée in specimens of Scaphoideus titanus collected in vineyards under varying epidemic pressure. The results showed that the insect positivity rate varies depending on the situation: under “high” pressure the average rate was 26.2%, with a maximum of 58.6%. This study confirms the key role played by S. titanus in Trentino in spreading the disease in vineyards in the late summer. Another objective was to analyse the diffusion and density of the population of S. titanus and other potential leafhopper and planthopper vectors of phytoplasma: the study showed that S. titanus was present in almost all the sites monitored, with generally substantial populations, whereas the other species were observed with low densities and limited diffusion.
Nel 2021 sono stati elaborati e presentati i risultati di lavori pluriennali di monitoraggio e di sperimentazione eseguiti nell’ambito delle malattie associate ai fitoplasmi della vite e degli insetti vettori (VIII Incontro Nazionale sui Fitoplasmi e le Malattie da Fitoplasmi, Giornata tecnica della vite e del vino di S. Michele all’Adige). Un’estesa indagine di analisi molecolari (PCR) è stata effettuata tra il 2016 e il 2020 per verificare la presenza del fitoplasma della Flavescenza dorata (FD) in individui di Scaphoideus titanus, il principale insetto vettore della malattia, raccolti in vigneti a diversa pressione epidemica (Gelmetti et al.
2021 INFitoplasmi 2021:32). Lo scopo era di valutare il potenziale ruolo dello stadio di adulto della cicalina nel trasmettere la pericolosa malattia da quarantena nell’ambiente viticolo trentino. Gli insetti sono stati prelevati nel periodo di fine estate in 49 vigneti in cui era nota la loro densità di popolazione ed era monitorata la presenza di viti malate. L’indagine ha preso in considerazione, nelle diverse annate, il periodo di fine agosto-inizio settembre, una fase potenzialmente critica per l’epidemiologia della FD (picco di volo dell’insetto, stadio adulto con capacità di compiere spostamenti, massima concen -
Fitoplasmi della vite ed insetti vettori: attività di monitoraggio e sperimentazioni
trazione del fitoplasma nei tessuti ed alta efficienza di acquisizione del fitoplasma da parte della cicalina). Gli insetti da analizzare sono stati catturati vivi tramite la tecnica del frappage eseguita sulla chioma delle viti mediante l’utilizzo di un battitore e un retino raccoglitore. Le indagini molecolari, eseguite secondo un protocollo interno presso il Laboratorio di Diagnostica fitopatologica FEM, hanno interessato un totale di 2.087 individui adulti di S. titanus analizzati singolarmente. I risultati hanno evidenziato che il numero di impianti con individui risultati infetti e il tasso di positività degli insetti varia a seconda della situazione epidemica della FD nel vigneto. Nelle aree con pressione della malattia “bassa” (nessuna presenza di piante sintomatiche e bassa presenza di casi di FD in quell’area) sono stati prelevati insetti da 17 vigneti per un totale di 842 individui. Solo in un campione è stata riscontrata la positività a FD e, nello specifico, solo a carico di un individuo tra i 179 catturati in quel sito (0,6%). Nei 16 impianti a pressione “media” (sotto l’1% di piante malate) sono stati ritrovati esemplari infetti nel 63% dei campioni con un tasso di positività generalmente contenuto: in 8 vigneti era compreso tra l’1 e il 5,9%, in 2 siti però ha raggiunto valori relativamente alti, 12,5 e del 25%. Nelle situazioni a pressione “elevata” (molte piante sintomatiche in aree focolaio) in 15 campioni su 16 sono stati trovati adulti di S. titanus
positivi a FD e con un tasso medio del 26,2%. Le unità produttive in cui sono stati riscontrati i livelli più alti di individui potenzialmente infettivi (dal 38,2 al 58,6%) erano tutte caratterizzate da un’incidenza delle viti sintomatiche superiore al 20% (Fig. 1). Questo lavoro conferma quindi il ruolo di primaria importanza che può avere S. titanus in Trentino nella diffusione della malattia all’interno dei vigneti nella fase di fine estate. Contributi interessanti per l’epidemiologia di FD sono derivati anche dai risultati del monitoraggio pluriennale eseguito con trappole dislocate in una rete fissa di 101 vigneti distribuiti in tutte le principali aree vitate provinciali (Gelmetti et al. 2021 INFitoplasmi 2021: 33). Sono state analizzate le catture registrate annualmente, dal 2018 al 2020, su trappole cromotropiche adesive (modello “Glutor giallo” di Biogard®, 10x25 cm, posizionate verticalmente al centro del vigneto, attaccate al filo di banchina) esposte da inizio luglio fino all’inizio di novembre e sostituite ogni 14 giorni. L’obiettivo era di valutare la diffusione e la densità di popolazione di S. titanus e di altre cicaline potenzialmente vettrici del fitoplasma: Orientus ishidae, Dictyophara europaea e Phlogotettix cyclops. In tutti i vigneti è stata eseguita la difesa insetticida per la lotta obbligatoria alla FD: nel 72% dei casi con sostanze attive utilizzabili in agricoltura integrata e nella restante quota con insetticidi a base di piretro; nel 2018 e nel 2019 generalmente
Foto 1
Adulto di S. titanus

Test di Kruskal-Wallis p=0,05
Figura 1
Percentuale di insetti adulti di S. titanus risultati positivi all’analisi molecolare (PCR). Analisi statistica: Test di Kruskal-Wallis p=0,05
Figura 2
Andamento delle catture degli adulti di S. titanus dal 2018 al 2020, dati medi di 101 postazioni di monitoraggio con trappole cromotropiche
Figura 3
Percentuale (media, minima, massima) di piante con sintomi di fitoplasmosi rilevate in 9 vigneti in tre diverse epoche di controllo: inizio luglio, inizio agosto e inizio settembre
con un intervento insetticida nel periodo post-fiorale della vite, mentre nel 2020 con due interventi insetticidi, sia in viticoltura biologica che in quella integrata. L’indagine ha evidenziato che S. titanus era presente nella quasi totalità dei siti monitorati e che le densità di popolazione erano generalmente importanti: la porzione di postazioni che ha fatto registrare più di 10 catture per stagione è stata, nei tre anni, mediamente il 77%, mentre quella con più di 100 è stata il 23%. Il volo dell’insetto ha avuto un andamento simile nei tre anni di osservazione, con un picco rilevato nel periodo tra il 5 e il 18 agosto, mese in cui si registrano il 50% delle catture totali annuali. Le osservazioni hanno dimostrato che nell’ambiente trentino la presenza degli adulti è molto prolungata e in alcuni casi può protrarsi fino alla fase immediatamente precedente alla caduta delle foglie delle viti, con una durata del volo, quindi, di circa 18 settimane (Fig. 2). Per le altre specie potenzialmente vettrici di FD che vivono su vegetazione esterna al vigneto e/o sulle erbe dell’interfilare sono state ritrovate, in generale, basse densità di popolazione e una
diffusione abbastanza limitata nei vigneti. Livelli di catture più rilevanti sono stati registrati a carico di O. ishidae (23% dei siti); l’insetto si conferma avere un ciclo biologico molto simile a quello di S. titanus, sebbene anticipato. Per D. europaea e P. cyclops la maggior parte dei ritrovamenti sono costituiti da singole e sporadiche catture avvenute nell’arco della stagione in un numero limitato di postazioni (10%) sparse nei vari distretti viticoli della provincia.
Osservazioni preliminari eseguite nel corso del 2021 all’interno di un progetto pluriennale di monitoraggioche interessa la zona viticola che si sviluppa tra Mori Sano e Brentonico Castione - hanno dimostrato che la comparsa dei sintomi su vite delle fitoplasmosi è scalare nel corso della stagione (Gelmetti et al. 2021 14° GTVV Atti delle GT: 4). In 9 vigneti in cui è stata accertata la presenza di FD o di entrambe le fitoplasmosi (con un’incidenza media del 3%) le ispezioni visive ripetute in diverse epoche hanno confermato che in quelle condizioni in media 2/3 del totale delle piante sintomatiche erano visibili entro inizio agosto (Fig. 3).

La Fondazione Mach è impegnata da decenni nella formazione obbligatoria per gli agricoltori al fine di ottenere o rinnovare l’abilitazione per l’acquisto e uso o per la vendita dei prodotti fitosanitari o, negli ultimi anni, per l’attività di consulenza (“patentino”). Nel 2015 la revisione normativa introdotta dal PAN (Piano di Azione Nazionale sull’uso sostenibile dei prodotti fitosanitari) ha modificato i requisiti dei corsi di formazione necessari per ottenere o rinnovare le abilitazioni, in termini di durata e di materie trattate. È quindi stato necessario attivare un nuovo sistema di corsi di formazione e, da allora, FEM ha organizzato più di 300 corsi per un totale di oltre 16.000 partecipanti.
Nel 2021, dopo lo stop forzato del 2020 a causa della pandemia, si è scelto, grazie alla possibilità intro-
dotta dalla normativa provinciale (Delibera GP n. 1965 del 27 novembre 2020), di offrire tali corsi in modalità “formazione a distanza” (FAD) attraverso un’apposita piattaforma informatizzata implementata da FEM. L’agricoltore quindi, collegandosi dal proprio pc o tablet, partecipa alle videolezioni che compongono il corso (della durata complessiva di 12 ore nel caso dei rinnovi e 20 nel caso del nuovo rilascio), realizzate da oltre 20 tecnici e tecnologi esperti nelle varie tematiche e colture. Ogni lezione, di circa 30 minuti, presenta alla fine una domanda per verificare e tracciare la partecipazione e il corso è accessibile tutti i giorni, 24 ore su 24, per favorire l’apprendimento in modo autonomo e personalizzato. In poco più di un anno, hanno frequentato i vari corsi oltre 4.500 utenti, esprimendo gradimento positivo
CANDIOLI MICHELA DALPIAZ ARIANNA TOMASILa formazione specialistica in materia di prodotti fitosanitari e corrette modalità di utilizzo e la conoscenza sempre aggiornata delle avversità è un requisito fondamentale per l’ottenimento di produzioni agricole sostenibili.
nel 95% degli oltre 3.600 questionari compilati on-line. Negli ultimi anni, la normativa provinciale ha anche introdotto la possibilità di ottenere dei “crediti formativi”, riconosciuti dal Servizio preposto PAT, partecipando ad eventi formativi o incontri tecnici, che sono validi ai fini del rinnovo del patentino per utilizzatore professionale. Dal 2015 FEM organizza e svolge l’aggiornamento dei frutticoltori afferenti ad APOT attraverso corsi di formazione della durata di 3 ore che vedono la partecipazione di circa 3.800 agricoltori all’anno. Al raggiungimento dei 12 crediti (12 ore) e in base alle materie trattate (Aggiornamento normativi, Tutela dell’ambiente, Salute e Difesa delle colture) accumulate nei 5 anni di validità, vedranno rinnovato il patentino in automatico. In questo modo è possibile coniugare le necessità formative e di aggiornamento dei frutticoltori in materia di prodotti fitosanitari, nuove avversità emergenti, novità normative, con l’opportunità di ottenere contestualmente il rinnovo del patentino,
rappresentando un processo di “formazione permanente”.
L’attestazione della partecipazione al percorso formativo è tracciata per ogni agricoltore nella sua area personale, presente sul sito FEM ed accessibile con le proprie credenziali. In caso l’agricoltore abbia necessità di rinnovare il patentino e non abbia raggiunto i crediti sufficienti potrà completare il percorso formativo attraverso specifici corsi di completamento, sempre online, o in presenza in aula. Allo stesso modo vengono gestiti a livello informatizzato anche i crediti dei soci afferenti al gruppo Cavit e Mezzacorona, ottimizzando in molti casi i crediti accumulati nelle diverse iniziative.
Nel 2021 inoltre è stata attivata un’ulteriore piattaforma per webinar, per l’erogazione dei corsi di aggiornamento annuale dei frutticoltori organizzati in collaborazione con APOT. Nel primo anno di utilizzo, oltre 2.600 frutticoltori si sono collegati online nell’ambito delle 50 edizioni del corso organizzate.

Nella percezione della qualità aromatica del vino intervengono centinaia di molecole. Alcune di esse, tuttavia, giocano un ruolo sensoriale preponderante e sono in grado di evocare nel degustatore sentori specifici, anche se presenti a concentrazioni ridottissime, di qualche parte per trilione. Tra queste si trovano i tioli volatili, piccole molecole solforate il cui aroma ricorda il bosso o il pompelmo e che caratterizzano l’aroma dei vini di alcune varietà, principalmente il Sauvignon Blanc, ma che giocano altresì un ruolo importante nel profumo di altri emblematici vini prodotti nel Trentino come il Müller Thurgau (Carlin et al. 2022 Food Res. Int. 157: 111404) o il Gewürztraminer (Román et al. 2018 Eur. Food Res. Tech. 244(3):379-386).
I tioli volatili presenti nel vino provengono principalmente da molecole non aromatiche accumulate durante la maturazione nei diversi tessuti nell’uva sotto forma di precursori non aromatici (Nicolini et al. 2020 Vitis 59(4):149-153), principalmente nelle cellule della buccia (Roman et al. 2016 Food Chem. 207:16-19.), per cui la gestione da parte dell’enologo delle fasi prefermentative è di particolare importanza per il raggiungimento della potenziale qualità del vino finito. Tra
queste, bisogna mettere in evidenza la macerazione pellicolare, che consente di raddoppiare la concentrazione dei precursori nel mosto (Nicolini et al. 2017 40th OIV Congress 360-362; Fig. 1). Questa tappa del processo produttivo comporta tuttavia una serie di rischi dovuti allo sviluppo di microrganismi indesiderati e/o all’azione incontrollata di alcuni enzimi naturalmente presenti nell’uva che possono deteriorare la qualità del vino. Per questi motivi, si è indagato il potenziale utilizzo di un nuovo approccio tecnologico recentemente approvato dall’OIV nell’estrazione dei precursori tiolici: gli ultrasuoni ad alta potenza. I risultati ottenuti, oltre a confermare l’efficacia della tecnica (Celotti et al. 2018 32nd EFFoST Int. Conf. P02.073), hanno permesso inoltre di evidenziare la possibile interazione di queste onde sonore con i precursori dei tioli, portando alla liberazione delle molecole aromatiche (Roman et al. 2020 Foods 9(1):104). Questi risultati suggeriscono nuove possibilità di aumentare l’intensità dell’aroma tropicale dei vini attraverso specifici protocolli di vinificazione. Anche la gestione delle frazioni di pressatura dell’uva consente di incrementare sostanzialmente la concentrazione di precursori nel mosto.
TOMAS ROMAN ADELAIDE GALLO NICOLA CAPPELLO GIORGIO NICOLINI LORIS TONIDANDEL ALICE BARBERO ROBERTO LARCHERFigura 1
Effetto della macerazione prefermentativa a freddo con o senza enzimi sul contenuto di precursori tiolici nel mosto (somma molare di GSH-3MH e Cys-3MH; n=9)
Figura 2
Evoluzione dei precursori tiolici (GSH-3MH; Cys-3MH) nel mosto durante due diversi cicli di pressatura industriale
Tabella 1
Concentrazione media e deviazione standard (n=6) dei tioli volatili nei vini prodotti con 4 ceppi di lievito diversi
Alcuni studi condotti dalla Fondazione Edmund Mach a livello industriale hanno evidenziato come l’ultimo 5% del volume pressato può contenere fino al 50% del totale di precursori estratti (Nicolini et al. 2020 L’enologo (6): 93-96; Fig. 2). Peraltro, fra i normali coadiuvanti utilizzati nella chiarifica dei mosto, soltanto il carbone diminuisce significativamente la concentrazione di precursori (Roman et al. 2016 Ital. J. Food Sci. 28(4):744-748) anche se in maniera limitata, alla luce dell’elevata dose applicata (1 g/L) e del basso tasso di conversione dei precursori in molecole libere. Non solo, alcuni trattamenti realizzati sul mosto potrebbero addirittura incrementare la concentrazione dei precursori (Larcher et al. 2015 Food Chem. 166(1):56-61) e la quantità di molecole aromatiche nel vino (Roman et al. 2018 Eur. Food Res. Tech. 244(3):379-386), data la loro naturale presenza in alcuni tannini commerciali di origine uvica.
Tuttavia, il vero catalizzatore dell’espressione tiolica nel vino è la fermen-
tazione alcolica e, in particolare, il lievito. Grazie alla sua attività enzimatica rompe i legami dei precursori, sprigionando la loro aromaticità sin dalle prime fasi di fermentazione. Ma non tutti i ceppi presentano le stesse vie metaboliche che permettono questo passaggio (Tabella 1) per cui la scelta determina il potenziale tiolico dei vini. Non solo, le condizioni nutrizionali per lo sviluppo del lievito permettono altresì di modulare la loro espressione, incrementando la concentrazione di molecole aromatiche nei vini a fine fermentazione alcolica grazie all’utilizzo di autolisati di lievito (Gallo et al. 2021 Macrowine 2021 online; Roman et al. 2020 L’enologo (9):93-97).
Parti dei risultati presentati sono state insigniti nel 2020 con il premio internazionale alla ricerca in enologia dalla Rudolf Hermann Stiftung, con il premio nazionale Roberto Ferrarini dalla SIVE per la miglior tesi di dottorato in enologia nel 2019 e con il premio Simei-UIV per l’innovazione tecnologica all’Enoforum Web Conference nel 2021.
La birra, caratteristiche, criticità e servizi offerti dal laboratorio di analisi della Fondazione Mach
Although the production of craft beer is a booming business also in the Province of Trento, guaranteeing a high-quality product calls for stringent analytical controls on all steps of the production process, from the choice of the raw material to useful microflora controls, to the prevention of spoilage microorganisms. The Technology Transfer Centre, thanks to its chemical and microbiological test laboratory, is able to provide a vast range of analytical solutions and support for improving the production process.
Il Trentino gode di una lunga tradizione brassicola, che deriva dalla cultura mitteleuropea che per lungo tempo ha caratterizzato queste terre. Nella seconda metà del ventesimo secolo, assieme al generalizzato calo dei consumi di vino e birra, si è assistito alla chiusura di numerosi birrifici nelle valli trentine. Oggi, il trend è decisamente
invertito e, sulla scia di una tendenza diffusa in Italia che premia le produzioni dei microbirrifici locali, anche in provincia di Trento assistiamo alla nascita di molti birrifici artigianali che, oltre a proporre una notevole gamma di birre, valorizzano anche prodotti agricoli locali. La produzione della birra, tuttavia, è tutt’altro che semplice.
MARIO MALACARNE TIZIANA NARDIN ROBERTO LARCHERFoto 1 Principali tecniche analitiche impiegate nell’analisi di lieviti e batteri di interesse brassicolo, conta su piastra Petri, conta microscopica e citometria di flusso

Figura 1
Schema generale del ciclo produttivo della birra, dalla scelta delle materie prime al confezionamento
Oltre all’accurata scelta di materie prime e alla padronanza del processo di produzione nelle sue numerose variabili (Fig. 1), il mastro birraio deve fare i conti con il rischio di contaminazioni di natura microbiologica. Come nel caso del vino, la presenza di alcol rende la birra una bevanda sostanzialmente salubre, incapace di ospitare microrganismi patogeni, dannosi per l’uomo. Tuttavia, numerose specie microbiche, lieviti e batteri, possono alterare i caratteri organolettici della birra o interferire con il processo produttivo e la conservazione. La birra, infatti, è naturalmente meno capace di “autoproteggersi” dalle contaminazioni microbiologiche, visto il modesto grado alcolico e la scarsa acidità. Vediamo quali sono i gruppi microbici di principale interesse.
Saccharomyces cerevisiae è il lievito per eccellenza nell’industria birraia tanto che già ai primi del ‘900 alcuni grandi birrifici nordeuropei possedevano laboratori microbiologici avanzati, almeno per quel tempo, in grado di isolare, purificare e riprodurre lieviti puri per i fabbisogni aziendali. Non a caso alcune specie di lieviti hanno nomi attinenti all’industria birraia, si pensi allo stesso S. cerevisiae (dove cerevisiae è un arcaico nome della birra), S. carlsbergensis (una nota marca di birra, ancora attiva) o Brettanomyces bruxellensis (da Bruxelles, una delle capitali europee della bir-
ra). Il genere Saccharomyces, nelle sue numerose varianti, è fondamentale nell’industria brassicola; vi sono tuttavia alcune specie gravemente alterative, come nel caso del Saccharomyces cerevisiae var. diastaticus, capace di causare rifermentazioni della birra vista la sua capacità di scindere, e successivamente fermentare, zuccheri complessi non assimilabili da altri lieviti o il “gushing”, un difetto che comporta un eccessivo sviluppo di schiuma all’apertura della bottiglia.
La purezza del lievito è uno dei “mantra” dell’industria brassicola, tanto che i birrifici più strutturati hanno laboratori interni che si occupano di mantenere pure e attive le proprie linee di lievito. In genere poi il processo produttivo della birra, che vede una vigorosa cottura del mosto prima della fermentazione, elimina la microflora spontanea, imponendo l’inoculo di una coltura selezionata di lievito per avviare la fermentazione alcolica. La presenza di lieviti di specie differenti da S. cerevisiae è un problema, soprattutto nella produzione di birre in stile “Lager” o, a “bassa fermentazione”. Nel caso delle birre in stile “Ale” o ad “alta fermentazione” il discorso è più complesso in quanto, soprattutto durante la maturazione della birra o la rifermentazione in bottiglia, non è raro osservare contributi positivi da parte di altri lieviti, tra cui in particolare il genere Brettanomyces/Dekkera. Que-
sto microrganismo alterativo nel vino è utile nella produzione di alcuni stili birrai in quanto capace di assimilare molecole complesse, infermentescibili per S. cerevisiae, e contribuire alla complessità aromatica del prodotto. Anche in questo caso si ricorre solitamente a ceppi selezionati, tuttavia vi sono birre, come i Lambic, prodotti nella regione di Bruxelles, che vedono lunghe rifermentazioni, condotte dalla microflora stabilitasi negli ambiti di lavorazione o nei barili in legno impiegati per l’affinamento della birra.
I batteri sono i principali nemici microbiologici di una birra di qualità. La birra può ospitarne agevolmente lo sviluppo, ed infatti l’igiene nei birrifici è un requisito fondamentale. I batteri, lattici in particolare, possono alterare pesantemente il profilo organolettico della birra. I batteri lattici possono infatti produrre il diacetile, la molecola responsabile dell’aroma di burro, che nella birra è vista come un difetto piuttosto grave. Anche l’accumulo di acido lattico e acetico, dalla degradazione degli zuccheri può essere un problema causato dai batteri lattici, così come intorbidamenti tardivi del prodotto o accumulo di molecole tossiche, ad esempio ammine biogene. Meno comune lo sviluppo di batteri acetici, ma non impossibile, e dunque anche in questo caso l’attenzione deve essere massima. Vi sono alcune eccezioni, in particolare le cosiddette “birre acide”, laddove oltre all’attività dei già citati lieviti non-Saccharomyces, può essere accettabile l’attività batterica, capace di dare appunto la caratteristica nota acida e aromi particolari a questi stili birrai, comunque di nicchia.
I servizi offerti dal laboratorio analisi della Fondazione Mach Il Laboratorio di analisi della Fondazione Mach offre ai birrifici trentini un’ampia gamma di analisi, sia chimiche che microbiologiche. Iniziando da queste ultime è possibile monitorare la concentrazione e la vitalità di lieviti, sia che si tratti di colture starter, essiccate o fresche, che di mosti di malto
in fermentazione. Tale monitoraggio può essere svolto applicando differenti tecniche analitiche, in funzione delle esigenze del cliente (Fig. 2). Si va dalla tradizionale conta su piastra Petri, utilizzando terreni specifici per i diversi gruppi di lieviti, alla conta microscopica, alla determinazione della carica e vitalità dei lieviti in citometria di flusso. In particolare, le ultime due metodiche offrono risultati in tempo reale, dunque perfettamente integrabili nel processo di fermentazione e danno indicazioni anche sulla popolazione di cellule inattive o dalla membrana cellulare danneggiata. Sono dunque utili indici per stabilire lo stato di salute della popolazione di lieviti e dunque la sua capacità nel condurre a termine positivamente la fermentazione alcolica. È inoltre possibile produrre colture di lievito fresche, anche di specie differenti da S. cerevisiae, per particolari stili birrai. Sul fronte del monitoraggio dei microrganismi contaminanti, il Laboratorio offre la determinazione di tutti i principali gruppi microbici di interesse brassicolo, batteri lattici, lieviti non Saccharomyces, muffe ed eventualmente la loro identificazione sia a livello morfologico che molecolare. Sul fronte delle determinazioni di natura chimica, il Laboratorio offre la determinazione del grado alcolometrico, del grado Plato, dell’acidità, dell’amarezza e del colore della birra. Vi sono poi analisi strumentali che possono indagare specifici composti, o famiglie di composti, di interesse, come le ammine biogene, i fenoli volatili, il profilo aromatico dovuto alla fermentazione dei lieviti o la presenza di allergeni come il glutine. Oltre all’ampia gamma di analisi offerte vi sono due aspetti che meritano di essere sottolineati. Il Laboratorio offre un servizio analitico sostenuto da attività di consulenza e sperimentazione, per aiutare i clienti nell’interpretazione dei dati e nella scelta delle strategie produttive più efficaci. Inoltre il Laboratorio è riconosciuto dal Ministero dell’Agricoltura come laboratorio qualificato nel settore agroalimentare, a conferma dell’accuratezza e affidabilità dei servizi analitici offerti.
La produzione del distillato di genziana, come documentato in numerose testimonianze storiche, ha in Trentino una lunga tradizione. Il procedimento per ottenere questo distillato è stato inventato più di 150 anni fa, grazie a pazienti e laboriosi accorgimenti. Nel corso degli anni il processo di produzione è stato ulteriormente affinato portando così ad ottenere un prodotto con peculiari caratteristiche organolettiche. Attualmente, il distillato di genziana prodotto in Trentino è inserito nel registro degli alimenti con marchio “IG” di Indicazione Geografica. Infatti, la denominazione “Genziana trentina” o “Genziana del Trentino” può essere applicata alla bevanda spiritosa la cui intera filiera produttiva, dalla raccolta della materia prima
all’imbottigliamento, avvenga interamente nel territorio della Provincia Autonoma di Trento.
L’acquavite di genziana può essere prodotta esclusivamente a partire dalle radici della Gentiana lutea o “Genziana maggiore”, pianta tipica dei pascoli dell’arco alpino che cresce ad un’altitudine compresa tra 1000 e 2500 m s.l.m.. Le radici vengono raccolte nei mesi di agosto e settembre e dopo essere state pulite e tagliate, vengono messe a fermentare. Terminata la fermentazione il prodotto viene distillato, con o senza aggiunta di alcol etilico di origine agricola, mediante impianto discontinuo a bagnomaria (metodo tradizionale Tullio Zadra) che consente di mantenere inalterate le tipiche caratteristiche organolettiche.

Il prodotto finale, che non può essere aromatizzato, è caratterizzato da un aroma intenso ma delicato, erbaceo da erba secca e fieno, speziato da bacche di ginepro con note di muschio e terra umida. Il sapore è deciso e persistente, non bruciante, leggermente amarognolo con note leggere di liquirizia.
Analizzando il profilo aromatico di una serie di campioni, prodotti da diverse distillerie trentine, si è trovato che i composti varietali responsabili del tipico aroma di genziana appartengono essenzialmente a tre classi chimiche: terpeni, aldeidi e pirazine. Tra i terpeni sono stati identificati e quantificati il linalolo, l’α-terpineolo, il limonene e il β-ciclocitrale che nel loro insieme conferiscono profumi floreali e agrumati, leggermente speziati, legnosi e resinosi. Tra le aldeidi, quelle presenti in quantità rilevabile sono state invece la trans-2-octenale, la trans-2-nonenale e la trans-2-trans-4-decadienale a cui sono riconducibili sentori di verde, cetriolo e coriandolo.
L’ultimo gruppo di composti rilevanti dal punto di vista aromatico è quello delle pirazine. Il distillato di genziana è risultato caratterizzato dalla presenza della 2-isopropil-3-metossipirazina (IPMP) e della 2-isobutil-3-metossipirazina (IBMP). Queste due molecole, nonostante siano presenti in concentrazioni dell’ordine dei μg/L, vanno a contribuire in modo significativo al bouquet complessivo grazie al loro tipico odore di terra, peperoni, erba e uva spina.
lutea" o "Genziana maggiore"

Le distribuzioni di concentrazione di terpeni, aldeidi e pirazine quantificati nei campioni analizzati sono state riportate in figura 1. Tali distribuzioni sono ovviamente influenzate dalla qualità della materia prima utilizzata, dall’annata e, non per ultimo, dal processo di distillazione.
Un ulteriore composto non appartenente alle classi chimiche sopra considerate ma comunemente presente nei distillati di erbe e radici, come appunto il distillato di genziana, è l’elemicine. Questa molecola è un alchilbenzene e conferisce il tipico sentore speziato. I campioni analizzati hanno mostrato valori di concentrazione di elemicine compresi tra 1,4 e 2,6 mg/L, con un valore medio di 1,9 ± 0,5 mg/L.
Figura 1
Distribuzioni di concentrazione di terpeni, aldeidi e pirazine nei campioni di distillato di genziana analizzati
By a multifunctional approach, meadows provide several ecosystem services in addition to high-quality fodder (hay or silage) for animal feeding. All of these depend mainly on botanical composition, which is in turn influenced by environmental and management factors. Farmers therefore play a key role in the conservation of the botanical composition of their meadows. In all cases where the botanical composition is unbalanced, extraordinary actions are required to restore meadow functionality. In the “Nutrire il futuro” [Feeding the Future] project, the effects of overseeding on the botanical composition and productivity of several meadows were monitored. The results confirmed the effectiveness of this action.
Nell’ambito del progetto di dialogo “Nutrire il domani ”, il Caseificio Sociale del Primiero, a cui conferisce il latte la quasi totalità degli allevatori della zona, si è fatto promotore di una serie di iniziative volte a riallacciare i rapporti tra produttori, consumatori e fruitori del territorio in genere. Una di queste ha riguardato il miglioramento, attraverso interventi di trasemina, dei “prati bianchi” sempre più diffusi nelle aree di fondovalle. Il progetto, sviluppato in collaborazione con il Centro Trasferimento Tecnologico, è iniziato nel 2017 e si è concluso nel 2021.
Situazione rilevata Inizialmente è stata condotta una stima sulle quantità di reflui prodotti e sui fabbisogni colturali delle singole aziende aderenti al progetto. Dall’analisi è emerso che mediamente i quantitativi prodotti in rapporto ai fabbisogni colturali non sono elevati (Tabella 1). Tuttavia, negli anni si è assistito a una sovra-concimazione (rispetto al numero di sfalci realizzati) delle superfici pianeggianti più vicine ai centri aziendali a scapito dei prati più lontani e declivi. Inoltre, reflui non sempre adeguatamente maturati e con un contenuto di lettiera alle volte insufficiente vengono spesso distribuiti in periodi di scarsa efficienza di assorbimento delle piante (autunno), piuttosto che durante la stagione vegetativa, anche a causa dei Regolamenti Comunali che ne vietano la distribuzione nel periodo estivo per
tutelare le esigenze della cittadinanza e dei turisti.
Tale gestione ha generato problemi ambientali ed estetici in molti prati del fondovalle. Qui l’aumento di ombrellifere (Anthriscus sylvestris, Heracleum sphondylium) e la diminuzione di altre specie fiorite hanno causato una perdita di policromia e una riduzione del loro pregio paesaggistico. Inoltre, da un punto di vista produttivo, è stata osservata una riduzione quantitativa e qualitativa delle produzioni.
Interventi di trasemina
Le caratteristiche dei suoli di montagna (poco profondi e ricchi di scheletro) raramente permettono la lavorazione profonda del terreno, limitando fortemente la possibilità di riqualificare i prati con la risemina. Al contrario, la trasemina è una tecnica di miglioramento meno invasiva che consente di riequilibrare la composizione botanica del prato senza rivoltare gli strati superficiali del terreno. Per questo motivo si è deciso di approfondire gli effetti di quest’ultima tipologia di intervento sui prati degradati della zona. La macchina utilizzata è la traseminatrice Green Master, una combinata della Güttler, che consente di modulare l’intensità di lavorazione in funzione del tipo di cotico presente e che garantisce la distribuzione della semente a spaglio (più omogenea) a differenza di altre macchine che utilizzano sistemi di semina a file. La
conformazione del rullo posteriore, inoltre, garantisce una buona adesione della semente al terreno con il cosiddetto effetto “a piede di pecora”. Nell’ambito del progetto, gli interventi di miglioramento dei prati sono stati realizzati su un totale di 68,8 ettari: una sola volta su 56,3 ettari, due volte su 6,2 ettari e tre volte su 6,3 ettari. I miscugli utilizzati sono stati tre (come indicato nelle Tabelle 2, 3 e 4) mentre la dose di seme impiegata era compresa tra i 20 kg per ettaro (interventi diretti senza pulizia del cotico) e i 30 kg per ettaro (interventi più ag-
gressivi in cui le infestanti erano più abbondanti).
La tecnologia di costruzione delle macchine da trasemina è migliorata notevolmente negli ultimi anni e l’efficacia degli interventi è decisamente superiore rispetto al passato grazie anche all’introduzione del rullo posteriore e di organi strigliatori con aggressività modulabile. Tuttavia, le condizioni meteorologiche giocano ancora un ruolo decisivo nella buona riuscita dell’operazione. Infatti,
Totale 43.247 kg 78.721 kg 54%
Miscuglio tipo A: specie e varietà %
Arrehenatherum elatius (avena altissima) Arone 2
Festuca pratensis (festuca dei prati) Senu 10
Festuca pratensis (festuca dei prati) Darimo 6
Dactylis glomerata (erba mazzolina) precoce Amba 8
Dactylis glomerata (erba mazzolina) tardiva Baraula 3
Phleum pratense (coda di topo) Tiller 10
Lolium perenne (loglio) Ambisque 13
Poa pratensis (erba fienarola) Balin 20
Festuca rubra rubra (festuca rossa) Gondolin 19
Trifolium pratense (trifoglio ibrido) Altaswede 2
Trifolium repens (trifoglio bianco o ladino) Tasman 3
Lotus corniculatus (ginestrino) Leo 1
Trifolium hybridum (trifoglio ibrido) Aurora 3
Miscuglio tipo U1: specie e varietà %
Dactylis glomerata (erba mazzolina) precoce Baridana 21
Phleum pratense (coda di topo) Comer 21
Lolium perenne (loglio) precoce Barnauta 13
Lolium perenne (loglio) tardivo Tivoli 13
Poa pratensis (erba fienarola) Balin 32
Miscuglio Prato
Trentino 1000: specie e varietà %
Lolium perenne (loglio) 13
Festuca pratensis (festuca dei prati) 12
Festuca arundinacea (festuca falascona) 15
Dactylis glomerata (erba mazzolina) 40
Phleum pratense (coda di topo) 20
Tabella 1
Livello percentuale di disponibilità di azoto
Tabella 2
Miscuglio tipo A: composizione percentuale
Tabella 3
Miscuglio tipo U1: composizione percentuale
Tabella 4
Miscuglio Prato polifita Trentino 1000: composizione percentuale
1
Foto 2 (A e B)
Particolari del prato prima e dopo il passaggio della traseminatrice
gelate precoci o tardive e periodi piovosi o siccitosi a ridosso dell’intervento possono condizionarne notevolmente l’esito. In alcuni casi (es. piogge persistenti e prolungate in primavera o a inizio autunno - finestre ottimali di intervento) possono addirittura vanificarlo completamente. Nella primavera 2018, proprio a causa di un prolungato periodo di precipitazioni non è stato possibile realizzare tempestivamente il primo sfalcio. Questo ha ridotto gli effetti positivi dell’intervento in quanto le specie infestanti, già ben affermate in precedenza, si sono potute sviluppare quasi indisturbate sottraendo luce e nutrienti alle giovani pianti -
ne appena germinate. Pertanto, al primo sfalcio 2018 si è prodotto un foraggio scadente e grossolano che ha richiesto un maggior numero di rivoltamenti e lunghi tempi di essiccazione in campo. Ciò nonostante, le medie produttive dei campioni effettuati nel 2018 (10 sul primo sfalcio, 6 sul secondo e 4 sul terzo) confermano un aumento di produzione nel traseminato rispetto al testimone. Inoltre, nel trattato è stato osservato un aumento delle graminacee e una riduzione delle “altre specie” (tra cui le infestanti) soprattutto su primo e terzo taglio.


Nel 2019 si è registrato un incremento produttivo nei primi due sfalci e

un leggero calo nel terzo taglio, probabilmente ascrivibile all’andamento climatico stagionale. A conferma di quanto osservato l’anno precedente, il contributo delle “altre specie” è diminuito a favore delle graminacee. Per contro, però, è stata registrata anche la riduzione delle leguminose, famiglia già poco diffusa nei prati trentini a gestione più intensiva. I risultati sopra esposti sono da considerare interessanti in quanto hanno consentito di registrare un certo miglioramento già nei primi tagli successivi all’intervento. Infatti, solitamente è necessario attendere due o tre anni prima che le nuove plantule si insedino stabilmente e quindi esprimano pienamente le loro potenzialità produttive.
Gli interventi di riqualificazione hanno fatto registrare un miglioramento in termini di composizione floristica e produttività, nonostante in alcuni casi le condizioni meteo avverse ne abbiano condizionato sensibilmente l’esito. I costi d’intervento, variabili tra i 200 ed i 260 € per ettaro, non sembrano essere particolarmente limitanti per le aziende, a patto che chi ha effettuato l’oneroso investimento di acquisto della traseminatrice sia disposto a effettuare una certa quota di contoterzismo. Questa tipologia di intervento è da considerarsi comunque un’operazione di miglioramento straordinaria che non può prescindere dall’applicazione delle buone pratiche di gestione del prato.

Dalla corretta gestione del prato dipende la sua “salute”: composizione botanica equilibrata e buona produttività. Intervenire in modo tempestivo e seguendo lo sviluppo vegetazionale del proprio prato migliora la sostenibilità generale dei sistemi foraggero-zootecnici di montagna.
GABRIELE IUSSIG ELISA BELLISTRI
Weather conditions undoubtedly influence the growth rate of vegetation, which can arise as an alternation of early- and late-seasons. Farmers therefore must be able to accurately identify the stage of phenological development of their meadows, in order to act at the right time to preserve their “health”, i.e. suitable soil cover, absence of weeds and good forage quality. To support farmers in this assessment, in April 2021, the phenological stage of the most common grassland species was monitored by FEM technicians in different locations distributed evenly throughout the province of Trento. Every week, data were published in a phenological report and a final assessment was performed at the end of the year.
Il momento dello sfalcio non dovrebbe essere un riferimento fisso in quanto dipende, oltre che dalle caratteristiche identitarie di ogni sito (es. altitudine, suolo, esposizione), anche dall’andamento climatico di ogni
singola stagione. Infatti, lo sviluppo vegetazionale e quindi il momento dello sfalcio possono cambiare notevolmente da un anno all’altro influenzando in modo positivo o negativo numerosi aspetti, tra cui la qualità e la quantità del foraggio prodotto e
Il bollettino fenologico delle specie prative: l’attività di monitoraggio sui prati trentini
la presenza di buone foraggere o di “infestanti”.
Tuttavia, scegliere il periodo ottimale per sfalciare non è sempre facile in quanto bisogna essere in grado di determinare con precisione in quale fase dello sviluppo si trovano le specie dominanti. Nei prati con finalità produttiva prevalente queste specie sono solitamente rappresentate dalle graminacee, specie che però presentano caratteri distintivi meno appariscenti rispetto ad altre. Per questo motivo, stabilire se una pianta si trova all’inizio della fase riproduttiva oppure è in piena fioritura può essere complicato.
Per cercare di supportare gli allevatori in questa delicata fase di valutazione in campo, ad aprile 2021 è nato il “Bollettino Fenologico delle specie prative”, un’attività di monitoraggio della fenologia delle principali specie prative svolta in diverse località trentine, omogeneamente distribuite sull’intero territorio provinciale, dai tecnici dell’Unità Risorse Ambientali, Energetiche e Zootecniche.
Settimanalmente, è stato monitorato e documentato lo “stadio fenologico” delle principali specie prative (graminacee, leguminose e altre dicotiledoni) in undici località trentine presso le quali sono disponibili i dati climatici grazie alla presenza di stazioni meteo della rete FEM o di Meteotrentino. I dati vegetazionali raccolti in campo sono stati quindi sintetizzati in diverse schede, una per ogni sito, e pubblicati in un bollettino scaricabile gratuitamente dal sito della Fondazione Mach. All’interno di ogni scheda tecnica sono stati riportati dati di tipo climatico (precipitazioni e “somma delle
temperature”) e le foto delle principali specie foraggere, per metterne in luce gli aspetti caratteristici e distintivi. Inoltre, sono state aggiunte anche delle indicazioni gestionali specifiche per ogni sito e periodo considerato che delineano come e quando intervenire in funzione delle finalità che si vogliono raggiungere (es. aumentare la qualità del foraggio, massimizzare la produzione, contrastare la diffusione delle infestanti).

I dati raccolti in campo nel 2021 sono stati elaborati sulla base di alcuni studi e metodi di calcolo sulla fenologia delle principali specie prative condotti in Svizzera da un ente di ricerca nazionale (ADCF). L’attività di ricerca e sperimentazione ha permesso di mettere in relazione la fenologia delle principali specie foraggere con l’Erba Mazzolina (Dactylis glomerata), specie ubiquitaria molto diffusa anche in Trentino. Sulla base di queste relazioni specie-specifiche è possibile calcolare un valore medio della fenologia per singolo prato monitorato (“Stadio equivalente Dactylis” (SED)).La trasferibilità di questo metodo anche alla realtà trentina ha permesso di ottenere dei primi riferimenti in ambito foraggero validi per un confronto nel tempo e tra le diverse località monitorate. Per poter calcolare il valore medio di fenologia (SED medio) di ciascuna prateria è stato prima necessario standardizzare i dati raccolti in campo (Fig. 1), cioè trasformarli nello stadio fenologico che in quello stesso momento avrebbe avuto la specie osservata se si fosse trattato dell’erba mazzolina (SED della singola specie).
Figura 1 Esempio di calcolo del “SED per la singola specie” (Coda di volpe - Alpoecurus pratensis) e del “SED medio della prateria” nella settimana 10-16 maggio, nella località di Romeno
SED medio delle praterie: andamento dello stadio fenologico medio di ogni sito monitorato nell’anno 2021. Altitudine (m s.l.m.) delle località monitorate: Telve (423 m), Bleggio superiore (663 m), Brentonico (749 m), Mezzano (697 m), Bezzecca (715 m), Romeno (930 m), Folgaria (1033 m), Pinzolo (775 m), Pellizzano (953 m), Cavalese (957 m) e Moena (1205 m)
Per fare ciò sono state utilizzate delle equazioni di 1°, 2° o 3° grado frutto di analisi statistiche sui dati raccolti in Svizzera in oltre venti anni di lavoro. Si precisa che l’attendibilità dei modelli statistici svizzeri è sempre molto elevata (R2 compreso tra 0,74 e 0,85).
Per ogni data e località è stato dunque possibile determinare lo stadio fenologico medio delle praterie utilizzando i dati raccolti in campo e i valori di SED calcolati per tutte le specie considerate (Tabella 1).

Nella maggior parte delle località lo stadio fenologico 4 (SF4), momento ottimale per sfalciare un prato mediamente intensivo e ottenere il miglior compromesso tra quantità e qualità del foraggio, è stato raggiunto nella settimana tra il 17 e il 23 maggio. Le sole praterie che si sono dimostrate più precoci sono state quelle di Telve e Brentonico (SF4 raggiunto nel corso della settimana precedente) e quelle
2,00 1,50 1,50 1,50 1,50 1,00 1,00 26-02 maggio 3,00 2,50 2,50 2,50 2,00 1,50 1,50 1,50 1,00 1,50 03-09 maggio 3,00 3,00 3,00 3,00 2,50 2,50 2,00 2,00 2,00 1,50 10-16 maggio 4,00 3,50 4,00 3,50 3,00 3,50 3,00 3,00 2,50 2,00 17-23 maggio 4,50 4,50 4,50 4,00 4,00 4,50 4,00 4,00 3,50 3,00 24-30 maggio 5,00 5,00 5,00 4,50 4,50 4,50 4,50 4,50 4,00 3,50 31-06 giugno 5,50 - 5,50 5,00 5,50 5,00 4,50 5,00 5,00 4,00 2,00 07-13 giugno 6,00 5,50 5,50 5,50 5,50 5,50 5,50 5,00 4,50 3,00 14-20 giugno - 6,00 - 6,50 - 6,00 - 6,50 - -
di Bleggio superiore e Romeno (SF4 raggiunto a cavallo tra le due settimane). Se l’andamento fenologico osservato a Telve è da considerarsi “scontato” in quanto si tratta del sito posto alla quota più bassa in assoluto, altrettanto non si può dire di Romeno, che ha mostrato una notevole precocità nonostante l’altitudine del sito. In tutte le località poste a quota più elevata (Pinzolo, Romeno, Pellizzano, Cavalese, Folgaria e Moena) la ripresa vegetativa è stata più lenta rispetto a quanto osservato negli altri siti. Tuttavia, in tre di queste (Pinzolo, Romeno e Folgaria) tale differenza è stata annullata nell’arco di qualche settimana. Nelle località di Pellizzano e Cavalese, invece, questo non si




è verificato: lo SF4 è stato raggiunto rispettivamente con una o due settimane di ritardo rispetto alla media.
Il lavoro iniziato nel 2021 proseguirà anche nei prossimi anni. Le informazioni ottenute dall’elaborazione dei dati 2021 costituiscono ora una base di riferimento per un confronto con l’andamento che sarà osservato in futuro nelle diverse località. Se l’attività di monitoraggio e raccolta dati sui prati trentini dovesse proseguire sufficientemente a lungo, si potrà valutare anche la possibilità di elaborare delle specifiche equazioni per il calcolo del SED che meglio si adattano al contesto provinciale.
In the mountain region, keeping a balance between livestock, the natural environment, tourism, and the urban sector is important. Manure can be used to maintain soil fertility. The introduction of specific treatments can ensure the good quality of the manure products, limiting negative agro-environmental and social impacts. The aerobic treatment could be promising for improving the amendment properties of manure. Three aerated piles were built in Val di Ledro in the Spring of 2021: two of them with cattle manure, the third with goat manure. The process was monitored for 90 days, considering pH and electrical conductivity, dry matter content, organic matter content, organic carbon, and macronutrients (N-forms, P, and K). The attainment of biological stability was assessed by measuring the Dynamic Respiration Index. The results highlighted the good amendment quality (prevalence of organic nitrogen and good biological stability) of the products obtained, demonstrating the feasibility of treating the manure through a fast controlled aerobic process, the so-called “manure maturation”.
La vocazione zootecnica del territorio della Val di Ledro è rappresentata da un numero elevato di piccole aziende bovine e caprine, per un totale di circa 800 vacche da latte e 400 capre. Negli ultimi decenni anche il settore turistico nella zona si è sviluppato notevolmente, favorito dalla presenza del lago, che è al contempo anche un’importante risorsa idrica. In contesti come questo è molto importante mantenere l’equilibrio fra zootecnia, ambiente e tessuto sociale: gli effluenti prodotti dagli allevamenti possono essere utilizzati per mantenere la fertilità dei terreni aziendali ma in quantità coerenti con le necessità delle colture e nei periodi di maggior efficienza nutritiva, limitando al minimo gli impatti ambientali sia di tipo chimico (lisciviazione elementi nelle acque) che odorigeno. Fondamentale è che gli effluenti impiegati abbiano una elevata qualità agronomica, raggiungibile mediante opportuni trattamenti.
In quest’ottica è stato condotto uno studio di fattibilità finanziato dal Comune di Ledro, per promuovere una gestione razionale degli effluenti palabili. Va ricordato che per quanto attiene gli effluenti liquidi, in zona è attiva da anni una iniziativa per la loro delocalizzazione verso compar-
ti agricoli limitrofi alla Valle di Ledro, che necessitano di elevati apporti azotati per la coltivazione del mais da granella.
In una prima fase dello studio è stata effettuata una ricognizione delle aziende zootecniche con almeno 10 capi allevati, raccogliendo informazioni in merito a geolocalizzazione, numero di capi e tipologia, tipo di stabulazione e lettiera, durata dell’alpeggio, capacità di stoccaggio degli effluenti, superfici disponibili per gli spandimenti ecc. Dall’indagine è emerso, tra l’altro, che:
• i 18 allevamenti della valle sono concentrati in un’area piuttosto ristretta, con una distanza stradale massima fra due aziende di 12,4 km;
• il letame è l’effluente maggiormente prodotto in loco ed ammonta ad oltre 6.000 mc/anno;
• 14 allevatori si sono dichiarati interessati ad una iniziativa collettiva per la gestione del letame, le loro aziende producono oltre il 77% dell’effluente palabile.
In questo scenario si è ritenuto che la soluzione idonea al trattamento dei letami bovini e caprini degli allevamenti presenti in valle sia la maturazione controllata in cumuli aziendali allestiti in pieno campo, gestita mediante macchina itinerante, evitando
la realizzazione di strutture centralizzate quali platee o capannoni. Una gestione efficace e performante della maturazione controllata non può prescindere dall’impiego di idonee macchine, dette “rivoltatrici”, che movimentano le masse in trasformazione biologica garantendo un’aerazione intensa e capillare. In primo luogo, è stata quindi individuata una macchina idonea alla realtà in esame, in grado di trattare materiali solidi ma al contempo molto umidi ed omologata per la circolazione stradale e successivamente si è passati alla fase dimostrativa e di messa a punto del sistema, allestendo due cumuli di letame bovino ed uno caprino in modo da testare la tecnica su entrambe le tipologie di effluenti solidi prodotti in valle. I cumuli avevano dimensioni analoghe per quanto attiene la sezione (B 3 m, b 0,5 m, h 1,5 m circa) mentre la lunghezza variava da 10 a 20 metri circa. Il materiale di partenza era costituito da letame bovino con paglia (cumulo A), molto umido e povero di struttura, letame bovino con stocchi di mais (cumulo B) il materiale certamente migliore, molto soffice e poroso, e letame caprino (cumulo C), poroso ma con umidità piuttosto bassa.
Tutti gli effluenti provenivano da uno stoccaggio in concimaia. Il processo ha avuto una durata complessiva di 90 giorni, con rivoltamenti per l’ossigenazione delle masse effettuati ai giorni 7, 14, 21, 28, 42, 56 e 70; in considerazione del carattere sperimentale delle prove, le movimentazioni sono state effettuate anche ad inizio e fine processo al fine di omogeneizzare il materiale e favorire campionamenti rappresentativi. I cumuli sono stati protetti dalle precipitazioni con teli in geotessile (massa areica 200 g/mq - Foto 1). L’evoluzione dei processi è stata seguita mediante sopralluoghi distanziati di circa 20 giorni, rilevando le temperature delle masse mediante termometro digitale e sonda a termocoppia e prelevando campioni di materiale per la successiva determinazione di umidità, sostanze volatili, pH e conducibilità elettrica specifica. A inizio, metà e fine processo sono stati prelevati campioni per la determinazione dei seguenti parametri, oltre a quelli precedentemente indicati: carbonio organico, azoto totale ed organico, fosforo, potassio. A inizio e fine processo è stato determinato l’indice respirometrico e, solo sui prodotti finali, anche il carbonio umico. I dati dei

Foto 1
Copertura dei cumuli con tessuto geotessile
rilievi e quelli analitici sono riportati in tabella 1.
Le caratteristiche dei prodotti ottenuti Esaminando i valori riportati in tabella 1 relativi al campionamento a fine processo (90 giorni), si possono trarre alcune conclusioni sulla qualità dei prodotti ottenuti dalle prove. I tre letami sottoposti a maturazione controllata evidenziano una elevata qualità agronomica. Il tenore di s.o. è buono nei letami bovini e molto alto in quello caprino, con una componente umica molto buona in tutti i materiali, di gran lunga superiore a quanto si riscontra usualmente negli ammendanti compostati industriali. Anche la stabilità biologica della s.o. è da evidenziare, con valori dell’indice respirometrico molto bassi in tutti i campioni. La dotazione di elementi nutritivi è molto buona, con un elevato contenuto di azoto quasi totalmente in forma organica, a lenta cessione e non lisciviabile. Il rapporto C/N si colloca su valori tipici degli ammendanti provenienti da processi di stabilizzazione biologica. La dotazione di fosforo e soprattutto potassio è buona, specie nel letame caprino. Unici parametri su valori non ottimali sono il pH e la conducibilità
elettrica specifica (particolarmente elevata nei letami “B” e “C”) come si riscontra frequentemente negli effluenti zootecnici, ma i prodotti sono comunque pienamente idonei ad impieghi in pieno campo. Per quanto attiene l’umidità, si conferma che la maturazione controllata – anche se gestita in campo – consente di ridurre in maniera significativa il tenore idrico dei letami. Da evidenziare infine che i letami maturi erano totalmente inodori.
La maturazione controllata ha consentito un netto miglioramento della qualità agronomica ed ambientale dei letami testati. La stabilizzazione e l’umificazione della sostanza organica e la buona dotazione di macroelementi li rende ottimali per il miglioramento della fertilità dei suoli, mentre la dotazione di azoto in forma organica contribuisce al mantenimento di una buona composizione floristica dei prati. Il calo dell’umidità rispetto ai materiali di partenza consente di ridurre i quantitativi da distribuire a parità di apporto di nutrienti, riduce la densità apparente e l’imbrattamento dei mezzi utilizzati per il trasporto e la distribuzione. Da sottolineare la non idoneità dei prodotti per usi spe-


0 15 81,5 8,23 1,66 80,16 40,5 2,39 86,9 16,95 0,51 3,45 3998
19 38 81,5 9,07 1,61 73,86 42 30 79,9 8,99 1,66 69,91 38,6 2,09 98,6 18,47 0,69 3,71 63 34 79,9 9 0,66 68,13 90 27 75,1 9,25 1,23 61,31 30,5 11,84 2,88 99,7 10,59 0,68 3,56 549
Processo (giorni) Temperatura (°C) Umidità (%) pH CES (mS/cm) SV (% s.s.) C organico (% s.s.) Acidi umici e fulvici (% s.s.) N totale (% s.s.) N organico % su N tot. C/N P tot. (% s.s.) K tot. (% s.s.) IR (mg O2 kg SV-1 h-1)
0 55 76,3 8,74 2,12 65,02 35,8 3,05 91,8 11,74 0,77 2,81 1984 19 50 67,7 9,27 2,79 66,73 42 44 58,8 9,34 3,82 57,37 28,6 2,84 99,3 10,07 0,95 4,36 63 47 55,8 8,95 1,58 51,9 90 43 52,8 9 4,33 49,48 27,9 12,77 1,94 99,5 14,38 0,98 4,01 201
Cumulo C (caprino)
0 58 54,9 8,77 4,74 81,15 41 1,9 21,58 0,7 3,16 1584 19 30 39,1 9,33 5,19 78,66 42 29 49,2 9,07 4,82 77,49 39 2,53 98,8 15,42 0,92 4,13 63 43 50,6 9,39 4,61 74,65 90 40 43 9,3 5,23 73 39,7 13,93 2,96 99,0 13,41 1,24 4,76 148
cialistici in purezza (buca di piantagione, colture in vaso ecc.) per i valori di pH e conducibilità elettrica specifica piuttosto elevati. L’azoto in forma organica scongiura anche rischi di inquinamento per lisciviazione di nitrati, mentre la totale assenza di odore
consente l’impiego dei letami anche in prossimità dei centri abitati ed in periodi di presenza turistica, molto diffusa in Valle di Ledro. Il presente lavoro è stato pubblicato su L’Informatore Agrario (Cristoforetti et al. 2022 L’Inf. Agr. 20: 47-50).
Tabella 1 Risultati dei rilievi sulle tipologie di letami sottoposte a maturazione controllata (CES = conducibilità elettrica; S.v. = sostanze volatili; C/N = rapporto carbonio/azoto; IR = Indice di respirazione dinamico)
Bees are extraordinary pollinators because their existence is based on what flowers offer them. Pollen is their only source of protein and lipids, while nectar has an energetic value. Although their role as pollinators is fundamental for agriculture, in recent decades only species kept by humans (honey bees and bumblebees) have been able to play this role in monocultures managed with pesticides that enable the presence of sedentary Apoidea. In addition to its products and ecosystemic service of pollination, the honey bee also allows environmental monitoring to be carried out based on the substances it brings to the colony. Due to the great ecological role of all bees, the Fondazione Edmund Mach has been studying these organisms for many years and in more recent times has carried out environmental biomonitoring, both with honey bees and other Apoidea, to make agriculture more sustainable.
Le api ovvero gli Apoidei antofili, quelli che per vivere sono strettamente legati ai fiori risultando quindi eccellenti impollinatori, sono un gruppo di insetti di cui si conoscono oltre 25.000 specie a livello mondiale; in
Europa sono segnalate circa 2.000 specie e di queste oltre 1.000 sono note per l’Italia. Sono molti gli organismi impollinatori ma in Europa questi sono esclusivamente insetti e soprattutto coleotteri, ditteri, lepidotteri e

imenotteri; a questi ultimi appartengono le api. La loro grande efficienza come impollinatori deriva dal fatto che, a differenza degli altri insetti impollinatori, esse basano tutta la loro esistenza, sia come insetti adulti che durante gli stadi giovanili, su quanto offrono loro i fiori e cioè il polline ed il nettare. Il nettare è per le api una fonte energetica, che possono trovare anche nella melata o in succhi zuccherini di frutti, ecc. Ma l’unica fonte proteica e lipidica di questi insetti deriva dal polline e per questo il loro legame con i fiori è indissolubile e per tale stretto legame questi insetti sono considerati degli eccellenti bioindicatori. In genere, quando ci si riferisce alle api, si tende a considerare solo una specie, l’ape da miele o mellifica, l’Apis mellifera descritta da Linneo nel 1758. L’importanza di questa specie deriva dalla possibilità di allevarla con grande facilità potendo così ottenere prodotti di straordinaria importanza per l’alimentazione e la salute umana. Allevata probabilmente da 8-6.000 anni, fino a tempi molto recenti l’importanza dell’ape mellifica è derivata dalla produzione del miele ma anche della cera e della propoli. Questa situazione è cambiata radicalmente solo negli ultimi decenni ed oggi uno dei beni più preziosi che l’apicoltura è in grado di fornire alla società umana è proprio l’impollinazione delle piante coltivate. Con la rivoluzione verde i campi coltivati, radicalmente trasformati dalla diffusione delle monoculture e dal sempre più intenso uso di agrofarmaci, hanno registrato in molti casi la scomparsa dei pronubi naturali per l’effetto della semplificazione vegetale, delle lavorazioni del terreno e soprattutto a causa degli insetticidi o acaricidi. Poiché solo l’impollinazione entomofila, quella mediata da insetti, garantisce in genere una adeguata produttività sia dal punto di vista quantitativo che qualitativo, si rende in molti casi necessario trasferire insetti impollinatori allevati o gestiti dall’uomo nelle aree coltivate durante il periodo di fioritura, per poi allontanarli (nel caso dell’ape mellifica) o lasciarli a loro stessi (come
per i bombi o altre poche specie di apoidei). Negli ultimi anni, tuttavia, il mondo dell’agricoltura ha tuttavia compreso che l’attività agricola deve trovare nella biodiversità degli agroecosistemi una risorsa interna, in grado di favorire gli obbiettivi produttivi ed economici degli agricoltori, ed una risposta concreta alla sempre maggiore richiesta di sostenibilità proveniente dai consumatori. La ricerca oggi dimostra ad ogni piè sospinto che solo agroecosistemi complessi, che vedano la presenza di catene ecologiche ampie, possono essere più idonei ai fini produttivi. Si è ricominciato a pensare al terreno non come ad un supporto ma come un ecosistema ed alla presenza di piante diverse da quella coltivata come un serbatoio di nemici naturali degli organismi pericolosi per la coltura in atto. Nei decenni passati la ricerca in agricoltura ha ottenuto notevoli successi, anche sulla strada verso la sostenibilità, attraverso il monitoraggio dei parassiti o dei patogeni delle colture, abbandonando la dannosa quanto spesso poco efficace lotta a calendario. Con la riscoperta del grande valore agronomico della biodiversità negli agroecosistemi ad essere oggetto di monitoraggio sono oggi anche molti altri organismi come i macroinvertebrati del suolo (fondamentali per la fertilità), i ditteri sirfidi e le coccinelle (predatori di afidi e cocciniglie) e le api, sia per quanto riguarda le api mellifiche che tutte le altre specie (impollinatori). Valutare la complessità e l’abbondanza delle diverse specie di api in un ambiente agrario permette di valutare vari aspetti allo stesso tempo, come la complessità vegetale e la corretta gestione nell’uso degli agrofarmaci. Solo in un ambiente con una adeguata complessità vegetale e in cui non si verifichino avvelenamenti possono infatti instaurarsi popolazioni molteplici ed abbondanti di apoidei antofili. Questi insetti, ad eccezione dell’ape mellifica, hanno un raggio di azione molto limitato, in genere di poche decine o centinaia di metri e la loro presenza, varietà ed abbondanza misurano dunque
in modo efficace quello che avviene esattamente in una data area. L’ape mellifica ha invece un raggio di azione molto più ampio e le api bottinatrici (quelle che vanno alla raccolta di polline, nettare, acqua, ecc.) hanno in genere un raggio d’azione compreso tra 1,5 e 3 km, potendo però spostarsi anche oltre i 10 km. Questi insetti, quindi, misurano quello che avviene all’interno di un’area molto più ampia, almeno pari a 30 km2. Inoltre, un altro aspetto che rende le api da miele molto interessanti ed utili nei biomonitoraggi ambientali è la possibilità di gestirle, di monitorarne il loro sviluppo e benessere e soprattutto di raccoglie dalle loro colonie matrici (miele, cera, polline, propoli, api adulte, larve ecc.) andando alla ricerca, mediante raffinate analisi di laboratorio, di contaminanti di varia origine. Tra le varie matrici quella maggiormente utilizzata è il polline, che può essere prelevato alle api prima che venga introdotto nell’alveare grazie alle trappole pigliapolline, utilizzate dagli apicoltori per la raccolta di questo prodotto il cui consumo umano è in grande espansione per il
suo valore nutraceutico. Raccogliere il polline dalle api bottinatrici prima che entrino nell’alveare ci permette di avere una misura di quanto è possibile trovare nell’ambiente in un dato intervallo di tempo. Questo intervallo è molto ridotto, in quanto il polline ha una vita molto breve e quindi quello raccolto oggi dalle api conterrà eventuali contaminanti presenti o immessi nell’ambiente negli ultimi giorni. Per questo motivo la Fondazione Edmund Mach da molti anni si occupa di biomonitoraggio ambientale con le api, sia api mellifiche che gli altri apoidei. Negli ultimi tempi è stato svolto un monitoraggio a livello provinciale in ambienti interessati in prevalenza da frutticultura, viticoltura, aree urbane e naturali. Lo studio dei pollini raccolti, della loro origine botanica e dei contaminanti rilevati medianti analisi multiresiduali, ha negli anni permesso di mettere in luce le evidenti criticità e di partire da queste per trovare soluzioni alternative, mitigando sempre più gli effetti negativi degli agrofarmaci nei confronti degli impollinatori e, di conseguenza, della biodiversità in generale.


Nell’ambito delle attività di studio sulle specie alloctone acquatiche, nel giugno 2021 è stato effettuato un monitoraggio mirato a valutare la diffusione del bivalve Corbicula fluminalis (Muller, 1774) nel Lago di Caldonazzo. La prima segnalazione della specie nel lago, risalente al 2019 (Bodon et al. 2020. Boll. Malacol. 56:127171), rappresenta infatti un segnale di allarme per gli ambienti acquatici trentini, in quanto C. fluminalis e altre specie appartenenti al genere Corbicula (C. fluminea, C. largilliertii e C. leana) non erano mai state segnalate in Trentino, ad esclusione del Lago di Garda, ambiente dove si è assistito ad una vera e propria “invasione” che negli ultimi 20 anni ha modificato completamente anche l’aspetto delle rive, con evidenti e abbondanti depositi di conchiglie spiaggiate (López-Soriano et al. 2018 Adv. Oceanogr. Limnol. 9 (2):97-104).
Il monitoraggio è stato effettuato in vari punti lungo la sponda occidentale e meridionale del lago, con campionamenti effettuati tramite benna o retino immanicato. La distribuzione del bivalve risulta essere pressoché
to della prima segnalazione, limitata alla zona a canneto sita ad est dei pontili della Pizzeria “Alle Barche” con fondo ben ossigenato. Un solo esemplare è stato rinvenuto in una stazione sita ad ovest.
È stata inoltre effettuata una prima attività di divulgazione/informazione ai referenti del Centro Nautico Universitario AugsburgerHof gestito dal CUS Trento e della Associazione Velica Trentina, poiché l’introduzione di specie alloctone acquatiche è originata spesso dallo spostamento delle imbarcazioni di diporto fra vari ambienti acquatici.
Oltre a C. fluminalis nel Lago di Caldonazzo è presente dal 1992 un altro bivalve alloctono, Dreissena polymorpha, giunto molto probabilmente mediante il trasporto di imbarcazioni da diporto. I due bivalvi si aggiungono ad una lunga lista di altre specie alloctone animali presenti nel lago, appartenenti a gruppi diversi, quali i pesci (ad es. coregone, pesce gatto nero, persico sole), i rettili (tartaruga dalle orecchie rosse) e gli invertebrati (gambero americano). Per queste specie animali l’introduzione può essere non solo in
FRANCESCA CIUTTI CRISTINA CAPPELLETTIFoto 1
Esemplari di Corbicula fluminalis raccolti nel 2021
Foto 2
Fase del campionamento con retino immanicato
la fauna ittica ad esempio può essere legata alle semine (involontaria) o all’interesse per la pesca (volontaria). Tutto ciò porta purtroppo a sottolineare la vulnerabilità del Lago di Caldonazzo, e in generale degli ambienti acquatici trentini, alle invasioni biologiche e la necessità di procedere con l’attività di informazione sulla problematica dell’introduzione delle


specie acquatiche alloctone, in quanto qualsiasi attività di eradicazione o contenimento risulta essere negli ecosistemi acquatici pressoché impossibile. Nei prossimi anni sarà inoltre opportuno continuare a monitorare la diffusione di C. fluminalis, anche ai fini di valutare l’effetto della nuova specie sull’intero ecosistema.
Figura 1
Caldonazzo: presenza di Corbicula fluminalis (in rosso) nel 2019 e 2021 (cerchio: Bodon et al. 2019; rettangolo: FEM 2021)
L’allevamento in malga nell’immaginario collettivo è associato ad un’idea pulita di sostenibilità, esso infatti generalmente impatta di meno sull’ecosistema rispetto all’allevamento intensivo provocando minori emissioni di anidride carbonica. D’altronde, la provenienza da una materia prima, il latte, ottenuta da vacche allevate in modo estensivo non è l’unico fattore che rende i prodotti caseari di malga sostenibili. Essi vengono infatti considerati tali soprattutto grazie al fatto che sono a km zero e che minimizzano i reflui di lavorazione. Questi ultimi, nella maggior parte dei casi vengono utilizzati per l’alimentazione animale direttamente in malga. Inoltre, nascono proprio in un’ottica di sostenibilità alcuni prodotti tradi-
zionali come la ricotta e il burro; la produzione della ricotta, infatti, prevede il recupero delle proteine dal siero derivante dalla lavorazione del formaggio e quella del burro ottimizza la filiera produttiva del formaggio nostrano utilizzando come materia prima la panna separata dal latte. Proprio questo burro di malga, certamente per le sue caratteristiche di sostenibilità ma anche di tradizionalità ed aromaticità, è molto ricercato ed è quindi prodotto in tutte le malghe pur rimanendo una nicchia dei prodotti caseari.

Fonti storiche testimoniano che già ad inizio ’800 il burro trentino era molto apprezzato e venduto anche nei territori circostanti (Schiavon et al. 2022 InForma 39:46-47). Ancor oggi la
SILVIA SCHIAVON MAURO PAOLINI RAFFAELE GUZZON ELENA FRANCIOSI* ANDREA MANCINI* ROBERTO LARCHER TOMAS ROMANIl burro di malga, prodotto sostenibile, tradizionale e dalla preziosa variabilità* Centro Ricerca e Innovazione, Fondazione Edmund Mach
Figura 1
Abbondanza relativa (%) dei principali gruppi di taxa (livello di genere o superiore) di sequenze batteriche nei campioni di burro. Ogni barra è il valore medio di 3 campioni raccolti in diverse malghe (Lettere A - P) ubicate nella provincia di Trento (da Schiavon et al. 2022 Microorganisms 10(1):17).

sua lavorazione segue la tradizione; la crema infatti viene separata dal latte dopo il naturale affioramento notturno e zangolata. Il grasso agglomerato viene confezionato in panetti, dopo essere stato lavato ripetutamente e impastato manualmente (Schiavon et al. 2022 L’allevatore trentino 43(2):2831). Queste pratiche, molto simili tra le diverse malghe, risentono tuttavia della peculiarità degli ambienti produttivi e della diversa “mano” dei casari, con cambiamenti non trascurabili nella stessa microflora del latte
(Schiavon et al. 2022 Terra Trentina 67(1):64-65). I burri nascono così con una propria caratteristica espressione della qualità sensoriale, facilmente avvertibile dai consumatori ed evidenziata da una recente sperimentazione iniziata l’estate del 2020. Questo studio ha avuto come obiettivo d’indagine proprio il microbiota batterico e le caratteristiche aromatiche di 42 burri di malga. Sono state coinvolte 14 malghe presenti sulle montagne della Valsugana, della Val di Sole e della Val di Rabbi, ciascuna
Cyanobacteria Other Bacteroidetes Staphylococcus Methanobrevibacter
Acidobacteria Micrococcaceae Other Actinobacteria Chryseobacterium Leuconostoc
Lactococcus Streptococcus Other firmicutes
Enterobacteriaceae Xanthomonadacea Other Proteobacteria
Acinetobacter Enhydrobacter Pseudomonas
delle quali ha utilizzato il proprio metodo di burrificazione.
È così emerso che il burro è un buon substrato per la crescita di un›ampia gamma di taxa batterici, nonostante la produzione avvenga interamente a bassa temperatura (tra gli 8 e i 13 °C). Si sono inoltre evidenziate importanti differenze di umidità e nelle quantità di due importanti composti aromatici che caratterizzano il profumo del burro: il diacetile e l’acetoino. In ogni caso, a conferma dell›estrema variabilità di malga, le differenze mi crobiologiche e aromatiche si sono dimostrate indipendenti dall›origine geografica della malga e dall›umidità residua del burro. All’interno della complessa popolazione batterica si sono potuti comunque distinguere nettamente i taxa batterici predomi nanti, Acinetobacter e Pseudomonas (Fig. 1), ma è stato anche possibile evidenziare che ogni produzione di malga era caratterizzata da singoli taxa batterici in grado di guidare la differenza nella produzione del pro prio burro, un po’ come un’impronta digitale o un marchio di fabbrica. Un aspetto tecnologicamente interes sante emerso è che la pre-maturazio ne del latte, accorgimento adottato spesso in malga quando la crema scarseggia, potrebbe indurre ad un aumento di batteri Lactococcus e

Streptococcus nel burro. Poiché questi batteri si sono dimostrati essere correlati con una elevata produzione di acetoino, si potrebbe ipotizzare che la pratica della pre-maturazione possa fare aumentare la quantità di questo importante composto aromatico nel burro (Schiavon et al. 2022 Microorganisms 10(1):17). Quest’ultima intuizione, come gli altri interessanti elementi emersi in questo studio, hanno posto le basi per poter approfondire scientificamente un prodotto così interessante nella


Chymosin is a protease that coagulates the casein of milk, which is essential for obtaining curd and therefore for the production of cheese. It can either be derived from animal rennet or be obtained from a host organism in which the gene encoding protease is expressed (genetic chymosin). The analysis of the stable isotope ratio of nitrogen makes it possible to distinguish between the two types. Values of δ15N lower than 5.7‰ indicate an adulteration of the animal rennet by addition or substitution with genetic chymosin.
La chimosina è una proteasi che coagula la caseina del latte indispensabile per ottenere la cagliata e quindi per produrre il formaggio. Il suo prezzo, strettamente correlato con l’andamento del mercato della carne essendo un sottoprodotto della macellazione, ha visto una impennata durante la pandemia da Sars-coV2 a
seguito della riduzione del macellato. Come spesso accade questo ha esposto il prodotto a possibili contraffazioni quali la sostituzione con altre fonti di chimosina. I prodotti “alternativi” alla chimosina animale sono tre e tutti con costi di produzione inferiori a quelli del caglio animale: un prodotto di origine microbica a base di
enzimi proteolitici ottenuti da alcune specie fungine (R. miehei, Rhizomucor pusillus e Cryphonectria parasitica) che però ha una minore resa di coagulazione e lascia un retrogusto amaro nel formaggio; un prodotto di origine vegetale da Cynara cardunculus L. subsp. favescens Wiklund, che dà una cagliata morbida non adatta alla produzione di formaggi stagionati e il principale competitor del caglio animale, la chimosina ricombinante o genetica. Chimicamente identica a quella da vitello essa viene ottenuta da DNA ricombinante di microrganismi geneticamente modificati quali bacilli, lattococchi, lieviti o muffe, che esprimono la proteasi in alta concentrazione. La pur elevata produzione a livello mondiale viene assorbita per il 90% dai paesi anglosassoni: Usa e Gran Bretagna. In Francia è infatti consentita solo per specifiche produzioni e comunque in quota minoritaria mentre in Italia il caglio animale è l’unica fonte di chimosina consentita per la produzione di formaggi DOP come il Parmigiano Reggiano e il Grana Padano. Le due chimosine da un punto di vista chimico non mostrano differenze e quindi sino ad oggi non esisteva un metodo analitico in grado di differenziarle. L’analisi dei rapporti tra isotopi stabili, utilizzata dai primi anni ‘90 come approccio ufficiale per determinare l’autenticità di diverse tipologie di alimenti, tra cui il vino, l’aceto, il miele, i succhi di frutta e più recentemente i formaggi (UNI 11692:2017), ha finalmente sanato questa lacuna dimostrando la sua capacità di discriminare le due diverse chimosine.
Sono stati campionati 53 campioni di caglio animale autentico e di 9 campioni di chimosina genetica di sicura origine. Per la caratterizzazione del caglio animale, che ha una variabilità elevata, è stato campionato dal maggior numero di zone di produzione cercando di raccogliere informazioni anche in relazione alla stagionalità del prodotto. La chimosina ricombinante è invece un prodotto standardizzato perché prodotta da un numero limitato di aziende nel mondo.
Su questi campioni è stata eseguita l’analisi del rapporto isotopico dell’azoto (15N/14N, espresso come δ15N).
L’azoto è un elemento presente in natura sotto diverse forme che differiscono per la massa, cioè il numero di neutroni: l‘azoto 14 (14N) con 7 neutroni e l’azoto 15 (15N) con 8 neutroni. L’azoto 14 è presente per circa l’80% dell’azoto totale presente in natura; in minor quantità ma comunque presente è l’azoto 15. L’analisi valuta il rapporto fra queste due forme. Uno dei fattori che possono influenzare questo rapporto è l’origine animale della materia prima analizzata. Ad ogni passaggio trofico, infatti, c’è un aumento del 15N. È corretto quindi aspettarsi che i valori di questo rapporto nei prodotti di origine animale siano molto elevati proprio perché gli animali - in questo caso i bovini - sono in una posizione alta della catena alimentare. Ogni volta che l’azoto viene ingerito e quindi trasformato si concentra nel suo isotopo più pesante.
Il prodotto genetico invece è ottenuto da una fermentazione e quindi si può parlare al massimo di un passaggio trofico (trasformazione del substrato nutritivo fornito ai batteri che hanno trasformato l’azoto elementare in chimosina). Ci si può aspettare che nella chimosina così ottenuta il rapporto sia più basso.
Il metodo sviluppato ha permesso di analizzare il δ15N della chimosina animale e di compararlo con quello della chimosina genetica. La chimosina di origine animale ha valori relativamente omogenei, compresi tra +5,7 ‰ e +8,0 ‰; non si è notata alcuna differenza significativa tra caglio animale in polvere e liquido o tra diverse origini geografiche di produzione.
La chimosina genetica invece ha valori che variano fra -5 e +2. I valori più bassi, rispetto al caglio animale e la maggiore variabilità sono dovuti al fatto che la fonte di azoto della chimosina genetica dipende dalla composizione del mezzo di fermentazione, che può contenere composti di azoto sintetici con valori di δ15N compresi tra -6 ‰ e +6 ‰.
Figura 1
Intervallo di valori di δ15N nel caglio animale e in chimosina prodotta dalla fermentazione
Sulla base dei valori di caglio animale è possibile identificare un valore limite di δ15N pari a +5,7 ‰ per il caglio autentico (Fig. 1). L’aggiunta di chimosina genetica al caglio animale, o la sua sostituzione completa, influisce sul δ15N del caglio animale, in quanto ne abbassa significativamente il valore. Se il caglio animale presenta quindi un valore di δ15N della chimosina estratta inferiore al limite di +5,7 ‰ significa che il campione è adulterato. È possibile stimare una capacità di identificazione di fraudolente aggiunte fino al 10-15% di chimosina ricom-
binante. Si tratta di un valore significativo, poiché al di sotto di questa quantità la frode commerciale è poco probabile soprattutto da un punto di vista economico. Possiamo affermare che la metodica isotopica è il primo metodo analitico elaborato in grado di discriminare fra queste due chimosine chimicamente identiche. Il metodo, pubblicato in Food Chemistry nel 2019 (Camin et al. 2019 Food Chem. 293:545-549) verrà presto sottoposto ad approvazione come metodo ufficiale di controllo.

L-Teanina: l'analisi isotopica per la tutela di questo prezioso alleato della salute
Fin dall’antichità, la tradizione di preparare zuppe e bevande derivanti dall’infusione della Camilla sinensis, la pianta del tè, veniva tramandata di generazione in generazione dai popoli della Cina. Oggi i benefici del tè vengono associati a svariati composti organici, tra i quali spicca un particolare amminoacido: la L-teanina. La molecola vanta innumerevoli qualità, tra cui si possono elencare l’induzione dello stato di rilassamento muscolare (Vuong et al. 2011 J. Sci. Food. Agric. 91:1931e9), la regolazione della pressione sanguigna (Liu et al. 2009 Cytotechnology 59:211e7), il rafforzamento della capacità di apprendimento (Cooper et al. 2005 J. Alternative Compl. Med. 11:521e8) e del sistema immunitario (Takagi et

al. 2010 J. Vet. Med. Sci. 72:157e65), nonché il coinvolgimento nei processi neuronali che regolano i livelli di dopamina e serotonina (Mason 2001 Alternative Compl. Ther. 7:91e5).
In natura, la L-teanina viene sintetizzata nelle radici della pianta del tè, venendo poi trasportata dalla linfa a tronco e rami e accumulandosi infine nelle foglie, di cui costituisce solo il 1-3% del peso secco (Vuong et al. 2011). A causa della sua bassa concentrazione nelle foglie di tè, l’estrazione in grandi quantità di questo amminoacido direttamente dalla pianta costituisce una sfida per i produttori. È pertanto facile intuire quanto la sintesi enzimatica della L-teanina, che permette di ottenere grandi quantità del medesimo pro-
Figura 1
Valori isotopici di carbonio e azoto riscontrati per campioni naturali, commerciali e sintetici di L-teanina. La linea scura rappresenta il limite di soglia per un campione di L-teanina naturale.
dotto in modo economicamente e tempisticamente vantaggioso, possa apparire come una valida alternativa all’estrazione dalla pianta.
Allo scopo di prevenire frodi derivanti da questa eventualità, è stato sviluppato un metodo in grado di garantire l’autenticità degli integratori alimentari a base di L-teanina.
La sintesi enzimatica della molecola, infatti, prevede l’acido L-glutammico come il principale materiale di partenza il quale, a sua volta, viene ottenuto dalla fermentazione del glucosio, generalmente derivante da piante economicamente convenienti di tipo C4. Essendo invece la Camilla sinensis una pianta di tipo C3, è stato possibile distinguere il prodotto naturale da quello sintetico grazie
all’analisi degli isotopi stabili del carbonio (δ13C).
Figura 2
-10
-12
-14
-16
-18
-8 δ 13 C (‰, VS V-PDB)
-20
-22
-24
-26
Il metodo sviluppato, che consiste nella purificazione del campione tramite cromatografia liquida preparativa e nell’analisi dello stesso tramite analisi elementare accoppiata alla spettrometria di massa isotopica, ha permesso di distinguere chiaramente i campioni naturali da quelli sintetici e di caratterizzare i prodotti già disponibili in commercio (Fig. 1). È stato inoltre possibile stabilire un valore limite di δ13C al di sotto del quale un prodotto possa essere dichiarato come “naturale” (Fig. 2). In questo modo, e una volta ampliato il dataset a nostra disposizione, sarà possibile individuare le frodi economiche a carico di questo prezioso integratore alimentare. -10 -5 0 5 10 15 -28
δ15N (‰, VS AIR)
Naturale Sintetico Commerciale
-12
-14
-16
-18
-10 δ 13 C (‰, vs-PDB)
-20
-22
-24
-26
Variazione del rapporto isotopico del carbonio di un campione di L-teanina naturale adulterato con crescenti quantità di teanina sintetica. La linea scura rappresenta il limite di soglia per un campione di L-teanina naturale. -10 0 10 20 30 40 50 60 70 80 90 100 110 -28
% di L-teanina sintetica aggiunta
Mepiquat (MQ) and chlormequat (CQ) are well-known products commonly used in agriculture as inhibitors of gibberellin biosynthesis. Several studies have reported the natural formation of MQ in foods through a Maillard-type reaction that requires free lysine, a reducing sugar, and an alkylating agent, heated under dry conditions. Trigonelline, choline, and betaine have been identified as possible methylating agents. Rarely, also the natural formation of chlormequat from choline has been demonstrated.
In this study, cocoa powder and chocolate chips were cooked in an oven at 160, 180 and 230 °C for 15 and 50 min, to mimic the baking of cakes or biscuits. These lab-cooked samples and 24 other representative commercial cocoa samples were extracted by adapting the QuPPe-PO method and analysed by IC-HQOMS. Mepiquat production of up to 10 ug/kg was confirmed in the lab-cooked samples, whereas no MQ and CQ was found in the commercial products.

Mepiquat (MQ) e il clormequat (CQ) sono noti prodotti comunemente usati in agricoltura come inibitori della biosintesi della gibberellina. Numerosi studi scientifici ne riportano
però la possibile naturale formazione all’interno di alimenti quali caffè, cereali, vegetali e carne a seguito di processi produttivi ad alte temperature. Ad oggi non vi sono in
informazioni in merito al cioccolato, seppur le condizioni di produzione del cacao e le lavorazioni dei prodotti di pasticceria potrebbero essere condizioni ideali per lo sviluppo di questi composti. Nel nostro Paese il cioccolato è un mercato da circa 2 miliardi di euro e, nonostante un leggero calo, un italiano ne consuma in media 4 kg all’anno in tavolette, senza considerare tutti i prodotti commerciali derivati. Per approfondire questo aspetto quindi, il Laboratorio dell’Unità di Chimica Vitienologica e Agroalimentare ha sviluppato un metodo in spettrometria di massa ad alta risoluzione finalizzato alla determinazione di MQ e CQ negli alimenti. Come primo obiettivo si è valutata la possibile formazione di MQ e CQ in cacao e cioccolato svolgendo diversi trattamenti a caldo in laboratorio e in seguito si sono eseguite delle analisi di controllo su diversi campioni comunemente presenti in commercio. La tossicologia di CQ e MQ è stata studiata su topi, ratti e cani. I risultati formalizzati dall’Autorità europea per la sicurezza alimentare (EFSA) affermano che queste sostanze chimiche hanno una bassa tossicità acuta: CQ è classificato come H302/H311 "Nocivo se ingerito" e "Tossico a contatto con la pelle" mentre MQ è classificato come H302 "Nocivo se ingerito" e H412 "Nocivo per gli organismi acquatici con effetti di lunga durata". I limiti massimi di residuo (MRL) di CQ (somma di clormequat e suoi sali, espressa come clormequat-cloruro) e MQ (somma di mepiquat e suoi sali, espressa come cloruro di mepiquat) per i diversi alimenti sono stati stabiliti dall'Allegato III del Reg. (UE) 2020/1565 e Allegato II Reg. (UE) 2019/50, rispettivamente (“REGOLAMENTO (UE) 2019/50 DELLA COMMISSIONE”, 2019, “REGOLAMENTO (UE) 2020/1565 DELLA COMMISSIO-
NE”, 2020). In particolare, per il cacao sono stati definiti i limiti di 0,05 e 0,1 mg/kg rispettivamente per CQ e MQ, entrambi riferiti al limite di determinazione analitica. Diversi studi hanno esaminato la possibilità di neoformazione di MQ durante il processo di tostatura in malto, caffè e orzo rilevando che la lisina durante la reazione di Maillard subisce ciclizzazione (per decarbossilazione) in presenza di uno zucchero riducente e fornisce la piperidina come intermedio (Hammel et al. 2014 Food Addit. Contam. Part A 31(2):226-233). Successivamente, un gruppo N-metilico viene trasferito da un composto azotato quaternario alla piperidina nucleofila generando quantità rilevabili di MQ (Fig. 1). Finora, trigonellina, colina e glicina betaina sono state identificate come possibili agenti di metilazione. Anche l’acido pipecolico fornisce allo stesso modo piperidina, anche se con l’ulteriore requisito di agenti alchilanti, e la betaina dell’acido pipecolico può formare una quantità relativamente elevata di MQ direttamente attraverso la decarbossilazione (Yuan et al. 2017 Food Chem. 228:99-105). Il fattore chiave nella quantità di MQ prodotto è risultato essere la temperatura: si forma alla temperatura di tostatura tipica del caffè (220-240 °C), ma anche nel malto tostato a 169 °C seppur in minor quantità. La formazione naturale di CQ è stata studiata nei malti d’orzo scuri e il meccanismo chimico è stato spiegato da Eriksen et al. (2020 J. Agric. Food Chem. 68(29):77277733) valutando il ruolo della colina e dei suoi derivati nella formazione di CQ in condizioni termiche (200 °C). Recentemente, uno studio ha confermato la formazione di MQ anche in patate, broccoli e carne (Li et al. 2021 Food Res. Int. 150:110771) e CQ in farina di frumento e uova in polvere dopo la cottura (Eriksen et al. 2020 J.
Agric. Food Chem. 68(29):7727-7733).
Theobroma cacao contiene diversi alcaloidi: principalmente teobromina (da 0,5 a 2,7%) ma anche caffeina (circa 0,25%) e trigonellina. I livelli endogeni di trigonellina nel cacao sono inferiori a quelli osservati nel caffè, nei semi secchi 27,9 ± 6,1 µmol/g peso fresco. La lisina è presente nel cacao in circa 70 µmol/g e nelle fave di cacao si trovano lo 0,3 allo 0,4 % di fosfolipidi di cui la fosfatidilcolina è il componente principale.
In questo studio abbiamo inizialmente osservato la cinetica di formazione del MQ e CQ in un campione di cacao in polvere e un campione di gocce di cioccolato cotti in forno a 160, 180 e 230 °C per 15 e 50 minuti, imitando la cottura di torte o biscotti. Tutti i campioni sono stati cotti in triplicato. Inoltre, sono stati raccolti 24 campioni commerciali (tavolette, creme al cioccolato e biscotti) presso supermercati del Trentino-Alto Adige per valutare la formazione di MQ e CQ nei processi industriali.
I campioni sono stati estratti adattando la procedura dei metodi QuPPe-PO (Metodo rapido per l’analisi di pesticidi altamente polari, 2021) e analizzati con un sistema Dionex™ ICS-5000 HPIC accoppiato ad uno spettrometro di massa ibrido quadrupolo-Orbitrap Q-Exactive (Thermo Scientific, Brema, Germania) dotato
di sorgente di elettrospray riscaldata (HESI-II). Per la concentrazione e la purificazione del campione è stata utilizzata una SPE-online IonPac CS17 (2 × 15 mm, 5,5 μm) e per la successiva separazione cromatografica una colonna IonPac CS19 (2 × 250 mm, 5,5 μm). La separazione è stata eseguita ad un flusso di 0,4 mL/min con un gradiente MSA da 2 mM a 40 M. In nessun campione prodotto in laboratorio è stato rilevato il CQ, mentre la formazione di MQ si è verificata sia nel cacao che nelle gocce a partire da 180 °C. A questa temperatura la formazione appare essere molto lenta e visibile solo dopo 55 minuti di cottura (circa 2 µg/kg), mentre a 230 °C la formazione risulta estremamente più rapida e dopo 15 minuti si raggiunge una quantità quasi pari a quella rilevata a 55 minuti (circa 8 µg/kg per il cacao e 7 µg/kg per le gocce; Fig. 2). Nei campioni al commercio non è stata rilevata la presenza di nessuno dei due analiti. Ciò fa presupporre che nonostante il cacao possa essere una fonte di produzione naturale di MQ, le temperature e le tempistiche di cottura adottate nei processi commerciali non sono sufficienti a determinare la formazione. Sembrerebbe invece più plausibile la formazione di MQ durante le cotture casalinghe che più rispecchiano quanto operato in laboratorio.
Figura 2
Grafico di formazione naturale di mepiquat in cacao e gocce di cioccolato
Figura 1
2014) al
iscritti
suo avvio
dicembre
Figura 2
Numero avvisi via mail
FONDAZIONE MACH NOTIZIE ON-LINE 639 20 60 14 28 5 29 20 14
456.898 Totale mail inviate 268.838 6.246 26.632 1.958 6.822 1.719 34.449 33.754 FONDAZIONE MACH NOTIZIE ON-LINE
Totale degli avvisi inviati via sms per le varie colture nel 2021: 705
MELO
Numero avvisi via sms MELO VITE PICCOLI FRUTTI CILIEGIO E ALBICOCCO ACTINIDIA OLIVO SUSINO NOCE VARIE 352 109 27 104 17 15 44 17 20
Totale sms inviati nel 2021: 256.153
CILIEGIO E
ALBICOCCO
La ricezione della messaggistica tecnica è legata all’adesione/iscrizione ai servizi di consulenza a fronte di una compartecipazione ai costi per le colture: melo, vite, ciliegio e piccoli frutti, actinidia, susino, albicocco e produzioni zootecniche. Per la messaggistica sulle colture olivo, noce e apicoltura è mantenuto l’accesso libero e gratuito.
Stazioni meteo con sistema antibrina coinvolte 46 di cui 10 sperimentali su ciliegio
Totale SMS di allerta gelate inviati nel periodo 15/3 - 10/5
Numero allarmi per melo 702
Totale sms inviati per melo 90.701
Numero allarmi per ciliegio 1.071
Totale sms inviati per ciliegio 46.312
Numero di allarmi inviati per stazione (16 notti per melo e 22 notti per ciliegio dal 15/3 al 10/5)
Terlago 36 melo - 41 ciliegio Caldonazzo 35 melo - 42 melo Mezzolombardo - Maso delle Part 32 melo - 36 ciliegio
TEMPERATURE: APP FEM Dati Meteo Trentino
Utilizzo dell’APP per consultare i grafici gelate in tempo reale dal 15/3 al 10/5
Numero accessi complessivi 35.141 Numero utenti 220
Sistema operativo Android
Accessi 195.135 di cui con autenticazione 53.086
Sistema operativo IoS Accessi 50.116 di cui con autenticazione 18.062
SITO FITOEMERGENZE
Sito dedicato alle emergenze fitosanitarie (colpo di fuoco batterico, flavescenza dorata e scopazzi del melo) https://fitoemergenze.fmach.it/ Visualizzazioni di pagina 6.579
Su campioni di vite, melo e pero, ciliegio, albicocco, susino, noce, pesco, actinidia, olivo, piccoli frutti e piante orticole e ornamentali Resp. Gino Angeli - gino.angeli@fmach.it - fito.diagnostica@fmach.it
Virus, funghi, batteri, fitoplasmi, nematodi, insetti (per programma interno, per clienti esterni e programma PAT) Diagnosi foreste e verde urbano
Su un totale di circa 29.000 campioni di varie merceologie Resp. Roberto Larcher - roberto.larcher@fmach.it - segreteria.laboratorio@fmach.it
Tracciabilità dell'origine con isotopi e microelementi Analisi di controllo viti-enologiche Consulenza enologica a piccole aziende private-Analisi e refertazione Analisi di controllo su alimenti Profili aromatici in vino e distillati
Analisi di residui di fitofarmaci negli alimenti Analisi di suoli e vegetali Indagini microbiologiche sugli alimenti
Resp. Tomas Roman - tomas.roman@fmach.it
4.803 43
3.917 10.281 3.139 3.145 1.265 2.725 2.755 1.700
Processi di microvinificazione completi o parziali per sperimentazione e servizi 765
Resp. Gastone Dallago - gastone.dallago@fmach.it - centrodisaggio.ctt@fmach.it
Sperimentazioni fitopatologiche su melo, vite, piccoli frutti, ciliegio, olivo, altre specie vegetali agrarie 79
Resp. Gino Angeli - gino.angeli@fmach.it
Ispezioni sull’attività dei Centri già autorizzati dalla PAT Ispezioni sull’attività dei Centri fuori provincia 1 3
Resp. Maurizio Bottura - maurizio.bottura@fmach.it
Mantenimento e selezione di biotipi /cloni ufficiali Saggi di inoculo in campo (indexaggi vite) e diagnosi malattie da virus 520 biotipi / 65 cloni ufficiali 300 combinazioni
Resp. Daniele Prodorutti - daniele.prodorutti@fmach.it
Artropodi (Indice QBS-ar) Indice micorrizazione 159 campioni 6 campioni
Resp. Maurizio Bottura - maurizio.bottura@fmach.it
Analisi della vigoria e della variabilità interna del vigneto
• Rilievi NDVI (Normalized Difference Vegetation Index), tramite Skye Spectrosense per la valutazione della biomassa fotosinteticamente attiva
• Rilievi SPAD (colorimetro fogliare, stima indiretta della clorofilla) Verifica attività prodotti fertilizzanti
• Sperimentazioni di prodotti fertilizzanti, ammendanti, biostimolanti e corroboranti su vite e fruttiferi Analisi di struttura (Texture Analyzer), numero determinazioni per • Consistenza della bacca • Durezza della buccia e/o della polpa • Spessore della buccia
ANALISI PRE- POST-RACCOLTA
Resp. Tomas Roman - tomas.roman@fmach.it
Analisi fisico chimiche per test di maturazione Test dell’amido
Analisi fisico chimiche e controllo qualità su frutta in conservazione (celle)
Resp. Stefano Corradini - stefano.corradini@fmach.it - meteo@fmach.it
Raccolta, archiviazione e pubblicazione su web dei dati di 95 stazioni agro-meteorologiche raccolti in tempo reale con cadenza 15 min. Totale pagine visitate (dal 01-01-2021 al 31-12-2021): Media giornaliera Media mensile
5.675 6.250 38 tesi sperimentali (143 parcelle) 6.240 6.450 6.240
1.404 1.372 1.206
225.450 618 18.787
Resp. Stefano Corradini - stefano.corradini@fmach.it - meteo@fmach.it
Stazioni meteo coinvolte RIMpro (melo/ticchiolatura)
Totale accessi Accessi medi per stazione Giorno con più accessi (29 aprile)
Stazioni più visitate: Cles, San Michele, Aldeno, Coredo RIMpro (vite/peronospora)
Totale accessi Accessi medi per stazione Giorno con più accessi (12 maggio) Stazioni più visitate: San Michele, Arco, Giovo, Lavis
Resp. Filippo Faccenda - filippo.faccenda@fmach.it - centroittico.ctt@fmach.it
Macroinvertebrati (Indice Biotico Esteso) Macroinvertebrati (Metodo STAR_ICMi) Diatomee (Indice ICMi) Rapporti tecnici
Resp. Filippo Faccenda - filippo.faccenda@fmach.it - centroittico.ctt@fmach.it
Analisi chimico-fisiche e piscicolture trentine Prelievo campioni per valutazione impatto trofico reflui piscicolture Sorveglianza sanitaria troticolture e incubatoi di valle Ispezioni regolamentate dal D. Lgs 148/2008 al fine di verificare le buone prassi sanitarie in allevamenti ittici Consulenze Consulenza ad aziende itticole, associazioni ed enti Analisi ittiopatologiche e autoptiche Analisi autoptiche su pesci e determinazione cause di morte Analisi chimico-fisiche su pesce Analisi di texture su filetti di trota (TPA) Sperimentazioni zootecniche Test su diete sperimentali
54 21.415 385 917 10.820 210 240
34 6 147 32
52 50 2 4 32 4
Resp. Gino Angeli - gino.angeli@fmach.it Caratterizzazione morfometrica delle api 16
Resp. Silvia Silvestri - silvia.silvestri@fmach.it
Analisi chimiche biomasse Determinazione FOS/TAC, SV, umi, pH
Analisi biologiche biomasse Determinazione indice respirometrico Determinazione del potenziale di produzione di biogas (BMP) Test di fitotossicità (germinazione, accrescimento)
Analisi olfattometriche Determinazione della concentrazione di odore ai sensi della EN 13725: • Indagini olfattometriche • Monitoraggio con naso elettronico
Consulenze specialistiche Studi di fattibilità, supporto tecnico - analitico, supporto scientifico su Legge 6/99
Resp. Gabriele Iussig - gabriele.iussig@fmach.it
Consulenza aziendale qualità latte, piano mastite, alpicoltura/maiscoltura/ praticoltura, alimentazione animale, economia e bilancio aziendale, costruzioni zootecniche, gestione reflui, ovicaprini Piano mastite bovini Aziende coinvolte Campioni di latte per analisi microbiologica Consulenza specialistica per piccoli ruminanti Aziende coinvolte Diagnosi ecografica di gravidanza Interventi di fecondazione artificiale Campioni di latte per analisi microbiologica
Consulenza per la redazione dei Piani di utilizzazione agronomica del digestato Supporto alla progettazione, ristrutturazione, ammodernamento e adeguamento stalla al benessere animale
Resp. Tomas Roman - tomas.roman@fmach.it
77 40 1 24 test fitotossicità alla germinazione 6 test accrescimento 3 1 14
1.365 contatti in 254 aziende di cui 651 per il Piano mastite
135 aziende di fondovalle, 11 malghe 10.286 16 718 107 148 5 41 contatti
Convenzione consulenza casearia alle malghe trentine Consulenza in loco, analisi campioni prelevati/consegnati e refertazione 9 malghe
Nel 2021 il CTT ha fornito prestazioni professionali e strumentali per 1.273 aziende (enti pubblici e imprese private) in Italia e all’estero.
Figura 6
Distribuzione della provenienza delle aziende clienti in Italia e all’estero (totale 1.273)
Figura 7
Distribuzione della provenienza delle aziende clienti in Italia (totale 1.211)


Laboratorio chimico e microbiologico (Unità Chimica vitienologica e agroalimentare e Unità Trasformazione e Conservazione)
Laboratorio diagnosi fitopatologica (Unità Protezione delle piante agroforestali e apicoltura)
Laboratorio chimico e microbiologico (Unità Chimica vitienologica e agroalimentare e Unità Trasformazione e Conservazione)
Laboratorio chimico (Unità Chimica vitienologica e agroalimentare)
Laboratorio chimico e microbiologico (Unità Chimica vitienologica e agroalimentare e Unità Trasformazione e Conservazione)
Laboratorio chimico e microbiologico (Unità Chimica vitienologica e agroalimentare e Unità Trasformazione e Conservazione)
Centro di Saggio (Unità Centro di Saggio)
Laboratorio diagnosi fitopatologica (Unità Protezione delle piante agroforestali e apicoltura)
Laboratorio diagnosi fitopatologica (Unità Protezione delle piante agroforestali e apicoltura)
Centro di conservazione e di premoltiplicazione per le pomoidee (Unità Viticoltura e Olivicoltura, Unità Protezione delle piante agroforestali e apicoltura, Azienda agricola)
Centro ittico
Accreditamento ACCREDIA (Ente Italiano di Accreditamento) numero 0193, attualmente per 67 prove, corrispondenti a circa 300 parametri analitici
Autorizzazione Ministero delle politiche agricole alimentari e forestali al rilascio dei certificati di analisi nel settore vitivinicolo
Designazione dei Laboratori di prova per analisi di controllo in agricoltura biologica
Inserimento nell’albo del MiUR (Ministero dell’Istruzione, dell’Università e della Ricerca) dei laboratori esterni pubblici e privati altamente qualificati per attività di “Ricerca e sviluppo sperimentale nel campo della chimica, della biologia, delle scienze naturali e dell’ingegneria”
Iscrizione negli elenchi provinciali dei “Laboratori di analisi non annessi alle industrie alimentari ai fini dell’autocontrollo”
Riconoscimento del Ministero per le Politiche Agricole Alimentari e Forestali di conformità alle buone pratiche di campo
Laboratorio pubblico autorizzato dal Mipaaf per le finalità di cui al DM 02 luglio 1991, N 290
Riconoscimento per l’esecuzione delle diagnosi ufficiali degli organismi nocivi contemplati dalle normative di competenza dell’Ufficio fitosanitario provinciale
Riconoscimento ufficiale del Ministero per le Politiche Agricole Alimentari e Forestali
Autorizzazione alla sperimentazione animale di cui al D. Lgs 116/92
Norma UNI CEI EN ISO/IEC 17025
DM 17 ottobre 2018
DM 2592 del 12 marzo 2014
DM 30 dicembre 2008
DPP 23 febbraio 2005, n. 1-31/Leg art. 1
DM 6 giugno 2000, Prot. n. 33038
DM 10 ottobre 1996 DM 13 dicembre 2011
Delibera GP n. 696 del 9 maggio 2014
DM 24 luglio 2003
DM 23 ottobre 1987
DM 120/2008-A del 3 settembre 2008
http://openpub.fmach.it/
Alawamleh A., Ðurović G., Maddalena G., Guzzon R., Ganassi S., Hashmi M.M., Wäckers F., Anfora G., Cristofaro A.D. (2021).
Selection of lactic acid bacteria species and strains for efficient trapping of Drosophila suzukii Insects, 12 (2): 153.
(1) Monitoring of Drosophila suzukii is based on the use of effective traps and baits. The current baits are insufficient to provide efficient monitoring. The use of bacteria as bio-catalyzers to produce bioactive volatiles may improve flies’ attraction. Thus, we conducted this work to improve Droskidrink ® bait’s attractiveness using lactic acid bacteria. (2) Different baits that were based on the use of Droskidrink ® were assessed for flies’ attraction in a Droso-Trap ® in a vineyard. Oenococcus oeni, Pediococcus spp., and Lactobacillus spp. were used. The performance of the most attractive species, O. oeni, inoculated into Droskidrink ® was assessed in laboratory tests. The responses of female flies to volatiles produced by Droskidrink ® with O. oeni strains were recorded by electroantennography. (3) Preliminary field assessment of baits recorded O. oeni as the most attractive species. Three strain groups showed adaptation to test conditions. Volatiles extracted by the headspace of baits inoculated with O. oeni, elicited electroantennographic responses from fly antennae. (4) Droskidrink ® inoculated with O. oeni is a highly attractive bait for monitoring. These findings will be useful for improving the attractiveness of D. suzukii commercial baits based on the utilization of LAB volatiles in a strain-dependent manner.
Bianco C., Andreozzi A., Romano S., Fagorzi C., Cangioli L., Prieto P., Cisse F., Niangado O., Sidibé A., Pianezze S., Perini M., Mengoni A., Defez R. (2021). Endophytes from African rice (Oryza glaberrima L.) efficiently colonize Asian rice (Oryza sativa L.) stimulating the activity of its antioxidant enzymes and increasing the content of Nitrogen, Carbon, and Chlorophyll. Microorganisms, 9 (8): 1714.
Bacterial endophytes support the adaptation of host plants to harsh environments. In this study, culturable bacterial endophytes were isolated from the African rice Oryza glaberrima L., which is well-adapted to grow with poor external inputs in the tropical region of Mali. Among these, six N-fixer strains were used to inoculate O. glaberrima RAM133 and the Asian rice O. sativa L. cv. Baldo, selected for growth in temperate climates. The colonization efficiency and the N-fixing activity were evaluated and compared for the two rice varieties. Oryza sativa-inoculated plants showed a fairly good colonization efficiency and nitrogenase activity. The inoculation of Oryza sativa with the strains Klebsiella pasteurii BDA134-6 and Phytobacter diazotrophicus BDA59-3 led to the highest nitrogenase activity. In addition, the inoculation of ‘Baldo’ plants with the strain P diazotrophicus BDA59-3 led to a significant increase in nitrogen, carbon and chlorophyll content. Finally, ‘Baldo’ plants inoculated with Kl. pasteurii BDA1346 showed the induction of antioxidant enzymes activity and the maintenance of nitrogen-fixation under salt stress as compared to the unstressed controls. As these endophytes efficiently colonize high-yielding crop varieties grown in cold temperate climates, they become good candidates to promote their growth under unfavorable conditions.
Bontempo L., Bertoldi D., Franceschi P., Rossi F., Larcher R. (2021).
Elemental and isotopic characterization of tobacco from Umbria. Metabolites, 11 (3): 186.
Umbrian tobacco of the Virginia Bright variety is one of the most appreciated tobaccos in Europe, and one characterized by an excellent yield. In recent years, the Umbria region and local producers have invested in introducing novel practices (for production and processing) focused on environmental, social, and economic sustainability. Due to this, tobacco from Umbria is a leading commodity in the global tobacco industry, and it claims a high economic value.
The aim of this study is then to assess if elemental and isotopic compositions can be used to protect the quality and geographical traceability of this particular tobacco. For the first time the characteristic value ranges of the stable isotope ratios of the bio-elements as a whole (δ2H, δ13C, δ15N, δ18O, and δ34S) and of the concentration of 56 macro- and micro-elements are now available, determined in Virginia Bright tobacco produced in two different areas of Italy (Umbria and Veneto), and from other worldwide geographical regions. The ranges of variability of elements and stable isotope ratios had slightly different results, according to the three geographical origins considered. In particular, Umbria samples presented significantly lower content of metals potentially dangerous for human health. The results of this first exploratory work highlight the possibility of characterizing tobacco from Umbria, and suggest widening the scope of the survey throughout Italy and foreign regions, in order to be used to describe the geographical origin of tobacco in general and verify the origin of the products on the market.
In this study, the production of polyhydroxyalkanoated PHA-rich microbial biomass as a novel feed additive in aquaculture was investigated at a lab-scale. Bio-based volatile fatty acids (VFAs), obtained from the acidogenic fermentation of agricultural residues in existing anaerobic digestion plants, were used as carbon and energy to cultivate the PHA-rich microbial biomass. The experimental activities were carried out using Thauera sp. Sel9 as pure strain, which was grown in a continuous stirred-tank reactor (CSTR) operated at three different hydraulic retention times (HRT). The highest productivity obtained of biomass cells was 0.69 g/L day, operating at one day HRT while the observed PHAs production yield was 0.14 gPHA/g soluble COD removed. At these conditions, the PHA concentration in the microbial cells was 41%. Although the sulfur amino acids were available at high concentrations and above the typical concentration found in fishmeal, the amino acids profile of the obtained biomass revealed a lack of histidine and threonine. A preliminary economic analysis showed that the production of a novel source of feed additive from the conversion of agro-residues could give higher benefits in terms of revenues compared to the production of biogas production through anaerobic digestion.
Poultry by-products (PBM) and Hermetia illucens prepupae meal (HM) are promising alternative protein sources for aquafeeds, being palatable, nutritious, and/or cost-effective, in addition to fostering circular economy. Their inclusion in rainbow trout (Oncorhynchus mykiss) feeds, although not detrimental for growth and wellbeing, leads to a decreased fatty acid (FA) quality, specifically, a decreased polyunsaturated FA content. The present study assessed the effect of five different diets on rainbow trout’s biometric, marketable, and physical traits, oxidative status, fillet nutritional quality (of fresh and of 60-day stored fillets) and consumers’ liking. The diets tested were: i) a positive-control diet, based on fishmeal (CF); ii) a plant protein-based diet (CV) resembling current commercial diets, used as additional control; 60% of the vegetable proteins were substituted with either iii) PBM (P60), iv) HM (H60) or v) both PBM and HM (H10P50). The principal component analysis considering all parameters showed two neat clusters, one grouping CF samples, the other grouping the rest of the samples. Specifically, hepatosomatic index and colour were significantly altered by the different administered diets. The most evident differences between dietary treatments were found in the FA profile, with CF fish showing a distinct FA profile in comparison to the other groups. Although the highest eicosapentaenoic and docosahexaenoic acid contents were found in CF group, the total polyunsaturated FA content was not significantly different between the dietary treatments, as linoleic and linolenic acids were the lowest in the CF fillets (p < 0.001). Storage seemed to exacerbate the differences found imme-
Botturi A., Battista F., Andreolli M., Faccenda F., Fusco S., Bolzonella D., Lampis S., Frison N. (2021).
Polyhydroxyalkanoated-rich microbial cells from bio-based volatile fatty acids as potential ingredient for aquaculture feed. Energies, 14 (1): 38.
Bruni L., Secci G., Husein Y., Faccenda F., Lira de Medeiros A.C., Parisi G. (2021). Is it possible to cut down fishmeal and soybean meal use in aquafeed limiting the negative effects on rainbow trout (Oncorhynchus mykiss) fillet quality and consumer acceptance?. Aquaculture, 543: 736996.
Cainelli N., Forestan C., Angeli D., Roman Villegas T., Costa F., Botton A., Rasori A., Bonghi C., Ruperti B. (2021).
Transcriptomic insights on the preventive action of apple (cv Granny Smith) wkin wounding on superficial scald development.
International Journal of Molecular Sciences, 22 (24): 13425.
diately after slaughter. As a consequence of the FA profile, conjugated dienes were significantly (p < 0.05) higher in the CF group compared to all the others. MDA-eq. content, although unaffected by diet at day 0, was higher (p < 0.01) after 60 days of storage in the CF group compared to H60, P60, and H10P50 fillets. Consumer likings were favourable and not statistically different between the dietary groups. Only 20% of the consumers criticised the gustative attributes of P60 and H10P50, while almost 25% of them criticised CF, CV, and H60. In summary, the P60, H60 and H10P50 diets were not less than the commercial-like CV diet. Combining PBM and HM showed positive results and needs further studies. Improving the n-3/n-6 ratio remains a priority to be addressed when formulating aquafeeds with innovative ingredients.
Superficial scald is a post-harvest chilling storage injury leading to browning of the surface of the susceptible cv Granny Smith apples. Wounding of skins has been reported to play a preventive role on scald development however its underlying molecular factors are unknown. We have artificially wounded the epidermal and sub-epidermal layers of apple skins consistently obtaining the prevention of superficial scald in the surroundings of the wounds during two independent vintages. Time course RNA-Seq analyses of the transcriptional changes in wounded versus unwounded skins revealed that two transcriptional waves occurred. An early wave included genes up-regulated by wounding already after 6 h, highlighting a specific transcriptional rearrangement of genes connected to the biosynthesis and signalling of JA, ethylene and ABA. A later transcriptional wave, occurring after three months of cold storage, included genes up-regulated exclusively in unwounded skins and was prevented from its occurrence in wounded skins. A significant portion of these genes was related to decay of tissues and to the senescence hormones ABA, JA and ethylene. Such changes suggest a wound-inducible reversed hormonal balance during post-harvest storage which may explain the local inhibition of scald in wounded tissues, an aspect that will need further studies for its mechanistic explanation.
Celotti E., Osorio Barahona M.S., Bellantuono E., Cardona J., Roman T., Nicolini G., Natolino A. (2021).
High-power ultrasound on the protein stability of white wines: Preliminary study of amplitude and sonication time.
Lebensmittel-Wissenschaft + Technologie, 147: 111602.
White wines can be negatively affected by the formation of an undesirable protein haze. This sensory defect is prevented by specific fining agents, principally bentonite, which can negatively affect wine sensory characteristics through the removal of color and aroma compounds. Recent studies have focused on the potential application of ultrasound in the food industry, aimed to modify the protein conformations and functional properties for several purposes. The effect of amplitude (30%, 60%, and 90%) and sonication time (5 and 10 min) on the protein stability of two different white wines was evaluated and then compared with bentonite fining in this study. Significant effects of sonication were found. Higher amplitude and treatment time induced an increase in protein stability, confirmed by the lower heat test value (0.36 ± 0.14), comparable to that obtained after bentonite fining of untreated wine (0.12 ± 0.02). Positive effects were detected on protein charge neutralization and surface electrical charges, thus suggesting some positive conformational changes of wine proteins. Ultrasound could be considered as a technology to prevent protein precipitation and to reduce the quantity of fining agents used by wineries, but their effectiveness could be strictly related to the initial protein profile.
Cordin G., Messina G., Maresi G., Zottele F., Ferretti F., Montecchio L., Longa C.M. (2021).
Kretzschmaria deusta, a limiting factor for survival and safety of veteran beech trees in Trentino (Alps, Northern Italy).
IForest, 14 (6): 576-581.
The importance of veteran trees is well recognised nowadays. The sudden breakage of some of these plants in Trentino (Italy), mainly due to Kretzschmaria deusta, prompted a survey of the veteran beeches reported in this area. Visual tree assessment was carried out in 40 sites with either single trees or groups of beeches, for a total of 115 trees evaluated. Most trees showed serious defects or problems in need of management and 19 had a high level of risk of breakage because of the presence of several structural problems.
The presence of K. deusta was recorded on 50.4% of the examined trees. The pathogen was also identified in the proximity of investigated trees at 29 sites. Laboratory tests confirmed the identity of K. deusta by microbiological and molecular approaches and also identified Cosmopora berkeleyana as mycoparasite on K. deusta fruiting bodies. Isolates obtained from declining trees and old stumps showed the same pattern of growth at different temperatures. The risk evaluation emphasised how the fungus could affect the survival and safety of these veteran trees; this was confirmed by the collapse of four of the investigated trees in the last years. Therefore, K. deusta, which has been considered as a facultative parasite up to now, could play a more incisive role both in the decline of old beech trees and the natural evolution of aging beech woods.
Although coppice forests represent a significant part of the European forest area, especially across southern Countries, they received little attention within the Sustainable Forest Management (SFM) processes and scenarios, whose guidelines have been mainly designed to high forests and national scale. In order to obtain “tailored” information on the degree of sustainability of coppices on the scale of the stand, we evaluated (i) whether the main coppice management options result in different responses of the SFM indicators, and (ii) the degree to which the considered SFM indicators were appropriate in their application at stand level. The study considered three different management options (Traditional Coppice TC, coppice under Natural Evolution NE, and coppice under Conversion to high forest by means of periodical thinning CO). In each of the 43 plots considered in the study, which covered three different European Forest Types, we applied a set of eighteen “consolidated” SFM indicators, covering all the six SFM Criteria (FOREST EUROPE, 2020) and, additionally, tested other sixteen novel indicators shaped for agamic forests and/or applicable at stand level. Results confirmed that several consolidated indicators related to resources status (Growing stock and Carbon stock), health (Defoliation and Forest damage), and socio-economic functions (Net revenue, Energy and Accessibility) were highly appropriate for evaluating the sustainability of coppice at stand level. In addition, some novel indicators related to resources status (Total above ground tree biomass), health (Stand growth) and protective functions (Overstorey cover and Understorey cover) proved to be highly appropriate and able to support the information obtained by the consolidated ones. As a consequence, a subset of consolidated SFM indicators, complemented with the most appropriate novel ones, may represent a valid option to support the evaluation of coppice sustainability at stand level. An integrated analysis of the SFM indicators showed that NE and CO display significant higher environmental performances as compared with TC. In addition, CO has positive effects also on socio-economic issues, while TC -which is an important cultural heritage and a silvicultural option that may help to keep local communities engaged in forestry – combines high wood harvesting rates with dense understory cover. Overall, each of the three management options showed specific sustainability values; as a consequence, their coexistence at a local scale and in accordance with the specific environmental conditions and the social-economic context, is greatly recommended since it may fulfill a wider array of sustainability issues.
The spotted-wing drosophila (SWD), Drosophila suzukii Matsumura (Diptera: Drosophilidae), native to Eastern Asia, is an invasive alien species in Europe and the Americas, where it is a severe pest of horticultural crops, including soft fruits and wine grapes. The conventional approach to controlling infestations of SWD involves the use of insecticides, but the frequency of application for population management is undesirable. Consequently, alternative strategies are urgently needed. Effective and improved trapping is important as an early
Cutini A., Ferretti M., Bertini G., Brunialti G., Bagella S., Chianucci F., Fabbio G., Fratini R., Riccioli F., Caddeo C., Calderisi M., Ciucchi B., Corradini S., Cristofolini F., Cristofori A., Di Salvatore U., Ferrara C., Frati L., Landi S., Marchino L., Patteri G., Piovosi M., Roggero P.P., Seddaiu G., Gottardini E. (2021).
Testing an expanded set of sustainable forest management indicators in Mediterranean coppice area.
Ecological Indicators, 130: 108040.
Durovic G., Alawamleh A., Carlin S., Maddalena G., Guzzon R., Mazzoni V., Dalton D.T., Walton V.M., Suckling D.M., Butler R.C., Angeli S., De Cristofaro A., Anfora G. (2021).
Liquid baits with Oenococcus oeni increase captures of Drosophila suzukii Insects, 12 (1): 66.
El Hawari K., Al Iskandarani M., Jaber F., Ziller L., Perini M., Bontempo L., Pellegrini M., Camin F. (2021).
Evaluation of honey authenticity in Lebanon by analysis of carbon stable isotope ratio using elemental analyzer and liquid chromatography coupled to isotope ratio mass spectrometry. Journal of Mass Spectrometry, 56 (6): e4730.
risk detection tool. This study aimed to improve Droskidrink® (DD), a commercially available attractant for SWD. We focused on the chemical and behavioral effects of adding the bacterium Oenococcus oeni (Garvie) to DD and used a new trap design to enhance the effects of attractive lures. We demonstrate that microbial volatile compounds produced by O. oeni are responsible for the increase in the attractiveness of the bait and could be later utilized for the development of a better trapping system. Our results showed that the attractiveness of DD was increased up to two-fold by the addition of commercially available O. oeni when combined with an innovative trap design. The new trap-bait combination increased the number of male and especially female catches at low population densities.
Honey is one of the most valuable sweeteners consumed by humans all over the world. Consequently, it is often a target for adulteration through the addition of different sugar syrups during or after honey production, resulting in a reduction in its nutritive value. For the first time, this study analyzes honey samples of various botanical species collected from different Lebanese regions using element analyzer (EA) and liquid chromatography (LC) coupled with isotope ratio mass spectrometry (IRMS). The δ13C of bulk honey, its protein fraction, and the main individual sugars (glucose, fructose, disaccharides, and trisaccharide) were determined, in order to characterize and evaluate the authenticity of honey consumed in Lebanon. The results showed that the δ13C values for bulk honey and its protein range from −26.5‰ to −24.5‰ and from −26.4‰ to −24.7‰, respectively, for authentic samples. δ13C values for samples adulterated with sugar syrups range from −11.2‰ to −25.1‰ for bulk honey and from −26.6‰ to −23.7‰ for its proteins, with a difference between bulk and protein values between −1 and −8.7‰. Using LC-C-IRMS techniques, the δ13C of individual sugars provides additional information on the presence of undeclared sugars. We found that all authentic samples had Δδ13Cf-g and Δδ13C max values within the naturally occurring range of ±1‰ and ±2.1‰, respectively, while the adulterated samples fall outside the Δδ13C ranges. The oligosaccharide peak was detected in most adulterated samples.
Faralli M., Bianchedi P., Bertamini M., Varotto C. (2021).
Rootstock genotypes shape the response of cv. Pinot gris to water deficit. Agronomy, 11 (1): 75.
Understanding the physiological basis underlying the water stress responses in grapevine is becoming increasingly topical owing to the challenges that climate change will impose to grapevine agriculture. Here we used cv. Pinot gris (clone H1), grafted on a series of tolerant (1103Paulsen; P), sensitive (SO4) and recently selected (Georgikon28; G28, Georgikon121; G121, Zamor17; Z17) rootstocks. Plants were either subjected to reduced water availability (WS) or maintained at pot capacity (WW). Photosynthetic (light response curves), stomatal and in vivo gas exchange analysis were carried out as well as dynamics of daily water use (WU), leaf area accumulation with affordable RGB imaging pipelines and leaf water potential. Significant genotypic variation was recorded between rootstocks for most of the traits analyzed under optimal conditions with P and SO4 showing a more vigorous growth, higher CO2 assimilation rate, stomatal conductance and stomatal density per unit of leaf area than G28, G121, Z17 (p < 0.001). Under WS, rootstocks induced different water stress response in Pinot gris, with G28 and G121 showing a higher sensitivity of water use to reduced water availability (WS) (p = 0.021) and no variation for midday leaf water potential until severe WS. P, Z17 and to some extent SO4 induced a pronounced near-anisohydric response with a general WU maintenance followed by reduction in leaf water potential even at high levels of soil water content. In addition, G28 and G121 showed a less marked slope in the linear relationship between daily water use and VPD (p = 0.008) suggesting elevated sensitivity of transpiration to evaporative demand. This led to an insensitivity for total dry weight biomass of G28 and G121 under WS
conditions (p < 0.001). This work provides: (i) an in-depth analysis for a series of preferable traits under WS in Pinot gris; (ii) a characterization of Pinot gris × rootstock interaction and a series of desirable traits under WS induced by several rootstocks; (iii) the potential benefit for the use a series of affordable methods (e.g., RGB imaging) to easily detect dynamic changes in biomass in grapevine and quickly phenotype genotypes with superior responses under WS. In conclusion, the near-isohydric and conservative behavior observed for G28 and G121 coupled with their low vigor suggest them as potential Pinot gris rootstock candidates for sustaining grapevine productivity in shallow soils likely to develop terminal stress conditions.
The present investigation aimed to provide novel information on the chemical composition and in vitro bioaccessibility of bioactive compounds from raw citrus pomaces (mandarin varieties Clemenule and Ortanique and orange varieties Navel and Valencia). The effects of the baking process on their bioaccessibility was also assessed. Samples of pomaces and biscuits containing them as an ingredient were digested, mimicking the human enzymatic oral gastrointestinal digestion process, and the composition of the digests were analyzed. UHPLC-MS/MS results of the citrus pomaces flavonoid composition showed nobiletin, hesperidin/neohesperidin, tangeretin, heptamethoxyflavone, tetramethylscutellarein, and naringin/narirutin. The analysis of the digests indicated the bioaccessibility of compounds possessing antioxidant [6.6–11.0 mg GAE/g digest, 65.5–97.1 µmol Trolox Equivalents (TE)/g digest, and 135.5–214.8 µmol TE/g digest for total phenol content (TPC), ABTS, and ORAC-FL methods, respectively; significant reduction (p < 0.05) in Reactive Oxygen Species (ROS) formation under tert-butyl hydroperoxide (1 mM)-induced conditions in IEC-6 and CCD-18Co cells when pre-treated with concentrations 5–25 µg/mL of the digests], anti-inflammatory [significant reduction (p < 0.05) in nitric oxide (NO) production in lipopolysaccharide (LPS)-induced RAW264.7 macrophages], and antidiabetic (IC50 3.97–11.42 mg/mL and 58.04–105.68 mg/mL for α-glucosidase and α-amylase inhibition capacities) properties in the citrus pomaces under study. In addition, orange pomace biscuits with the nutrition claims “no-added sugars” and “source of fiber”, as well as those with good sensory quality (6.9–6.7, scale 1–9) and potential health promoting properties, were obtained. In conclusion, the results supported the feasibility of citrus pomace as a natural sustainable source of health-promoting compounds such as flavonoids. Unfractionated orange pomace may be employed as a functional food ingredient for reducing the risk of pathophysiological processes linked to oxidative stress, inflammation, and carbohydrate metabolism, such as diabetes, among others.
Sustainability of aquaculture is tied to the origin of feed ingredients. In search of sustainable fish meal-free formulations for rainbow trout, we evaluated the effect of Hermetia illucens meal (H) and poultry by-product meal (P), singly (10, 30, and 60% of either H or P) or in combination (10% H + 50% P, H10P50), as partial replacement of vegetable protein (VM) on gut microbiota (GM), inflammatory, and immune biomarkers. Fish fed the mixture H10P50 had the best growth performance. H, P, and especially the combination H10P50 partially restored α-diversity that was negatively affected by VM. Diets did not differ in the Firmicutes:Proteobacteria ratio, although the relative abundance of Gammaproteobacteria was reduced in H and was higher in P and in the fishmeal control. H had higher relative abundance of chitin-degrading Actinomyces and Bacillus, Dorea, and Enterococcus. Actinomyces was also higher in H feed, suggesting feed-chain microbiome transmission. P increased the relative abundance of protein degraders Paeniclostridium and Bacteroidales. IL-1β, IL-10, TGF-β, COX-2, and TCR-β gene expression in the midgut and head kidney and
Fernández-Fernández A.M., Dellacassa E., Nardin T., Larcher R., Gámbaro A., Medrano-Fernandez A., Del Castillo M.D. (2021).
In Vitro bioaccessibility of bioactive compounds from Citrus pomaces and orange pomace biscuits. Molecules, 26 (12): 3480.
Gaudioso G., Marzorati G., Faccenda F., Weil T., Lunelli F., Cardinaletti G., Marino G., Olivotto I., Parisi G., Tibaldi E., Tuohy K.M., Fava F. (2021).
Processed animal proteins from insect and poultry by-products in a fish meal-free diet for rainbow trout: impact on intestinal microbiota and inflammatory markers. International Journal of Molecular Sciences, 22 (11): 5454.
Giannett D., Schifani E., Castracani C., Ghizzoni M., Delaiti M., Penner F., Spotti F.A., Mori A., Ioriatti C., Grasso D.A. (2021).
Assessing ant diversity in agroecosystems: the case of Italian vineyards of the Adige valley.
Redia, 104: 97-109.
Guzzon R., Roman T., Larcher R., Francesca N., Guarcello R., Moschetti G. (2021).
Biodiversity and oenological attitude of Saccharomyces cerevisiae strains isolated in the Montalcino district: biodiversity of S. cerevisiae strains of Montalcino wines.
FEMS Microbiology Letters, 368 (2): fnaa202.
plasma lipopolysaccharide (LPS) revealed that the diets did not compromise the gut barrier function or induce inflammation. H, P, and H10P50 therefore appear valid protein sources in fishmeal-free aquafeeds.
Agroecosystems have gained a dominant position on worldwide land-usage, and therefore preserving their biodiversity is crucial for environmental sustainability. Ants are one of the most widespread groups of terrestrial arthropods, and, thanks to their significant diversification, they are considered as a good proxy group for biodiversity monitoring, also in agroecosystems. Vineyards are economically valuable cultures widespread worldwide, and hosting many ant species, that provide meaningful ecosystem services and disservices. Despite the important role that ants play in these agroecosystems, ant biodiversity in vineyards is still poorly studied, especially in Italy. In this context, we present a first detailed quantitative and qualitative assessment of the ant fauna of Italian vineyards from the Adige Valley based on pitfall traps data, and discuss the results in comparison with the few other similar assessments from Europe and other continents. We document an assemblage of 22 species (7-16 per orchard), mostly dominated by three disturbance-tolerant species (including an introduced species). Vineyards’ ant faunas appear to be rather heterogeneous worldwide, mainly following local ecological and biogeographical constraints, and the role that most ant species play in these agroecosystems is presently unknown.
The biodiversity of Saccharomyces cerevisiae was studied in the Montalcino area (Italy). Two wineries were involved in the study, which compared the genotypic and oenological characteristics of the S. cerevisiae strains isolated in spontaneous fermentations. After isolation yeasts were identified by 26S rRNA gene sequence analysis, and S. cerevisiae strains were characterized through interdelta sequence analysis (ISA). Oenological tests were performed in synthetic grape must by varying the magnitude of the main wine-imiting factors. The evolution of alcoholic fermentation was monitored by measuring sugar consumption and flow cytometry. The results revealed the prevalence of S. cerevisiae from the third day of fermentation and the presence of a wide range of S. cerevisiae strains having ISA profiles characteristic of each winery. From an oenological point of view, the features of such strains, in terms of resistance to wine-limiting factors, seemed to be linked to the main oenological variables applied in the production process of each winery. Extreme fermentation temperatures and copper residues are the variables that mostly depress the yeast population, in terms of fermentation rate and cell viability. Flow cytometry revealed the different impact of limiting factors on the viability of yeast by the quantification of the ratio between live/dead yeast cells of each strain, suggesting different mechanisms of inhibition, for instance stuck of cell growth or cell killing, in response to the different stress factors.
Khatri P.K., Larcher R., Camin F., Ziller L., Tonon A., Nardin T., Bontempo L. (2021).
Stable isotope ratios of herbs and spices commonly used as herbal infusions in the Italian market.
ACS Omega, 6 (18): 11925-11934.
Stable isotope ratio analysis has been widely used for traceability and authenticity purposes in relation to various food commodities, but only in a limited number of herb and spice species. This study explored the stable isotope ratios of carbon, nitrogen, sulfur, oxygen, and hydrogen (δ13C, δ15N, δ34S, δ18O, and δ2H) of 119 herbs and spices belonging to 116 plant species and 57 plant families collected from the Italian market for the first time. The characteristic value ranges of δ13C, δ15N, δ34S, δ18O, and δ2H of the herbs and spices went from −31.0 to −11.6, −4.7 to 12.0, −5.0 to 22.0, 14.7 to 46.0, and −158 to −12‰, respectively. The isotopic profiles within and between common botanical families and their similarity/dissimilarity between herbs and spices belonging to the common botanical families are also discussed here. The results of this exploratory work highlight the possibility of characterizing herbs and spices and
suggest widening the scope of the survey through more extensive sampling and focusing on specific plant species.
Drosophila suzukii, or spotted-wing drosophila, is now an established pest in many parts of the world, causing significant damage to numerous fruit crop industries. Native to East Asia, D. suzukii infestations started in the United States (U.S.) a decade ago, occupying a wide range of climates. To better understand invasion ecology of this pest, knowledge of past migration events, population structure, and genetic diversity is needed. In this study, we sequenced whole genomes of 237 individual flies collected across the continental U.S., as well as several sites in Europe, Brazil, and Asia, to identify and analyze hundreds of thousands of genetic markers. We observed strong population structure between Western and Eastern U.S. populations, but no evidence of any population structure between different latitudes within the continental U.S., suggesting there is no broad-scale adaptations occurring in response to differences in winter climates. We detect admixture from Hawaii to the Western U.S. and from the Eastern U.S. to Europe, in agreement with previously identified introduction routes inferred from microsatellite analysis. We also detect potential signals of admixture from the Western U.S. back to Asia, which could have important implications for shipping and quarantine policies for exported agriculture. We anticipate this large genomic dataset will spur future research into the genomic adaptations underlying D. suzukii pest activity and development of novel control methods for this agricultural pest.
The body of knowledge in trout farming sustainability is still not exhaustive, mainly due to the variability in the production system and in the methodological approach and partly to data quality issues. As such, Life Cycle Assessment (LCA) was applied to a trout supply chain located in Northern Italy, basing the inventory dataset almost entirely on primary data gathered from producers and extending the system boundaries beyond the conventional farm-gate, in order to include: phase 1. feed production; phase 2. trout grow-out in freshwater flow-through systems; phase 3. trout processing into foodstuff; phase 4. fish by-products processing into pet-food ingredients. The results highlight that, while resource sharing in phase 3 is a winning practice and leads to decrease in environmental impacts, the other three phases present crucial aspects which require either technological or methodological improvements. Firstly, the relative contribution of feed ingredients is very high, with respect to all the impact categories considered. Secondly, despite on-farm effluents account alone for 92% of downstream river eutrophication (phase 2), data from rivers environmental monitoring prove this result to be an overestimation, due to the fact that LCA does not adequately cover proximate ecological concerns as yet. Finally, the energy demand for the recovery and recycling of the fish by-products (phase 4) is high, causing a high impact on global warming, terrestrial ecotoxicity, freshwater ecotoxicity and cumulative energy demand. In order to improve the overall sustainability of the supply chain, changes are required mainly in the feed production and by-product processing phases. As far as the former is concerned, a winning strategy would be the formulation of feeds with more sustainable feed ingredients and further improvements in the feed quality (palatability, digestibility, nutritional content). In regard to the latter, more attention should be paid towards the source and amount of energy consumed. For instance, the use of renewable energy sources might be coupled with an improved insulation of the facilities and the use of less energivorous machineries/processes.
Lewald K.M., Abrieux A., Wilson D.A., Lee Y., Conner W.R., Andreazza F., Beers E.H., Burrack H.J., Daane K.M., Diepenbrock L., Drummond F.A., Fanning P.D., Gaffney M.T., Hesler S.P., Ioriatti C., Isaacs R., Little B.A., Loeb G.M., Miller B., Nava D.E., Rendon D., Sial A.A., da Silva C.S.B., Stockton D.G., Van Timmeren S., Wallingford A., Walton V.M., Wang X., Zhao B., Zalom F.G., Chiu J.C. (2021). Population genomics of Drosophila suzukii reveal longitudinal population structure and signals of migrations in and out of the continental United States. G3, 11 (12): jkab343.
Maiolo S., Forchino A.A., Faccenda F., Pastres R. (2021).
From feed to fork: life cycle assessment on an Italian rainbow trout (Oncorhynchus mykiss) supply chain. Journal of Cleaner Production, 289: 125155.
Martinez-Sañudo I., Perin C., Cavaletto G., Ortis G., Fontana P., Mazzon L. (2021).
Studying genetic population structure to shed light on the demographic explosion of the rare species Barbitistes vicetinus (Orthoptera, Tettigoniidae).
PLOS ONE, 16 (5): e0250507.
Insect outbreaks usually involve important ecological and economic consequences for agriculture and forestry. The short-winged bush-cricket Barbitistes vicetinus Galvagni & Fontana, 1993 is a recently described species that was considered rare until ten years ago, when unexpected population outbreaks causing severe defoliations across forests and crops were observed in north-eastern Italy. A genetic approach was used to analyse the origin of outbreak populations. The analysis of two mitochondrial regions (Cytochrome Oxidase I and II and 12S rRNA-Control Region) of 130 samples from the two disjunct ranges (Euganean and Berici Hills) showed high values of haplotype diversity and revealed a high geographical structure among populations of the two ranges. The high genetic variability observed supports the native origin of this species. In addition, results suggest that unexpected outbreaks are not a consequence of a single or few pestiferous haplotypes but rather the source of outbreaks are local populations which have experienced an increase in each area. The recent outbreaks have probably appeared independently of the genetic haplotypes whereas environmental conditions could have affected the outbreak populations. These findings contribute to a growing understanding of the status and evolutionary history of the pest that would be useful for developing and implementing biological control strategies for example by maximizing efforts to locate native natural enemies.
Moricca S., Benigno A., Longa C., Cacciola S.O., Maresi G. (2021).
First documentation of life cycle completion of the alien rust pathogen Melampsoridium hiratsukanum in the Eastern Alps proves its successful establishment in this mountain range.
Journal of Fungi, 7 (8): 617.
Melampsoridium hiratsukanum is an alien rust fungus which has spread pervasively throughout several European countries following introduction into North Europe at the end of the 20th century. The authenticity of several records of the Melampsoridium species infecting alder (Alnus spp.) in the northern hemisphere is questionable, due to the misidentification and confusion that surround many of the older reports. Given this complicated taxonomic history, and since a M. hiratsukanum-like rust is strongly impacting Alnus incana stands in the Alps, probably affecting the bank protection role of this species along rivers, the unambiguous identification of this pathogen was a pressing epidemiological and ecological issue. In this study, field surveys, light (LM) and scanning electron microscopy (SEM), and molecular characterization were put together in an attempt to solve the conundrum. Field monitoring data, LM and SEM analyses of key taxonomic traits (length of ostiolar cells of uredinium, uredinio-spore shape and size, spore echinulation, number and position of germ pores) and ITS-rDNA sequence-based identification, convergently and unambiguously connected the rust that is causing the current epidemic to the non-native M. hiratsukanum. We documented the completion of the M. hiratsukanum life cycle on its two taxonomically unrelated broadleaf/conifer hosts. This is the first report of M. hiratsukanum from naturally infected Larix decidua in Europe.
Multari S., Guzzon R., Caruso M., Licciardello C., Martens S. (2021).
Alcoholic fermentation of citrus flavedo and albedo with pure and mixed yeast strains: physicochemical characteristics and phytochemical profiles.
Lebensmittel-Wissenschaft + Technologie, 144: 111133.
The present study aimed to investigate the effects of alcoholic fermentation on the physicochemical and phytochemical characteristics of the tissues flavedo and albedo from five citrus fruits, namely grapefruit (Citrus paradisi), lemon (Citrus limon), and sweet oranges (Citrus sinensis) cvs. ‘Tarocco’, ‘Washington navel’, and ‘Moro’. The tissues were fermented with pure and mixed cultures of Saccharomyces cerevisiae, Brettanomyces bruxellensis, and Torulaspora delbrueckii. Flavedo and albedo increased the water holding capacity (WHC) and oil binding capacity (OBC) when subjected to fermentation. The treatment with B. bruxellensis resulted the most effective at enhancing WHC and OBC, e.g., lemon flavedo achieved the highest WHC (9.67 ± 0.15 g/g, P < 0.001). Concerning the phytochemicals, samples increased the total contents of phenolic compounds and carotenoids upon fermentation. The orange ‘Tarocco’ benefited markedly as regards phenolic compounds, e.g., the naringenin and hesperidin contents reached 244 ± 15.5 and 2900 ± 160 mg kg−1 DW, respectively, when
the albedo was fermented with T. delbrueckii, with increases above 4-folds. Likewise, the total carotenoids were augmented (P < 0.001) when flavedo samples were treated with T. delbrueckii. Overall, the performed alcoholic fermentations ameliorated the physicochemical and phytochemical characteristics of the selected citrus tissues, and are recommended to expand their utilization in the nutraceutical sector.
The stable isotopes of five bio-elements (δ13C, δ15N, δ34S, δ2H, δ18O) and the elemental composition profile combined with chemometrics were used to differentiate the geographical origin of commercial samples of mango, aimed at contributing to the existence of a Spanish protected geographical indication (PGI). Eighty commercial mangoes from all over the world (Spain, Mexico, Peru, Brazil, Ivory Coast, Equatorial Guinea and Senegal), collected during two consecutive harvests, were analysed and assessed by means of univariate and multivariate data analyses, establishing the main variation sources linked to the origin of the mangoes. The data obtained from each analytical platform were assessed separately and in combination, resulting in three models whose discriminatory power (Spanish vs others) was compared. The model fitted for the stable isotope approach yielded a sensitivity of 100%, meaning that the Spanish mangoes were correctly classified in all the cases, against the 97.6% for multi-element analysis. The combined use of stable isotopes and elemental composition led to the most accurate geographical discrimination of Spanish mangoes, making it possible to select three stable isotope ratios (δ15N, δ18O, δ34S) and six elements (Cd, Se, Cs, As, Pb and Ba) as the main indicators of the geographic origin of mango. The results of this study revealed the feasibility of tracing the provenance of mango through either of the two analytical strategies or by combining them to obtain a more accurate classification.
Nowadays the most important issues for commercial SOFC systems are related to their durability and stability of performance both of which are affected by fuel feeding composition. The trace compounds contained in biogenous fuels can interact with SOFC components causing evident drops in performance and severely reducing the lifetime of the entire system. Due to the significant impact on SOFC performance from widely varying fuel inputs, the influence of trace compounds should be investigated in real case studies and practical applications. Anode deactivation and porous blocking electrodes are the main consequences that occur due to the presence of trace compounds impact. This work shows an experimental case study where the anode supported solid oxide fuel cells short stacks are fed with fuels containing trace compounds. These compounds were selected from the biological decomposition of organic matters. In addition, sulphur compounds were selected chlorine, aromatic compounds, terpenes, and carboxyl compounds were selected. The most deleterious impact on the stack was due to the sulphur action. However, chlorine compounds also affected the external part of the cell causing the stack to break due to the corrosion of the sealant.
The purpose of this study was to address the lack of knowledge regarding the stable isotopic composition of beef from zebu cattle reared in tropical Africa. Sixty beef carcasses belonging to the most common zebu breeds (Goudali, white Fulani, and red Mbororo) were selected and classified according to their subcutaneous fat color (white, cream or yellow). The stable isotope ratios of five bioelements-H, O, C, N, and S-in muscle fractions and the fatty acids composition were analyzed. Zebu meat from Cameroon shows peculiar δ13C values, related to the almost exclusive intake of grazed tropical grasses with photosynthetic cycle C4. It also shows δ2H and δ18O values higher than those reported in other areas of the world and correlated with the isotopic composi-
Muñoz-Redondo J.M., Bertoldi D.; Tonon A., Ziller L., Camin F., Moreno-Rojas J.M. (2021). Tracing the geographical origin of Spanish mango (Mangifera indica L.) using stable isotopes ratios and multielement profiles.
Food Control, 125: 107961.
Papurello D., Silvestri S., Modena S. (2021). Biogas trace compounds impact on high-temperature fuel cells short stack performance.
International Journal of Hydrogen Energy, 46(12): 8792-8801.
Perini M., Nfor M.B., Camin F., Pianezze S., Piasentier E. (2021).
Using bioelements isotope ratios and fatty acid composition to deduce beef origin and zebu feeding regime in Cameroon.
Molecules, 26 (8): 2155.
Perini M., Pianezze S., Ziller L., Camin F. (2021).
Characterization of L-theanine in tea extracts and synthetic products using Stable Isotope Ratio Analysis.
Yàowù Shípin Fenxi, 29 (2): 312-319.
tion of animal drinking water. The white subcutaneous fat (“white type”) zebu showed higher δ2H and lower δ13C than the “yellow type”, that is correlated with a higher content of polyunsaturated fatty acid (PUFA) and a lower amount of saturated fatty acid (SFA) and monounsaturated fatty acid (MUFA). Multielement analysis seems to provide promising results for tracing the regional origin of Cameroon beef and some aspects of the livestock system, such as the nutritional status of the animals.
L-theanine involves a great number of health benefits and dietary supplements containing this molecule are becoming increasingly popular. There is, therefore, a growing need to find ways to discriminate between natural L-theanine extracted from tea leaves and the cheaper, synthetic one obtained using specific bacterial enzymes. A first attempt of stable isotope ratio analysis characterization of the possible synthetic adulterant L-theanine (δ13C of -14.3±1.5‰), obtained from vegetable substrates with C4 photosynthetic cycle, and of the more expensive natural L-theanine (δ13C of -24.4±1.3‰), extracted from Camellia sinensis plants with C3 photosynthetic cycle, is reported here.
Pianezze S., Camin F., Perini M., Corazzin M., Piasentier E. (2021).
Tracing lamb meat with stable isotope ratio analysis: a review.
Small Ruminant Research, 203: 106482.
The analysis of stable isotopes applied to the lamb meat matrix is recognized as a technique of choice not only for geographical traceability but also for verifying the correspondence between the diet provided and the prescribed one. Indeed, a large amount of information is stored in animal tissues in terms of stable isotopes relative abundances of different elements. The purpose of this review is to critically analyze all the studies carried out on lambs, focusing in particular on the isotope ratios of carbon, nitrogen, sulfur, hydrogen and oxygen of different matrices, trying to define the different ranges of variability based on the origin and diet of the lambs. Carbon is certainly the most useful for identifying the animal diet while oxygen and hydrogen confirm their ability to geographically discriminate lambs. Overall, the results of statistical models validating isotope traceability systems can reach and exceed 90% of accuracy.
Pianezze S., Corazzin M., Perini M., Camin F., Paolini M., Sepulcri A., Saccà E., Fabro C., Piasentier E. (2021).
Fatty acids stable carbon isotope fractionation in the bovine organism. A compound-specific isotope analysis through gas chromatography combustion isotope ratio mass spectrometry.
Journal of Chromatography A, 1641: 461966.
The contribution of dietary fatty acids to the quality of the meat and their path through the bovine organism is currently the subject of a lot of research. Stable isotope ratio analysis represents a powerful tool for this aim, one that has not been studied in depth yet. In this work, for the first time, the carbon isotopic ratios of six fatty acids (myristic 14:0, palmitic 16:0, stearic 18:0, oleic 18:1n-9, linoleic 18:2n-6 and linolenic 18:3n-3 acids) in different matrixes (diet, rumen, duodenal content, liver and loin) were analysed through gas chromatography combustion isotope ratio mass spectrometry. Moreover, the quantification of the single fatty acids was carried out, providing important information supporting the carbon isotopic ratio results. The variation in the concentration of the fatty acids in the different matrices depends on the chemical modifications they undergo in the sequential steps of the metabolic path. GC-C-IRMS turned out to be a powerful tool to investigate the fate of dietary fatty acids, providing information about the processes they undergo inside the bovine organism.
Pianezze S., Perini M., Bontempo L., Piasentier E., Poma G., Covaci A., Camin F. (2021).
Stable isotope ratio analysis for the characterisation of edible insects.
Journal of Insects as Food and Feed 7 (6): 955-964.
Entomophagy, or the act of eating insects, has been practiced since ancient times, but it started to gain more popularity, especially in Western countries, only recently. As sustainability is one of the current emerging themes, the inclusion of insects in our diet is a valid alternative that might help reduce the amount of water and land used for livestock and the associated emissions of greenhouse gasses. Moreover, insects are a source of protein, fibres, vitamins, minerals and fats. Edible insects are considered a novel food, for which no isotopic reference values are yet available. In the present work, samples of farmed edible insects (n=40) belonging to different orders (namely, Coleop-
tera, Hemiptera, Hymenoptera, Lepidoptera, Odonata and Orthoptera) and insect-based food items (n=4) for human consumption were analysed. The following isotopes, δ13C, δ15N, δ34S, δ18O and δ2H of the defatted samples, together with the δ13C of the fat, were investigated. The aim of the work was to provide the first reference isotopic ratios that can be used for future investigations in the food quality field. The variability of these parameters was dependent on the life stage and diet of insects, their geographical origin, and the addition of ingredients as seasoning.
The amount of ingredients of marine origin used in salmonid feed industry is rapidly decreasing and fish meal and fish oil have been largely replaced by vegetable ingredients. New potential protein rich ingredients for aquafeed formulations should therefore be alternative to vegetable ones. The pattern of fillet pigmentation was thus assessed in rainbow trout (Oncorhynchus mykiss) fed for 15 weeks isoproteic (42%) and isolipidic (24%) diets deprived of fish meal where 10% of protein from a blend of vegetable ingredients was replaced by cyanobacteria and microalgae dried biomass ( Arthrospira platensis, Tisochrysis lutea and Tetraselmis suecica) or Louisiana red swamp crayfish (Procambarus clarkii ) meal. An automatic, repeatable, and objective image analysis tool for the integrated determination and direct visualization of fillet colour was applied to digital images. Colour of fillets was also measured with a chromameter, recording data as L*, a*, b* indexes and used to validate image analysis results. Fillet carotenoid and lipid contents were determined, and their pattern of variation was compared to that obtained by image analysis. Fillet colouring capacity of crayfish meal was also compared to that of commercial synthetic astaxanthin included in rainbow trout feed. To this last aim, test diets were administered for 12 additional weeks. The image analysis and colorimetric data consistently indicated that, even if characterized by a significantly higher carotenoid content respect to fish fed a vegetable diet, fillets of trout fed the cyanobacteria and microalgae including diets displayed an undesirable yellowish colour. P. clarkii meal instead resulted a promising functional ingredient to supplement plant protein-based diets for trout, in view of its lipid composition and astaxanthin content. In fact, despite a relatively low dietary carotenoid level due to low percentage of inclusion, a desirable pink pigmentation was clearly detectable in fillets of trout fed the crayfish meal-including diet, which resulted in colour differences which were less obvious relative to those of fish given the astaxanthin-supplemented feeds at the end of the additional 12 weeks.
In the last decades, processed animal proteins, such as poultry by-product meal (PBM) and insect meals have received great attention as sustainable and nutritious aquafeed ingredients. The aim of the present study was to evaluate growth performances, liver and gut histology, macromolecular composition and inflammatory response in rainbow trout (Oncorhynchus mykiss) fed diets deprived of fish meal, where graded levels of vegetable protein-rich ingredients, were replaced by defatted Hermetia illucens pupae meal (HM) or PBM, singly or in combination. To this end eight grossly iso-proteic (45% DM), isolipidic (26% DM) and isoenergetic (23.5 MJ/kg DM) were offered each to triplicated groups of juveniles’ fish in a 91 days feeding trial. A diet rich in vegetable protein derivatives high in soybean meal (CV) was prepared to have a 10:90 and 20:80 fish to vegetable protein and lipid ratios respectively. By contrast, a fish-based diet (CF) was formulated with opposite fish to vegetable protein and lipid ratios. Six more diets, were obtained by replacing graded levels of protein (10, 30 and 60%) of diet CV, by protein from a defatted Hermetia illucens pupae meal and/or poultry by-product meal, singly or combined, while maintaining the same vegetable to fish lipid ratio as in the CV diet. Relative
Pulcini D., Capoccioni F., Franceschini S., Martinoli M., Faccenda F., Secci G., Perugini A., Tibaldi E., Parisi G. (2021).
Muscle pigmentation in rainbow trout (Oncorhynchus mykiss) fed diets rich in natural carotenoids from microalgae and crustaceans.
Aquaculture, 543: 736989.
Randazzo B., Zarantoniello M., Gioacchini G., Cardinaletti G., Belloni A., Giorgini E., Faccenda F., Cerri R., Tibaldi E., Olivotto I. (2021).
Physiological response of rainbow trout (Oncorhynchus mykiss) to graded levels of Hermetia illucens or poultry by-product meals as single or combined substitute ingredients to dietary plant proteins.
Aquaculture, 538: 736550.
Royer E., Faccenda F., Pastres R. (2021). Estimating oxygen consumption of rainbow trout (Oncorhynchus mykiss) in a raceway: a precision fish farming approach.
Aquacultural Engineering, 92: 102141.
to diets CV and CF, a medium to high substitution (30 and 60%) of dietary vegetable protein-rich ingredients, with HM and/or PBM resulted in improved growth performance as well as in a minor incidence of distal intestine morphological alterations. The diet including both the test animal proteins led to nearly the best overall response in terms of growth and gut/liver health. Both HM and PBM when included at moderate or high levels in the diet, resulted in a downregulation of the expression of inflammatory-related genes relative to diet CV. This effect was greater with HM than that observed with PBM and goes beyond the parallel reduction of vegetable protein and SBM levels in the same diets, suggesting a beneficial role of insect meal that warrant further investigation. The results obtained so far, provide support to a reliable use of alternative/underexploited protein and lipid sources [(HM) or (PBM)] in developing a new generation of sustainable and healthy trout diets that meet the circular economy principles.
The Precision Fish Farming (PFF) approach was applied to the estimation of fish oxygen consumption of rainbow trout in a raceway farm. A dynamic model, simulating the evolution of Dissolved Oxygen concentration, was identified: the daily oscillation of fish oxygen consumption rate was simulated by means of a sinusoidal function. The model was applied to the data set collected during a four-week field study, which was carried out in July 2019. Water temperature and Dissolved Oxygen concentration were measured with an hourly frequency in farm influent and effluent. Fish biomass was monitored on a daily basis by combining the data provided by a state-of-the art system for non-invasive estimation of fish weight distribution with mortality counting. The monitoring period was partitioned into two time-windows, as fish was not fed during the first two weeks. These windows were further partitioned into a calibration and validation set. Three model parameters, i.e. the average daily respiration rate, the amplitude of its daily oscillation, and its phase were estimated by fitting the model output to the time series of DO concentration in the effluent. The results of the calibration show that: 1) the daily average oxygen consumption rate is consistent with the literature; 2) the amplitude of the daily oscillation when fish is regularly fed is more than twice that estimated for fasting fish. The results of the validation suggest that the model could be used to implement a cost-effective automatic control of oxygen supply, based on the short-term prediction of oxygen demand.
Smodiš Škerl, M.I., Rivera-Gomis, J., Tlak Gajger, I., Bubniˇc, J., Talaki´c, G., Formato, G., Baggio, A., Mutinelli, F., Tollenaers, W., Laget, D., Malagnini, V., Zanotelli, L., Pietropaoli, M. (2021). Efficacy and toxicity of VarroMed® used for controlling Varroa destructor Infestation in different seasons and geographical areas.
Applied Sciences, 11 (18): 8564.
Tait G., Mermer S., Stockton D.; Lee J.; Avosani S.; Abrieux A.; Anfora G.; Beers E.; Biondi A.; Burrack H.; Cha D.; Chiu J.C.; Choi M.; Cloonan K.; Crava C.M.; Daane K.M.; Dalton D.T.; Diepenbrock L.; Fanning P.; Ganjisaffar F.; Gómez M.I., Gut L., Grassi A., Hamby K., Hoelmer K.A., Ioriatti C., Isaacs R., Klick J., Kraft L., Loeb G., Rossi-Stacconi M.V.,
VarroMed® is a soft acaricide registered for honey bees on the European Union market since 2017 for Varroa control. Researchers involved were partners of different countries of the Varroa control task force of the COLOSS Association. Our goal was to evaluate performances (acaricide efficacy and toxic effects on honey bees) of VarroMed® in different climatic conditions. Our results in the tested apiaries showed an efficacy ranging from 71.2 to 89.3% in summer/autumn, and from 71.8 to 95.6% in winter. No toxic effects on bees were observed, except in one apiary, where severe cold climatic conditions played a crucial role. The treatment could be efficiently applied in broodright as well as in broodless colonies. Integrated pest management (IPM) recommendations for beekeepers are provided in order to apply the best Varroa control protocol.
Drosophila suzukii (Matsumura) (Diptera: Drosophilidae) also known as spotted-wing drosophila (SWD), is a pest native to Southeast Asia. In the last few decades, the pest has expanded its range to affect all major European and American fruit production regions. SWD is a highly adaptive insect that is able to disperse, survive, and flourish under a range of environmental conditions. Infestation by SWD generates both direct and indirect economic impacts through yield losses, shorter shelf life of infested fruit, and increased pro-
duction costs. Fresh markets, frozen berries, and fruit export programs have been impacted by the pest due to zero tolerance for fruit infestation. As SWD control programs rely heavily on insecticides, exceedance of maximum residue levels (MRLs) has also resulted in crop rejections. The economic impact of SWD has been particularly severe for organic operations, mainly due to the limited availability of effective insecticides. Integrated pest management (IPM) of SWD could significantly reduce chemical inputs but would require substantial changes to horticultural management practices. This review evaluates the most promising methods studied as part of an IPM strategy against SWD across the world. For each of the considered techniques, the effectiveness, impact, sustainability, and stage of development are discussed.
This research details the development of a novel LC-MS/MS method involving a QuEChERS-based extraction that, for the first time, achieves the fast and concurrent analysis of both free varietal thiols (3-sulfanylhexan-1-ol, 3-sulfanylhexyl acetate, and 4-methyl-4-sulfanylpentan-2-one) and their S-glutathionylated/S-cysteinylated precursors in wine samples. Limits of detections for the free thiols were comparable to or lower than those obtained with previously reported more laborious methods. Repeatability for the free thiols ranged between 3–19% and from 0.1–7.7% for the thiol precursors. The method was subsequently applied to the analysis of a selection of 22 wines from a range of different grape varieties. The rapidity of this method combined with its sensitivity makes it suitable for both research and industry applications.
The assessment of pesticide risks to insect pollinators have typically focused on short-term, lethal impacts. The environmental ramifications of many of the world’s most commonly employed pesticides, such as those exhibiting systemic properties that can result in long-lasting exposure to insects, may thus be severely underestimated. Here, seven laboratories from Europe and North America performed a standardised experiment (a ring-test) to study the long-term lethal and sublethal impacts of the relatively recently approved ‘bee safe’ butenolide pesticide flupyradifurone (FPF, active ingredient in Sivanto ®) on honey bees. The emerging contaminant, FPF, impaired bee survival and behaviour at field-realistic doses (down to 11 ng/bee/day, corresponding to 400 µg/kg) that were up to 101-fold lower than those reported by risk assessments (1110 ng/bee/day), despite an absence of time-reinforced toxicity. Our findings raise concerns about the chronic impact of pesticides on pollinators at a global scale and support a novel methodology for a refined risk assessment.
Background. Understanding the complexity of the vine plant’s response to water deficit represents a major challenge for sustainable winegrowing. Regulation of water use requires a coordinated action between scions and rootstocks on which cultivars are generally grafted to cope with phylloxera infestations. In this regard, a genome-wide association study (GWAS) approach was applied on an ‘ad hoc’ association mapping panel including different Vitis species, in order to dissect the genetic basis of transpiration-related traits and to identify genomic regions of grape rootstocks associated with drought tolerance mechanisms. The panel was genotyped with the GrapeReSeq Illumina 20 K SNP array and SSR markers, and infrared thermography was applied to estimate stomatal conductance values during progressive water deficit. Results. In the association panel the level of genetic diversity was substantially lower for SNPs loci (0.32) than for SSR (0.87). GWAS detected 24 significant marker-trait associations along the various stages of drought-stress experiment and 13 candidate genes with a feasible role in drought response were identified. Gene expression analysis proved that three of these genes
Nieri R., Pfab F., Puppato S., Rendon D., Renkema J., Rodriguez-Saona C., Rogers M., Sassù F., Schöneberg T., Scott M.J., Seagraves M., Sial A., Van Timmeren S., Wallingford A., Wang X., Yeh D.A., Zalom F.G., Walton V.M. (2021).
Drosophila suzukii (Diptera: Drosophilidae): a decade of research towards a sustainable integrated pest management program.
Journal of Economic Entomology, 114 (5): 1950-1974.
Tonidandel L., Larcher R., Barbero A., Jelley R.E., Fedrizzi B. (2021). A single run liquid chromatographytandem mass spectrometry method for the analysis of varietal thiols and their precursors in wine. Journal of Chromatography A 1658: 462603.
Tosi S., Nieh J.C., Brandt A., Colli M., Fourrier J., Giffard H., Hernández-López J., Malagnini V., Williams G.R., Simon-Delso N. (2021). Long-term field-realistic exposure to a next-generation pesticide, flupyradifurone, impairs honey bee behaviour and survival.
Communications Biology, 4 (1): 805.
Trenti M., Lorenzi S., Bianchedi P.L., Grossi D., Failla O., Grando M.S., Emanuelli F. (2021). Candidate genes and SNPs associated with stomatal conductance under drought stress in Vitis.
BMC Plant Biology, 21 (1): 7.
(VIT_13s0019g03040, VIT_17s0000g08960, VIT_18s0001g15390) were actually induced by drought stress. Genetic variation of VIT_17s0000g08960 coding for a raffinose synthase was further investigated by resequencing the gene of 85 individuals since a SNP located in the region (chr17_10,497,222_C_T) was significantly associated with stomatal conductance. Conclusions. Our results represent a step forward towards the dissection of genetic basis that modulate the response to water deprivation in grape rootstocks. The knowledge derived from this study may be useful to exploit genotypic and phenotypic diversity in practical applications and to assist further investigations.
Sirri R., Verin R., Perolo A., Lunelli F., Faccenda F., Fioravanti M.L., Quaglio F. (2021). Metastatic osteoblastic osteosarcoma of the jaw in a marble trout (Salmo marmoratus). Journal of Fish Diseases, 44 (4): 483-485.
Somenzi E., Franceschi N., Barbato M., Colli L., Partel E., Komjanc M., Achilli A., Hauffe H., Ajmone Marsan P. (2021). Genetic diversity and runs of homozygosity in Rendena cattle. Italian Journal of Animal Science, 20 (suppl. 1): 116-117.
Anfora G., Angeli G., Fiaschetti M., Tessari L., Ioriatti C. (2021). Scopazzi del melo, situazione in Trentino. L’Informatore Agrario, (8): 45-49.
Angeli D., Gottardello A., Giuliani G., Turrini L. (2021). Ciliegie, la qualità passa da una raccolta tempestiva. Terra è vita, (8): 52-54.
Angeli D., Gualandri V., Longa C.M., Zaffoni M. (2021). Patina bianca, nuova emergenza in melicoltura. L’Informatore Agrario, (8): 51-53.
Angeli G., Sofia M., Chiesa S.G. (2021). Prevenzione fitosanitaria con la refrigerazione delle mele. L’Informatore Agrario, (1): 50-53.
Battiston, R., Maurici A., Fontana P. (2021). New data on the distribution and ecology of the earwigs (Insecta, Dermaptera) of Kyrgyzstan. Memorie della Società Entomologica Italiana, 97 (1-2 (2020)): 303-310.
Bellistri E., Iussig G. (2021). Monitoraggio dei prati trentini: analisi dell’andamento fenologico nel 2021. L’Allevatore trentino, 42 (6): 32-35.
Bona D., Silvestri S. (2021). Compost, Letami, Digestati, Biochar ed Hydrochar. Terra Trentina, 66 (1): 58-59.
Bona D., Silvestri S., Bertoldi D., Tambone F., Mazzini S. (2021). Il progetto HYDRORG. Terra Trentina, 66 (3): 62-63.
Bondesan D. (2021). Trattamenti a punto fisso per la difesa sostenibile. Terra è vita, (8): 40-41.
Bondesan D., Casera C., Rizzi C., Kelderer M. (2021). Efficacia anti-deriva dell’impianto sovrachioma. Terra è vita, (8): 42-44.
Bondesan D., Corradini S., Feltrin A. (2021). Sistemi evaporativi per le acque di lavaggio delle irroratrici. L’Informatore Agrario, (22): 45-48.
Bottura M., Groff L., Gelmetti A., Malacarne M., Zottele F., Moser S., Roman Villegas T. (2021).
Gestire il vigneto al meglio in funzione del meteo. L’Informatore Agrario, (4): 37-40.
Bottura M., Roman Villegas T., Moser S., Stefanini M., Gretter L., Betalli V. (2021).
Viti resistenti in Trentino. Terra Trentina, 66 (2): 54-56.
Brentari L., De Blasi B., Boccagni L. (2021).
Dalla coca alla baby-banana: la rinascita dei produttori in Perù. Altreconomia (235): 52-55.
Canepel R., Dallafior V., Cristoforetti A. (2021).
Proposte di gestione sostenibile degli effluenti zootecnici per migliorare la qualità delle acque in Trentino. Pescare in Trentino, 1: 14-21.
Cotarella R., Chiasso P.P., Biasi N., Carlin S., Angeli A., Guzzon R., Groff L., Panichi A., Vrhovsek U., Cambrea M., Vallini V., Mattivi F. (2021).
Esperienze di utilizzo del MCRS per una vinificazione di qualità. L’Enologo, 3: 91-96.
Cristoforetti A. (2021).
Maturazione controllata del letame in Val di Ledro. Terra Trentina, 4, 2021. P. 59.
Fontana P. (2021).
Arriva uno sciame d’api in giardino: ecco come comportarsi. Vita in campagna, (4): 61-63.
Fontana P. (2021).
Il miracolo di San Galgano. De Rerum Natura, 28 (62): 24-25.
Fontana P. (2021).
La «danza delle api», un affascinante sistema di comunicazione. Vita in campagna, (6): 57-60.
Fontana P. (2021).
Le api di Virgilio, sommo poeta ed etologo ante litteram. Rendiconti. Classe di Scienze Matematiche e Naturali, 155: 1-30.
Fontana P. (2021). Pest Control e Insetti Pronubi: strategie sostenibili di “convivenza”. +PEST management, 1 (2): 10-11.
Fontana P., Bortolotti L. (2021). Bee conservation is not ‘child’s play’. Bees for Development Journal, (140): 3-6.
Fontana P., Malagnini V., La Mantia T., Lo Verde G. (2021).
The Embioptera from the Strait of the Sicily Islands: first records from Pantelleria and Lampedusa and new data from Lampione (Sicily, Italy). Naturalista Siciliano, 45 (1-2): 77-90.
Fontana P., Malagnini V., Zanotelli L. (2021). A testa bassa contro la Varroa. L’Apicoltore italiano, (5): 27-32.
Fontana P., Malagnini V., Zanotelli L. (2021). Apicoltura sostenibile significa in primo luogo allevare api locali. L’Apicoltore italiano, (2): 29-34.
Fontana P., Malagnini V., Zanotelli L. (2021).
Condividere e comunicare la sostenibilità. L’Apicoltore italiano, (8): 34-38.
Fontana P., Malagnini V., Zanotelli L. (2021). Il cambiamento climatico esige cambiamenti. L’Apicoltore italiano, (6): 34-39.
Fontana P., Malagnini V., Zanotelli L. (2021).
L’apicoltore e le “sue” api: moltiplicazione e selezione su scala aziendale. L’Apicoltore italiano, (4): 27-32.
Fontana P., Malagnini V., Zanotelli L. (2021).
L’apicoltore giardiniere: coltivare piante per le api. L’Apicoltore italiano, (3): 31-36.
Fontana P., Malagnini V., Zanotelli L. (2021). Materiali e soluzioni tecniche per un’apicoltura sostenibile. L’Apicoltore italiano, (9): 24-28.
Fontana P., Marangoni F., Kočárek P., Tirello P., Giovagnoli G., Colacurcio L. (2021).
Updated knowledge on Italian Dermaptera with the report of a new alien species: Forficula smyrnensis Audinet-Serville, 1838. Memorie della Società Entomologica Italiana, 97 (1-2 (2020)): 261-270.
Fontana P., Pedrazzoli F., Malagnini V., Ruzzier E., Marangoni F., Kočárek P. (2021).
Toward a revision of the genus Chelidura Latreille, 1825: designation of the Neotype for Chelidura aptera (Megerle in Charpentier, 1825) (Dermaptera: Forficulidae). Memorie della Società Entomologica Italiana, 97 (1-2 (2020)): 279-302.
Ganarin G. (2021).
Rete parziale, miglior soluzione per la qualità dei piccoli frutti. L’Informatore Agrario, (13): 71-74.
Graziosi P., Iannacci A., Valentini M., Fontana P., Vitali L. (2021).
Le sentinelle dei prati: dal BeeOdiversity Park di Montebello di Bertona un progetto per la salvaguardia degli apoidei. De Rerum Natura, 28 (62): 16-21.
Guzzon R. (2021).
I batteri acetici nel vino, un problema reale?. Millevigne, (4): 42-46.
Guzzon R. (2021).
Il biocontrollo in enologia. VVQ, (5): 68-73.
Guzzon R. (2021).
Il ciclo dell’azoto in enologia. VVQ, (7): 64-69.
Guzzon R. (2021).
La posizione del vigneto non cambia il microbiota. Vite & Vino, (5): 25-30.
Guzzon R. (2021).
La presa di spuma e l’adattamento dei lieviti. VVQ, (1): 56-62.
Guzzon R. (2021).
Lo stato dell’arte sulla fermentazione malolattica. Vite & Vino, (2): 50-55.
Guzzon R. (2021). Microrganismi e colore del vino, quale relazione?. Millevigne, (2): 36-38.
Guzzon R. (2021).
Quando i lieviti riducono l’alcol. VVQ, (3): 62-66.
Guzzon R. (2021).
Stabilità microbiologica dei vini e chitosani, lo stato dell’arte. Millevigne, (1): 32-35.
Guzzon R. (2021). Varietà del microbiota: conoscerla per vinificare al meglio. Vite & Vino, (4): 55-59.
Guzzon R., Nardin T., Larcher R. (2021). L’efficacia dei chitosani varia con le specie microbiche. Vite & Vino, (6): 27-31.
Lucin R., Gobber M., Zanzotti R. (2021). Curetage e mal dell’esca: buoni risultati ma serve metodo. Vite & Vino, (3): 36-44.
Mazzucchi M., Peterlini M., De Ros G. (2021). In Trentino produrre latte costa di più. Informatore Zootecnico, (19): 32-35.
Mian G., Comuzzo P., Iacumin L., Zanzotti R., Celotti E. (2021). Study to optimize the effectiveness of Copper treatments for a low impact viticulture. Infowine
Morelli R., Cersosimo Ippolito M. (2021). Il suolo come organismo vivente: indicatori di qualità biologica. Terra Trentina, 66 (2): 64-65.
Natolino A., Roman Villegas T., Nicolini G., Celotti E. (2021). Innovation in red winemaking process by ultrasound technology. Il Corriere Vinicolo, 94 (12 suppl. (Wine World Magazine)): 23-26.
Natolino A., Roman Villegas T., Nicolini G., Celotti E. (2021).
Innovazioni con la tecnologia degli ultrasuoni. Il Corriere Vinicolo, 94 (14): 15-19.
Franchi R., Giovanelli P. (2021).
Il controllo della piralide del mais. Terra Trentina, 66 (4): 29.
Partel E. (2021).
“Nuovi” approcci gestionali per la messa in asciutta della bovina da latte. L’Allevatore trentino, 42 (5): 12-14.
Partel E. (2021).
La prevenzione della mastite in alpeggio. L’Allevatore trentino, 42 (2): 12.
Roman Villegas T., Nardin T., Pace J.M., Cappello N., Larcher R., Nicolini G. (2021).
Peso del ceppo di lievito sulla presenza di molecole correlate all’invecchiamento atipico. L’Enologo, (1/2): 91-94.
Salvadori C., Tolotti G., Confalonieri M. (2021).
Danni da bostrico tipografo: una delle pesanti conseguenze della tempesta Vaia. Agricoltura Trentina, 40 (3): 14-15.
Scrinzi D., Bona D., Andreottola G., Silvestri S., Ferrentino R., Fiori L. (2021).
Dalla FORSU all’Hydrochar co-compost. Servizi a rete, 20 (1): 30-34.
Tami F., Tirello P., Fontana P. (2021).
Chorthippus (Glyptobothrus) pullus (Philippi, 1830) (Insecta Orthoptera): nuove segnalazioni in Friuli
Venezia Giulia e Veneto e distribuzione nell’arco alpino italiano. Gortania. Botanica Zoologia, 43: 53-66.
Torresani R., Branz A., Taddia A. (2021).
Varietà tolleranti alla ticchiolatura in Trentino. Frutta e Vite, 05: 24-26.
Zapponi L., Chiesa S., Bargna S., Borri G., Chini L., Delmarco T., Fellin L., Gallimbeni L., Marchesini A., Sofia M., Buzzetti F.M., Stancher G. (2021).
Prima segnalazione di Acrosternum heegeri Fieber, 1861 (Heteroptera: Pentatomidae) in Trentino. Annali del Museo Civico Di Rovereto. Sezione: Archeologia, Storia, Scienze Naturali, 37: 235-239.
Zottele F., González Santana Á. (2021).
“Faraway, so close!”: proof of concept of landscapital as applied to the terraced landscapes of the Canary Islands and Val di Cembra (Italian Alps). Vegueta, 21 (1): 319-342.
Angeli D., Turrini L., Zeni F., Roman Villegas T. (2021).
Effect of postharvest treatments on physiological disorders of `Galant´: a new scab resistant apple cultivar. In: CAMA 2021: XIII International controlled and modified atmosphere research conference, virtual, 16-18 August 2021.
Bondesan D., Clappa E., Rizzi C., Tonidandel L., Zottele F., Kuntz M., Wiedmer R., Knoll M. (2021). Case study on “Centralizing sprayer cleaning management”. In: Sprayer Cleaning Workshop, Oberbozen, Italy, 2-3 October 2019, Aspects of Applied Biology: 51-59.
Bottura M., Margoni M., Matte’ B., Mattedi F., Porro D., Pedo’ S., Roman Villegas T., Gelmetti A., Nicolini G. (2021).
Valutazione fenologica, produttiva e fitosanitaria di vitigni resistenti coltivati in Trentino. In: Peterlunger E., Sivilotti P., Falchi R. (a cura di) CONAVI 2020: 8° Convegno nazionale di viticoltura (CONAVI), Udine, 5-7 luglio 2021. Udine: Università degli Studi di Udine: 28.
Chieco C., Tadić S., Morrone L., Magli M., Pedo’ S., Battistel G.A., Zulini L., Rossi F., Eccel E. (2021). Perception of climate risks by the Italian winegrowers and wine makers and their level of adaptation to climate change. In: XXIII Convegno Nazionale di Agrometeorologia: Agricoltura 4.0 e cambiamento climatico: il ruolo dell’agrometeorologia, on line, 30 giugno – 2 luglio 2021: 72-76.
Altre pubblicazioni, inclusi i contributi a convegni pubblicati
Ciutti F., Cappelletti C. (2021).
Distribution of Corbicula clams (Veneroidea, Cyrenidae) in Lake Garda (Italy). In: XXV Congresso AIOL: Contributi innovativi dell’oceanologia e della limnologia alla conoscenza, al recupero e alla salvaguardia delle risorse acquatiche minacciate dai cambiamenti globali: Strumenti e approcci innovativi nelle scienze acquatiche in un mondo che cambia, online, 30 giugno-2 luglio 2021: 75.
Dalmaso G., Gualandri V., Baldessari M., Mori N., Mazzoni V., Ioriatti C. (2021). Possible implication of Orientus ishidae in apple proliferation epidemiology. Preliminary study in Trentino (Italy). In: INFitoplasmi 2021: VIII incontro nazionale sui fitoplasmi e malattie da fitoplasmi, Catania, 14-15 ottobre 2021: 31.
Dekker S., Nardin T., Mattana M., Fochi I., Van Leeuwen K., Fedrizzi B., Dell’Anna C. (2021). Chemical and biochemical formation of polysulfides in synthetic and real wines using UHPLC-HRMS. In: Macrowine 2021, virtual, June 23-30, 2021.
Delaiti S., Pedo’ S., Roman Villegas T., Nardin T., Zanzotti R. (2021). Rapporto tra strategie di fertilizzazione e invecchiamento atipico (ATA) di vini bianchi trentini. In: Peterlunger E., Sivilotti P., Falchi R. (a cura di) CONAVI 2020: 8° Convegno nazionale di viticoltura (CONAVI), Udine, 5-7 luglio 2021. Udine: Università degli Studi di Udine: 97.
Faccenda F., Povinelle M., Pereira G.V., Soares F., Mendes R., Dias J., Buck B., Johansen J., Conceição L.E.C. (2021).
Eco-efficient aquafeed formulations for rainbow trout effects on performance, waste and sensorial analysis. In: Aquaculture Europe 20, online, April 12-15, 2021: 195-196.
Faralli M., Bontempo L., Bianchedi P., Moser C., Bertamini M., Camin F., Stefanini M., Varotto C. (2021). Speed of stomatal responses to fluctuating environmental conditions explains the lack of association between heat stress sensitivity and iWUE in field grown grapevine. In: Peterlunger E., Sivilotti P., Falchi R. (a cura di) CONAVI 2020: 8° Convegno nazionale di viticoltura (CONAVI), Udine, 5-7 luglio 2021. Udine: Università degli Studi di Udine: 75.
Gallo A., Barbero A., Tonidandel L., Schneider R., Larcher R., Roman Villegas T. (2021). Management of varietal thiols in white and rosé wines using biotechnical tools. In: Macrowine 2021, online, June 23-30, 2021.
Gelmetti A., Ghidoni F., Cainelli C., Bottura M. (2021). Frequency of “flavescence dorée” detected in adults of Scaphoideus titanus collected in vineyards with different epidemic pressure of the disease. In: INFitoplasmi 2021: VIII incontro nazionale sui fitoplasmi e malattie da fitoplasmi, Catania, 14-15 ottobre 2021: 32.
Gelmetti A., Ghidoni F., Zapponi L., Mazzoni V., Bottura M. (2021). Three-year monitoring of potential insect vectors of “flavescence dorée” in Trentino vineyards through use of chromotropic traps. In: INFitoplasmi 2021: VIII incontro nazionale sui fitoplasmi e malattie da fitoplasmi, Catania, 14-15 ottobre 2021: 33.
Guzzon R., Malacarne M., Larcher R., Franciosi E., Toffanin A. (2021). Macerazione carbonica nel vino e biodiversità microbica, quale relazione?. In: Elia A., Conversa G. (a cura di) Biodiversità 2021: Agricoltura, ambiente e salute: XIII Convegno Nazionale sulla Biodiversità, Foggia, 7-9 settembre 2021. Foggia: Dipartimento di Scienze Agrarie, Alimenti, Risorse Naturali e Ingegneria (DAFNE) Università degli Studi di Foggia: 187.
Malossini U., Nicolini G., Moscon R., Roman Villegas T. (2021). Caratteristiche di 7 cloni italiani di Müller Thurgau. In: Peterlunger E., Sivilotti P., Falchi R. (a cura di) CONAVI 2020: 8° Convegno nazionale di viticoltura (CONAVI), Udine, 5-7 luglio 2021. Udine: Università degli Studi di Udine: 114.
Malossini U., Nicolini G., Moscon R., Roman Villegas T. (2021). Selezione clonale e sanitaria di Moscato giallo in Trentino. In: Peterlunger E., Sivilotti P., Falchi R. (a cura di) CONAVI 2020: 8° Convegno nazionale di viticoltura (CONAVI), Udine, 5-7 luglio 2021. Udine: Università degli Studi di Udine: 115.
Martin V., Olivera V., Farina L., Boido E., Dellacassa E., Schneider R., Mas A., Roman Villegas T., Morata A., Carrau F. (2021).
Application of Hanseniaspora vineae Hv205 during white and red grape vinification at diverse winery scales. In: ASEV 72. national conference: Science: a platform for progress, virtual, June 21-24, 2021: 32-33.
Mazzucchi M., Partel E., Iussig G. (2021).
A system to promote a traditional raw milk product. In: 1st Joint Meeting of EAAP Mountain Livestock Farming & FAO-CIHEAM Mountain Pastures “Mountains are agroecosystems for people”, Bled, Slovenia, June 7-9, 2021. Domžale: University of Ljubljana: 59.
Morelli R., Bertoldi D., Baldantoni D., Zanzotti R. (2021).
Qualità del carbonio organico del suolo: gestioni a confronto in vigneto. In: Peterlunger E., Sivoilotti P., Falchi R. (a cura di) 8° Convegno nazionale di viticoltura, (CONAVI), Udine, 5-7 luglio 2021. Udine: Università degli Studi di Udine: 91.
Morelli R., Coller E., Cersosimo Ippolito M.C., Zanoni S., Cappelletti C., Ciutti F., Longa C.M., Zanzotti R. (2021).
Biodiversità e composizione della comunità edafica di un meleto trentino in conversione. In: Elia A., Conversa G. (a cura di) Biodiversità 2021: Agricoltura, ambiente e salute: XIII Convegno Nazionale sulla Biodiversità, Foggia, 7-9 settembre 2021. Foggia: Dipartimento di Scienze Agrarie, Alimenti, Risorse Naturali e Ingegneria (DAFNE) Università degli Studi di Foggia: 244.
Nardin T., Roman Villegas T., Dekker S., Larcher R. (2021).
Impact of the pre-fermentative addition of enological adjuvants on the development of UTA in wines. In: Macrowine 2021, virtual, June 23-30, 2021.
Obertegger U., Andreis D., Piccolroaz S., Flaim G. (2021).
Dissolved oxygen in a wind-shielded mountain lake is determined by the interplay of ice cover and extreme events. In: XXV Congresso AIOL: Contributi innovativi dell’oceanologia e della limnologia alla conoscenza, al recupero e alla salvaguardia delle risorse acquatiche minacciate dai cambiamenti globali: Strumenti e approcci innovativi nelle scienze acquatiche in un mondo che cambia, online, 30 giugno-2 luglio 2021: 71.
Obertegger U., Andreis D., Piccolroaz S., Flaim G. (2021).
Extreme events and ice cover determine dissolved oxygen in a mountain lake. In: SEFS12: Symposium for European freshwater sciences, online, 25-30 July, 2021: 358.
Obertegger U., Andreis D., Piccolroaz S., Flaim G. (2021).
Extreme events and ice cover determine the shift from meromixis to dimixis in a mountain lake. In: SIL2021 35th Congress of the International Society of Limnology: biodiversity and ecosystem services for healthy rivers, lakes and humans, on line, August 22-27, 2021: 136.
Paolini M., Allari L., Tonidandel L., Perini M., Guardini K., Larcher R. (2021).
Distribution analysis of myo and scyllo-inositol in natural grape must. In: Macrowine 2021, online, June 23-30, 2021.
Partel E., Lora I., Scalet L., Cozzi G. (2021).
Animal welfare assessment in alpine dairy farms with different housing systems. In: 1st Joint Meeting of EAAP Mountain Livestock Farming & FAO-CIHEAM Mountain Pastures “Mountains are agroecosystems for people”, Bled, Slovenia, June 7-9, 2021. Domžale: University of Ljubljana: 60.
Perini M. (2021).
Application of Stable Isotope Ratio Analysis for the characterization of pharmaceuticals, cosmetics and supplements. In: XXIIIrd International Conference “New Cryogenic and Isotope Technologies for Energy and Environment” – EnergEn 2021, 26–29 October 2021, Băile Govora, Romania: 246-247.
Perini M., Camin F., Lanz S., Moser S., Roman Villegas T. (2021).
Insights into the stable isotope ratio variability of hybrid grape varieties. In: Macrowine 2021, virtual, June 23-30, 2021.
Pulcini D., Capoccioni F., Franceschini S., Martinoli M., Secci G., Perugini A., Faccenda F., Tibaldi E., Parisi G. (2021).
Muscle pigmentation in rainbow trout fed novel protein sources from microalgae and crustaceans: the image analysis approach. In: ASPA 2021: 24th Congress of the Animal Science and Production Association: animal science and society concerns, Padova, Italy, September 21-24.
Roman Villegas T., Bottura M., Malacarne M., Stefanini M., Moser S. (2021). Las nuevas variedades de vides resistentes a las enfermedades fúngicas. In: XV encuentro técnico Adaptación enológica al cambio climático, Madrid, 23 noviembre 2021. Pozuelo de Alarcón, Madrid: Fundación para la Cultura del Vino: 55-63.
Roman Villegas T., Cappello N., Gallo A., Paolini M., Nardin T., Moser S., Carrau F., Schneider R., Larcher R. (2021).
The use of Hanseniaspora vineae on the production of base sparkling wine. In: Macrowine 2021, online, June 23-30, 2021.
Roselli G., Anfora G., Cristofaro M., Suckling D.M., Mazzoni V., Vanoni V., Menegotti L., Fellin L., Rossi Stacconi M.V., Cemmi A., Sforza R., Grodowitz M., Ioriatti C. (2021). Tecnica dell’Insetto sterile: valutazione degli effetti dell’irraggiamento sulla fisiologia e longevità di Halyomorpha halys e Bagrada hilaris. In: XXVI Congresso Nazionale Italiano di Entomologia (CNIE), Torino, 7-11 giugno 2021: 249.
Schiavon S., Guzzon R., Roman Villegas T. (2021). Biodiversità microbica e caratteristiche organolettiche dei Formaggi di Malga trentini, ruolo delle popolazioni batteriche e del tempo di stagionatura. In: Elia A., Conversa G. (a cura di) Biodiversità 2021: Agricoltura, ambiente e salute: XIII Convegno Nazionale sulla Biodiversità, Foggia, 7-9 settembre 2021. Foggia: Dipartimento di Scienze Agrarie, Alimenti, Risorse Naturali e Ingegneria (DAFNE) Università degli Studi di Foggia: 179.
Solovyev P., Perini M., Franceschi P., Bontempo L., Camin F. (2021).
NMR profiling of grape musts from some Italian regions. In: Macrowine 2021, virtual, June 23-30, 2021.
Somenzi E., Franceschi N., Barbato M., Colli N., Partel E., Komjanc M., Achilli A., Hauffe H.C., Ajmone Marsan P. (2021).
Genetic diversity and runs of homozygosity in Rendena cattle. In: 38th International Conference on Animal Genetics, virtual, July 25-30, 2021: 102.
Turrini L., Paolini M., Zeni F., Tonidandel L., Angeli D., Larcher R., Roman Villegas T. (2021). Evaluation of an optimized enzymatic biosensor for ethanol used in apple storage management with low oxygen stress. In: CAMA 2021: XIII International controlled and modified atmosphere research conference, virtual, 16-18 August 2021.
Zanoni S., Morelli R., Maines R., Zanzotti R. (2021).
Conversion of an apple orchard: yield and quality. In: II Convegno AISSA #under 40, Sassari, 1-2 luglio 2021: 180-181.
Zanzotti R., Morelli R., Bertoldi D., Bertola N., Bertola N., Maines R., Cristoforetti A., Prodorutti D., Cersosimo Ippolito M.C. (2021).
Progetto CHAOS: approcci multidisciplinari in viticoltura per sfide globali. In: Peterlunger E., Sivilotti P., Falchi R. (a cura di) CONAVI 2020: 8° Convegno nazionale di viticoltura (CONAVI), Udine, 5-7 luglio 2021. Udine: Università degli Studi di Udine: 92.
Zanzotti R., Roman Villegas T., Paolini M., Coller E., Cappello N., Moser S., Malacarne M., Larcher R. (2021). Influence of the agronomic management on the aroma of Riesling wines. In: Macrowine 2021, online, June 23-30, 2021.
Zottele F., Gonzalez Santana A. (2021). “Faraway, So Close!” The landscapital proof-of-concept applied to the terraced landscapes of the Canary Islands and of the Alps. In: ITLA 2019: IV world congress terraced landscapes: re-enchanting terraces, Las palmas, Gran canaria, 13-22 March 2019: 204-211
Calliari V., Porro D., Stefanini M. (2021).
Comportamento enológico de diferentes variedades viníferas em regiões de altitude de Santa Catarina. In: Potencial de variedades de uvas viníferas nas regiões de altitude de Santa Catarina (editor(s) Palladini L.A., Fontanella Brighenti A., Kulkamp de Souza A.L., da Silva A.L.). Florianópolis: Empresa de Pesquisa Agropecuária e Extensão Rural de Santa Catarina: 174-186.
Chen C., Fang Y., Fontana P., Lloyd D.J., Martinez L., Mukomana D., Roberts J.M.K., Schouten C.N. (2021).
Beekeeping models. In: Good beekeeping practices for sustainable apiculture (editor(s) FAO, Apimondia, CAAS, IZSLT). Roma: FAO, IZSLT, Apimondia and CAAS. (FAO Animal Production and Health Guidelines): 19-38.
Fontana P. (2021). Se le api smettono di volare. In: Il libro dell’anno 2021. Roma: Treccani: 416-419.
Papitto G., Cindolo C., Calvo E., Minerbi S., Confalonieri M., Salvadori C., Gottardini E., La Porta N., Motta R., Meloni F. (2021).
IT02-T Foreste delle Alpi. In: La Rete Italiana per la Ricerca Ecologica di Lungo Termine: lo studio della biodiversità e dei cambiamenti (editor(s) Capotondi L., Ravaioli M., Acosta A., Chiarini F., Lami A., Stanisci A., Tarozzi L., Mazzocchi M.G.). Roma: CNR: 101-141.
Porro D., Fontanella Brighenti A. (2021). Nutrição e viticultura. In: A Cultura da Videira: Vitivinicultura de Altitude (editor(s) Rufato L., Marcon Filho J.L., Fontanella Brighenti A., Bogo A., Kretzschmar A.A.). Florianópolis: UDESC: 207-235.
Porro D., Stefanini M., Voltolini J.A. (2021). Descrição das 36 variedades viníferas avaliadas em regiões de altitude de Santa Catarina - Projeto Trento, SC. In: Potencial de variedades de uvas viníferas nas regiões de altitude de Santa Catarina (editor(s) Palladini, L.A., Fontanella Brighenti A., Kulkamp de Souza A.L., da Silva A.L.). Florianópolis: Empresa de Pesquisa Agropecuária e Extensão Rural de Santa Catarina: 75-148.
Porro D., Stefanini M., Voltolini J.A., Vieira H.J., Brighenti E., Souza E.L., Caliari V., Kulkamp de Souza A.L., Fontanella Brighenti A., Palladini L.A., da Silva A.L. (2021).
Comportamento vitícola das 36 variedades viníferas do projeto “Tecnologias para o desenvolvimento da vitivinicultura Catarinense” nas regiões de altitude de Santa Catarina. In: Potencial de variedades de uvas viníferas nas regiões de altitude de Santa Catarina (editor(s) Palladini L.A., Fontanella Brighenti A., Kulkamp de Souza A.L., da Silva A.L.). Florianópolis: Empresa de Pesquisa Agropecuária e Extensão Rural de Santa Catarina: 149-159.
Salmaso N., Bresciani M., Buzzi F., Ciampittiello M., Leoni B., Piscia R., Rogora M., Austoni M., Beltrami M., Bertoni R., Boggero A., Boscaini A., Brivio P.A., Callieri C., Cerutti I., Cappelletti C., Carrara P., Cerasino L., Ciutti F., Corno G., Crippa E., Di Cesare A., Dresti C., Eckert E., Foglini C., Fontaneto D., Galafassi S., Giacomotti P., Giardino C., Guilizzoni P., Iaia M., Lami A., Lella S., Manca D., Manca M., Marchetto A., Mosello R., Musanti M., Nava V., Oggioni A., Orrù A., Patelli M., Riccardi N., Saidi H., Sala P., Soler V., Tartari G.A., Tolotti M., Volta P., Zaupa S. (2021).
IT08-A Laghi sudalpini. In: La Rete Italiana per la Ricerca Ecologica di Lungo Termine - Lo studio della biodiversità e dei cambiamenti (editor(s) Capotondi L., Ravaioli M., Acosta A., Chiarini F., Lami A., Stanisci A., Tarozzi L., Mazzocchi M.G.). Roma: CNR: 229-296.
Simmons G.S., Varela L., Daugherty M., Cooper M., Lance D., Mastro V., Carde R.T., Lucchi A., Ioriatti C., Bagnoli B., Steinhauer R., Broadway R., Stone Smith B., Hoffman K., Clark G., Whitmer D., Johnson R. (2021).
Area-wide eradication of the invasive European grapevine moth Lobesia botrana in California, USA.
In: Area-wide integrated pest management: development and field application (editor(s) Hendrichs J., Pereira R., Vreysen M.J.B.). Boca Raton, FL: CRC press: 581-596.
Pantezzi T. (a cura di)
24a Giornata tecnica La frutticoltura nelle valli del Noce: San Michele all’Adige, 19 febbraio 2021. San Michele all’Adige (TN): Fondazione Edmund Mach.
• Barchetti D., de Concini M., Berti M., Panizza C., Zanoni S., Zapponi L. (2021). Cimice asiatica: evoluzione della popolazione nelle Valli del Noce, strategie di difesa integrata e di lotta biologica.
• Iori l., Chini M., Branz A., Springhetti M., Zaffoni M., Flaim D. (2021). Scopazzi del melo: andamento della malattia e indicazioni per il contenimento.
• Torresani T., Springhetti M., Bertagnolli A. (2021). Nuove varietà di melo: indicazioni agronomiche e miglioramento delle tecniche di produzione.
• Iachemet D., Pasqualini J., Guerra A., Defant C., Villa I., Dallabetta N. (2021). Portinnesti del melo: nuove selezioni, caratteristiche e primi risultati sperimentali.
Ioriatti C., Baldessari M. (a cura di) Giornata tecnica Emergenza colpo di fuoco: Aspetti tecnici, sperimentali e normativi: San Michele all’Adige, 2 marzo 2021. San Michele all’Adige (TN): Fondazione Edmund Mach.
• Delaiti L., Zaffoni M., Andreatti A. (2021). Colpo di fuoco in Trentino: analisi della stagione 2020 e prospettive 2021.
• Gualandri V. , Cainelli C., Angeli G. (2021). La diagnostica di laboratorio: azione fondamentale di sorveglianza della malattia.
Pantezzi T. (a cura di)
7a Giornata tecnica Piccoli frutti: San Michele all’Adige, 25 marzo 2021. San Michele all’Adige (TN): Fondazione Edmund Mach.
• Ganarin G. (2021). Gestione sostenibile della fertirrigazione della fragola in fuorisuolo.
• Tonina L., Zanettin G., Miorelli P., Puppato S., Grassi A. (2021). Antonomo della fragola: osservazioni su biologia, ecologia e controllo.
• Rossi Stacconi M.V., Anfora G., Grassi A., Ioriatti C. (2021). Progetto di lotta biologica per il rilascio del parassitoide Ganaspis brasiliensis.
• Puppato S., Grassi A. (2021).Risultati del monitoraggio di Drosophila suzukii e del parassitoide asiatico Leptopilina japonica sul territorio provinciale nel 2020.
Prodorutti D., Zanzotti R. (a cura di)
Presentazione prove sperimentali in viticoltura biologica 2021: San Michele all’Adige, 5 agosto 2021. San Michele all’Adige (TN): Fondazione Edmund Mach.
• Chiusole M., Lucin R., Gobber M., Zanzotti R. (2021). Controlli e situazione fitosanitaria 2021 nelle aziende biologiche in Trentino.
• Gobber M., Lucin R. (2021). Gestione dei giallumi della vite nelle aziende a conduzione biologica in Trentino.
• Maines R., Forno F., Zanzotti R. (2021). Gestione della peronospora: risultati della sperimentazione 2021.
Bottura M. (a cura di) 14a giornata tecnica della vite e del vino: San Michele all’Adige, 14 dicembre 2021. San Michele all’Adige (TN): Fondazione Edmund Mach.
• Gelmetti A. (2021). I giallumi della vite. Situazione attuale e prospettive di contenimento dei vettori
• Corradini S., Bottura M. (2021). Andamento stagionale e fitosanitario 2021.
• Groff L., Malacarne M. (2021). La vendemmia 2021: valutazioni e prospettive.
• Mattedi F., Prodorutti D. (2021). Il Black rot: analisi della situazione in Trentino.
• Fontana P., Malagnini V. (2021). Le api e il vigneto: dalla contrapposizione alla sinergia.
1 - 15/02/2021
2 - 16/03/2021
3 - 12/04/2021
4 - 29/04/2021
5 - 06/10/2021
FRUTTICOLTURA*
Scopazzi del melo 1.004 2.444
Difesa attiva dalle gelate primaverili melo e ciliegio 2021 963 2.376
Disciplinare per la Produzione Integrata. Melo, susino e actinidia 2021 963 2.416
Il modulo aggiuntivo GRASP nella certificazione GLOBALG.A.P. 990 2.533
Deperimento e moria del melo 959 2.493
Notiziario tecnico del Centro Trasferimento Tecnologico della Fondazione Edmund Mach
Autorizzazione Tribunale di Trento n. 1 del 02.03.2018
1 - 26/04/2021 PICCOLI FRUTTI
1 - 20/04/2021
2 - 24/06/2021
1 - 22/06/2021
OLIVICOLTURA
OLIVICOLTURA
Disciplinare di Produzione Integrata. Fragola, piccoli frutti e ciliegio 2021 257 930
Gestione della mosca olearia (Bactrocera oleae) 242 1.538
Difesa estiva e autunnale dell’olivo 2021 243 1.550
APICOLTURA
Lotta alla Varroasi in Trentino. Proposte di intervento 2021 291 1.217
* A partire dal 2021, la maggior parte delle informazioni legate alla gestione agronomica e fitosanitaria del melo sono riportate nell’Approfondimento monografico Frutticoltura integrataGuida pratica alla coltivazione del melo.
8 - Gennaio 2021 / L. Zapponi, V. Mazzoni, M. V. Rossi Stacconi, G. Anfora Pagine 12
Quando si parla di specie di insetti altamente invasivi è fondamentale tenere presente che il motivo principale della loro proliferazione è l’assenza di limitatori naturali specializzati, sia predatori che parassitoidi, nelle nuove zone di invasione. In campo agrario, i classici mezzi di controllo (es. insetticidi, cattura massale) o di protezione delle colture (es. reti) possono abbassare temporaneamente la presenza dei fitofagi invasivi in campo, ma sicuramente non sono in grado di risanare lo squilibrio ecologico creatosi a seguito del loro insediamento. L’unica possibilità per limitarne la dannosità è quella ristabilire il naturale equilibrio mediante il rilascio controllato di antagonisti specifici dei quali si conosce l’efficace azione di controllo nelle zone di origine. Nel corso del 2020, si sono verificate le condizioni per l’avvio di un programma di lotta biologica verso la cimice asiatica Halyomorpha halys che ha previsto il rilascio di un antagonista specifico, l’imenottero Trissolcus japonicus in maniera coordinata su un’ambia superfice territoriale comprendente tutte le regioni dell’Italia settentrionale. Per la provincia di Trento, l’allevamento, moltiplicazione e rilascio dell’antagonista è stato curato dalla Fondazione E. Mach, che ha operato in stretto coordinamento con le Università e i Centri di ricerca delle altre regioni del nord Italia. Con questa pubblicazione, che prende spunto dall’esperienza fatta in questo primo anno di attività, ci si prefigge di trasmettere ad operatori, tecnici e agricoltori alcuni concetti di base sui quali si fonda la lotta biologica. Vengono descritte le diverse modalità di intervento che rientrano nella generale definizione di lotta biologica, evidenziandone i pregi e i limiti, illustrandone le caratteristiche ecologiche dei contesti in cui si deve operare per poter avere successo, non sottacendo i possibili errori che potrebbero essere inconsapevolmente compiuti da personale inesperto.

Approfondimenti monografici del Centro Trasferimento Tecnologico della Fondazione Edmund Mach

Guida pratica alla coltivazione biologica del meloQuarta edizione (2021)
9 - Marzo 2021 / D. Barchetti, S. Bott, A. Branz, A. Cristoforetti, A. Dorigoni, D. Flaim, M. Gobber, V. Mazzoni, E. Mescalchin, M. Morten, F. Pellegrini, M. Soini, M. Springhetti, F. Toniolli, R. Torresani, S. Zanoni, R. Zanzotti Pagine 64
La quarta edizione della guida, ulteriormente riveduta ed integrata di alcuni contenuti, come la sezione sugli scoltidi del melo, tratta a argomenti sia di carattere agronomico che legati alla difesa della coltura. Il filo conduttore è l’approccio olistico alla coltivazione del melo, dando ampio spazio alla gestione del suolo e alle tecniche per il mantenimento della fertilità del terreno. In particolare, nella coltivazione biologica si evidenzia come l’equilibrio vegeto-produttivo risulti fondamentale per affrontare con maggior successo la gestione della difesa da parassiti e malattie. Questa guida fornisce indicazioni di carattere pratico, comunque frutto di conoscenze scientifiche, utili per gli agricoltori che hanno di recente intrapreso la coltivazione biologica, ma che potranno essere adottate anche da chi coltiva in modo integrato.

10 - Aprile 2021 / N. Andreatti, D. Barchetti, A. Bertagnolli, M. Berti, D. Bondesan, A. Branz, M. Chini, A. Cristoforetti, M. de Concini, L. Delaiti, D. Flaim, D. Gabardi, D. Iachemet, L. Iori, F. Micheli, M. Morten, C. Panizza, F. Pellegrini, M. Pezzè, M. Prantil, M. Soini, M. Springhetti, F. Toniolli, R. Torresani, M. Zaffoni Pagine 144
La nuova “Guida pratica alla coltivazione del melo” raccoglie le informazioni essenziali per una conduzione ottimale dei frutteti secondo la produzione integrata che sono frutto dell’esperienza sia dei tecnici consulenti che degli sperimentatori della FEM. Con questo lavoro si è voluto concentrare in un unico manuale le indicazioni che periodicamente vengono fornite ai produttori tramite i vari canali informativi, con l’auspicio che esso diventi un punto di riferimento durante tutta l’annata agraria. Nella Guida sono illustrate le indicazioni per controllare le principali avversità e le operazioni agronomiche utili per raggiungere la migliore produttività e qualità. Ampio spazio è stato dedicato ai consigli per i monitoraggi da eseguire in campo da parte del frutticoltore, fondamentali per rispondere alle esigenze di sostenibilità delle produzioni. Sono riportati quindi sia gli strumenti ed i metodi per eseguire i controlli, ma anche i servizi offerti dalla FEM, nell’ottica di responsabilizzare sempre di più gli stessi produttori nella gestione dei propri frutteti.
11 - Maggio 2021 / S. Puppato, A. Grassi Pagine 16
Nell’ottica di individuare idonee strategie per ristabilire e conservare gli equilibri ecologici fra specie dannose e organismi utili, FEM ha messo a punto uno strumento sostenibile per favorire la diffusione e l’incremento di nemici naturali di Drosophila suzukii ossia dei piccoli imenotteri in grado di parassitizzare diversi stadi di sviluppo del moscerino tanto dannoso ai fruttiferi. Si tratta del Drosorium che, riprendendo il concetto di augmentorium, è una struttura di facile realizzazione la cui efficacia è stata testata dagli sperimentatori FEM e che permette di confinare al suo interno frutta infestata da D. suzukii, svolgendo così una duplice funzione: sanificare l’area agricola da nuove fonti di inoculo di questo insetto ed al contempo incrementare le popolazioni di parassitoidi indigeni proprio per favorire il controllo biologico della specie invasiva. In questo Approfondimento monografico sono riportate le indicazioni su come costruire in autonomia e impiegare il Drosorium. Sulla base delle esperienze degli sperimentatori FEM e dei risultati ottenuti si ritiene che un generalizzato impiego di questo strumento, unitamente all’adozione di programmi di difesa selettivi per gli organismi utili, possano dare un significativo contributo al controllo biologico di D. suzukii.

12 - Luglio 2021 / G. Angeli, G. Borri, S. G. Chiesa, L. Chini, L. Gallimbeni, A. Marchesini, M. Sofia, L. Fellin, V. Mazzoni, R. Mottes, L. Zapponi Pagine 72
Il gruppo di lavoro sulla cimice asiatica ha realizzato nell’ambito del progetto di lotta biologica SWAT questa guida per il riconoscimento di alcune specie di cimici che colonizzano gli ambienti agrari e forestali, parchi, orti e giardini del Nord Italia e rivolta ad agricoltori, tecnici, studenti e naturalisti. Molte specie di cimice, infatti, colonizzano le piante di interesse agrario e risulta importante poter distinguere quelle che determinano un danno alle colture da altre che invece sono predatrici di altri insetti, svolgendo quindi un utile ruolo di controllo biologico. La guida è costituita da 25 schede e oltre 200 fotografie, che descrivono i caratteri utili al riconoscimento di 21 specie e 4 generi di cimici. Si tratta di una guida pensata per la consultazione in campo le cui schede sono raggruppate in quattro categorie (“cimici marmorizzate”, “cimici verdi”, “altri pentatomidi” e “non pentatomidi”). La guida si conclude con un paragrafo sull’interpretazione delle ovature di cimice, che possono essere soggette al controllo biologico, consentendo di riconoscere la presenza di parassitizzazione o di predazione delle uova.

Tecnica sostenibile per il controllo biologico conservativo di Drosophila suzukii
Guida al riconoscimento delle specie di interesse agrario nel Nord Italia
Tutela delle sottospecie autoctone di Apis mellifera Linnaeus, 1758
Paolo Fontana e Livia Zanotelli (a cura di), Pagine 206, Monografia
ISBN 978-88-7843-055-6
Il volume raccoglie i contributi di alcuni tra i più affermati ricercatori in campo apidologico ed esperti del settore sulla tutela genetica dell’ape da miele. Questo tema è stato posto all’attenzione del mondo apistico nel 2018 con la “Carta di San Michele all’Adige”, documento collettivo con lo scopo di promuovere la salvaguardia di questi pronubi.
La tutela della biodiversità delle sottospecie autoctone di Apis mellifera è infatti strategica per la stessa apicoltura, e di riflesso per l’agricoltura, oltre che essere un impegno eticamente condivisibile nell’ottica del rispetto e della salvaguardia della biodiversità nel suo insieme. Questo è quanto la “Carta di San Michele all’Adige” ha voluto presentare, portando all’attenzione generale un tema che solo negli ultimi anni è affiorato come una emergenza a livello europeo e mondiale e cioè la tutela genetica dell’ape da miele (Apis mellifera).

AA. VV., Pagine 204, Rapporto di attività ISSN 20-37-7541
La dodicesima edizione del Rapporto del Centro Trasferimento Tecnologico della Fondazione E. Mach, composto da 204 pagine, riporta 50 relazioni tecnico-scientifiche riguardanti le principali attività di tecnologi, ricercatori e tecnici svolte nel 2020. Il Rapporto è corredato dalla sezione ’”Attività in sintesi” che illustra i dati più significativi relativi alle attività di servizio, analisi e sperimentazioni, nonchè l’elenco delle pubblicazioni scientifiche, tecniche e divulgative, gli eventi organizzati e dati relativi al personale del Centro.

14 gennaio Annata olivicola nelle regioni produttive Nord-Est italiano e Slovenia
19 febbraio La frutticoltura delle Valli del Noce, 24a giornata tecnica
Diretta streaming
AIPO, Associazione Interregionale Produttori Olivicoli ERSA Agenzia Regionale per lo Sviluppo Rurale del Friuli Venezia Giulia
Istituto Agrario e Forestale di Nova Gorica
Diretta streaming Melinda, APOT 5 marzo Progetto Vevir: meeting di chiusura
Diretta streaming FEM-CRI, CIVIT 11 marzo Emergenza colpo di fuoco: aspetti tecnici, sperimentali e normativi
Diretta streaming 25 marzo 7° giornata tecnica piccoli frutti Diretta streaming 8 giugno Incontro tecnico: aspetti tecnologici della trasformazione Ravina 5 agosto Prove sperimentali in frutticoltura e viticoltura biologica Diretta streaming Centro di Sperimentazione Laimburg 26 agosto Incontro prevendemmiale 2021
San Michele all’Adige e diretta streaming Assoenologi Sezione Trentino
2 settembre Incontro tecnico per tecnici della frigoconservazione Taio APOT 2 settembre Profili aromatici e composti azotati nei liquori d’erbe: seminario con Distillatori Trentini FEM Istituto Tutela Grappa Del Trentino 26 novembre Biochar e Idrochar per la salvaguardia della fertilità dei suoli Webinar
14 dicembre 14a Giornata tecnica della vite e del vino
San Michele all’Adige e diretta streaming
Università degli studi di Milano, Fondazione per la valorizzazione della ricerca trentina (VRT)
Rilascio autorizzazione per utilizzatori professionali (20 ore) 10 353 Formazione a distanza e videoconferenza
Rilascio autorizzazione per utilizzatori professionali –usi extra-agricoli (20 ore) 3 80 Formazione a distanza e videoconferenza
Rinnovo autorizzazione per utilizzatori professionali (12 ore) / 1.455 Formazione a distanza
Rinnovo autorizzazione per utilizzatori professionali (da 1 a 11 ore come completamento del percorso formativo a crediti) / 1.340 Formazione a distanza
Rilascio autorizzazione per la vendita dei prodotti fitosanitari (25 ore) 1 28 Formazione a distanza e videoconferenza
Rinnovo autorizzazione per la vendita dei prodotti fitosanitari (12 ore) / 72 Formazione a distanza
Rilascio autorizzazione per l’attività di consulente (25 ore) 2 61 Formazione a distanza e videoconferenza
Rinnovo autorizzazione per l’attività di consulente (12 ore) 2 56 Formazione a distanza e videoconferenza
Centro Agricoltura, Alimenti, Ambiente - C3A (Università degli Studi di Trento e Fondazione Edmund Mach). Insegnamenti relativi al secondo semestre aa 2020/2021 e al primo semestre aa 2021/2022
Insegnamento
Ore didattica Docente Ore supporto alla didattica Docente
Laboratorio qualità prodotti vitivinicoli Mod. I Teoria 40 Roberto Larcher
Laboratorio qualità prodotti vitivinicoli Mod. II Esercitazioni 80 Mario Malacarne 40 Marco Colapietro
Tecnica enologica speciale Mod. Tecnologia dei distillati di origine viticola 30 Sergio Moser
Tecnica enologica speciale Mod. Vini spumanti e vini speciali 30 Sergio Moser
Chimica e Microbiologia enologica Mod. Microbiologia enologica 80 Raffaele Guzzon 30 Silvia Schiavon
Enologia II 60 Tomas Roman 50 Paolini Mauro
Viticoltura biologica Mod. Aspetti agronomici della viticoltura biologica 30 Roberto Zanzotti
Viticoltura 1 Mod. Morfologia e fisiologia della vite con esercitazioni 30 Franca Ghidoni
Enologia Internazionale e degustazione vini Mod. Viti-enologia internazionale (territorio e vini) 30 Tomas Roman
Meccanizzazione viticola e viticoltura di precisione 10 Stefano Pedò
Viticoltura 2 Tecnica viticola ed esercitazioni 30 Roberto Zanzotti
TOTALE 300 140
Insegnamento
Ore didattica
Docente
Enologia 140 Sergio Moser Enologia - esercitazioni 63
Luciano Groff
Legislazione vitivinicola 33 Giorgio De Ros
Insegnamento
Ore didattica
Docente
Tecnico superiore della produzione, trasformazione e valorizzazione della filiera Agri-food (comparto bevande)
Unità formativa Qualità delle materie prime
3,5 3,5 21
Lorenzo Turrini Fabio Zeni Mario Malacarne
Unità formativa Tecnica della distillazione 28 Sergio Moser
Unità formativa Microbiologia 28 Raffaele Guzzon
Unità formativa Chimica degli alimenti 17,5 17,5
Roberto Larcher Tiziana Nardin
Unità formativa Qualità delle materie prime
5 11 11
Tecnico superiore del verde
Unità formativa Agronomia e normative 4
Unità formativa Agronomia, tecniche di coltivazione delle piante e meccanizzazione 28
Dario Angeli Lorenzo Turrini Fabio Zeni
Andrea Cristoforetti
Luca Brentari
Luigi Bonotto
Struttura fenolica dei vini rossi: effetto di tecnologie ancestrali ed innovative
Giada Boscaini Effetto delle tecniche di gestione della chioma sulla composizione dei mosti
Edoardo Ferrari
Giacomo
Valorizzazione di vini spumanti emiliani mediante l'impiego di differenti protocolli di gestione della presa di spuma
Esperienze di gestione della sosta a freddo dei mosti sulla feccia
La stabilità proteica dei vini: valutazione dell’utilizzo di proteasi sul mosto in condizioni enologiche
Corso di laurea in viticoltura ed enologia, Università degli Studi di Udine
Corso di laurea in viticoltura ed enologia, Centro Agricoltura Alimenti Ambiente, Università degli Studi di Trento – Fondazione Edmund Mach
Corso di laurea in viticoltura ed enologia, Centro Agricoltura Alimenti Ambiente, Università degli Studi di Trento – Fondazione Edmund Mach
Corso di laurea in viticoltura ed enologia, Centro Agricoltura Alimenti Ambiente, Università degli Studi di Trento – Fondazione Edmund Mach
Corso di laurea in viticoltura ed enologia, Centro Agricoltura Alimenti Ambiente, Università degli Studi di Trento – Fondazione Edmund Mach
Relatore/CorrelatoreSupervisore/Co-supervisore FEM-CTT
Tomas Roman
Matteo
Effetto del lievito nello sviluppo del difetto di UTA
Effetto delle tecniche di gestione della chioma sugli equilibri vegeto-produttivi, la ripartizione della biomassa e la produttività
La produzione del Gambellara classico vin santo doc: tra aspetti storici e innovativi
Caratterizzazione di portinnesti di vite in relazione a tolleranza allo stress idrico, calcare attivo e loro interazione
Approfondimenti tecnologici circa la distillazione di vinaccia proveniente da varietà aromatiche
Effetto delle tecniche di gestione della chioma (cimatura, accapannatura, defogliazione e rimozione dei germogli secondari) sul microclima delle foglie e dei grappoli e l’efficienza fotosintetica
Corso di laurea in viticoltura ed enologia, Centro Agricoltura Alimenti Ambiente, Università degli Studi di Trento – Fondazione Edmund Mach
Corso di laurea in viticoltura ed enologia, Centro Agricoltura Alimenti Ambiente, Università degli Studi di Trento – Fondazione Edmund Mach
Corso di laurea in viticoltura ed enologia, Centro Agricoltura Alimenti Ambiente, Università degli Studi di Trento – Fondazione Edmund Mach
Corso di laurea in viticoltura ed enologia, Centro Agricoltura Alimenti Ambiente, Università degli Studi di Trento – Fondazione Edmund Mach
Corso di laurea in viticoltura ed enologia, Centro Agricoltura Alimenti Ambiente, Università degli Studi di Trento – Fondazione Edmund Mach
Corso di laurea in viticoltura ed enologia, Centro Agricoltura Alimenti Ambiente, Università degli Studi di Trento – Fondazione Edmund Mach
Tomas Roman, Silvia Schiavon, Mario Malacarne, Sergio Moser
Nicola Cappello
Lucia Scalet
Modulazione degli aromi secondari nella produzione di vini per base spumante
Valutazione e gestione del benessere delle vacche da latte nella vallata del Primiero
Effetti di due diete a base proteica su colonie di api (Apis mellifera L.) infestate da Varroa (Varroa destructor Andreson & Trueman)
Corso di laurea in scienze e tecnologie alimentari, Università degli Studi di Bologna
Corso di laurea in scienze e tecnologie alimentari, Università degli Studi di Padova
Laurea magistrale in scienze e Tecnologie Agrarie, Università degli studi di Udine
Premio speciale “SIMEI-UIV” a Enoforum Web Conference (18-20 maggio 2021) organizzato da Vinidea per il lavoro “Innovations on red winemaking process by ultrasound technology” (Tomas Roman e Giorgio Nicolini)
Accademia dei Georgofili - www.georgofili.it
Accademia Italiana della Vite e del Vino - www.aivv.it
Accademia Olimpica, Vicenza - www.accademiaolimpica.it
Accademia roveretana degli agiati - www.agiati.it
Associazione Costitutori Viticoli Italiani - ACOVIT - www.acovit.it
Assoenologi - www.assoenologi.it
AAB (Association of Applied Biologists) - www.aab.org.uk
AAEDA-EVDV (Associazione Europea Degustatori Acquaviti Europäische Vereinigung der Destillat Verkoste) www.degustatoriacquaviti.eu
ADCF (Association pour le développement de la culture fourragère) - www.adcf.ch
AIAM - Associazione Italiana di Agrometeorologia - www.agrometeorologia.it
AIPP - Associazione Italiana per la Protezione delle Piante - www.aipp.it
ANAG (Associazione nazionale assaggiatori grappa e acquaviti) - www.anag.it
API - Associazione Piscicoltori Italiani - www.api-online.it
CISBA - Centro Italiano Studi Biologia Ambientale - www.cisba.it
Coloss - Honey bee research association - www.coloss.org
Federazione Nazionale degli Ordini dei Chimici e dei Fisici - Ordine Regionale dei Chimici e dei Fisici del Trentino Alto Adige www.chimicifisici.it
Federazione Italiana Dottori in Scienze della Produzione Animale - www.fidspa.it
Ordine Nazionale dei Biologi - www.onb.it
Ordine Nazionale dei Dottori Agronomi e Dottori Forestali - www.conaf.it
ONAF Organizzazione Nazionale Assaggiatori Formaggi - www.onaf.it
ONAV Organizzazione Nazionale Assaggiatori Vino - www.onav.it
Ordine dei Medici Veterinari - www.ordineveterinaritrento.it
Free Software Foundation - www.fsf.org
ICVG - International Council for the Study of Viruses and Virus-like Diseases of the Grapevine - www.icvg.org
IHC - International Honey Commission - //ihc-platform.net
IOBC/WPRS - International Organisation for Biological and Integrated Control of Noxious Animals and Plants - www.iobc-wprs.org
ISHS - International Society for Horticultural Science - www.ishs.org
MCI - Mastitis Council Italia - www.mastitalia.org
Claudio Ioriatti
Umberto Malossini, Roberto Larcher Paolo Fontana Paolo Fontana
Umberto Malossini (presidenza-segreteria)
Franca Ghidoni (segretaria di sezione), Luciano Groff (Consiglio Direttivo), Paolo Barchetti, Umberto Malossini, Sergio Moser, Ferruccio Pellegrini, Duilio Porro
Daniel Bondesan Sergio Moser
Gabriele Iussig
Stefano Corradini, Fabio Zottele
Claudio Ioriatti, Umberto Malossini, Gino Angeli Sergio Moser
Filippo Faccenda
Silvia Silvestri, Francesca Ciutti Paolo Fontana, Valeria Malagnini
Roberto Larcher, Mario Malacarne, Matteo Perini, Loris Tonidandel
Massimiliano Mazzucchi (Consiglio Direttivo) Cristina Salvadori
Massimiliano Mazzucchi Massimiliano Mazzucchi Luciano Groff
Erika Partel, Michele Povinelli
Fabio Zottele
Umberto Malossini, Valeria Gualandri
Valeria Malagnini Claudio Ioriatti
Duilio Porro, Dario Angeli Erika Partel
Società Chimica Italiana - www.soc.chim.it
SIN - Società Italiana di Nematologia - www.nematologia.it
SIMTREA - Società Italiana di Microbiologia Agraria, Alimentare e Ambientale - www.simtrea.org
SISS - Società Italiana della Scienza del Suolo - www.scienzadelsuolo.org
SIVE - Società Italiana di Viticoltura ed Enologia - www.siveonline.it
SILPA - Società Italiana Laboratori Pedologici e Agrochimici - www.silpalab.it
SOI - Società di Ortoflorofrutticoltura Italiana - www.soihs.it
The Orthopterists' Society - orthsoc.org
WAS - World Aquaculture Society - www.was.org
World Biodiversity Association onlus - https://biodiversityassociation.org/it
Roberto Larcher, Mario Malacarne, Matteo Perini
Umberto Malossini Raffaele Guzzon Raffaella Morelli
Umberto Malossini, Giorgio Nicolini
Laboratorio chimico, Andrea Ceschini (Consiglio Direttivo)
Umberto Malossini, Duilio Porro, Roberto Zanzotti, Raffaella Morelli
Paolo Fontana
Filippo Faccenda Paolo Fontana (Presidente)
Associazione Italiana Apiterapia
Paolo Fontana
Associazione regionale Apicoltori del Veneto Paolo Fontana (Consiglio direttivo)
Cluster SPRING - Cluster tecnologico nazionale della Chimica Verde Silvia Silvestri
Collegio dei Docenti del Dottorato di Ricerca Internazionale in Tecnologie e Biotecnologie Agrarie - Università del Molise Claudio Ioriatti Collegio dei Docenti del Dottorato di Agrifood and Environmental sciences - Università di Trento Roberto Larcher
Comitato Provinciale Pesca Filippo Faccenda
Consorzio Italiano Biogas - Adesione in qualità di socio istituzionale Silvia Silvestri
Comitato di gestione ente parco Paneveggio Pale S. Martino Giorgio Maresi
Comitato di gestione ente parco Adamello Brenta Cristina Salvadori
Comitato scientifico ANAG - Associazione Nazionale Assaggiatori Grappa e Acqueviti
Sergio Moser
Comitato scientifico Istituto Nazionale Grappa Sergio Moser
Commissione assaggio concorso Giornate del Riesling (Naturno, I)
Maurizio Bottura
Raffaele Guzzon Commissione assaggio concorso Giornate del Vino della Bassa Atesina Sergio Moser, Luciano Groff Commissione assaggio grappe per il rilascio del marchio dell’Istituto tutela grappa del Trentino Paolo Barchetti Comitato di certificazione e salvaguardia e imparzialità, nell'ambito dell'organismo di controllo delle denominazioni di origine di interesse provinciale della Camera di Commercio Industria Artigianato e Agricoltura di Trento
Commissione suolo Consorzio Vini Trentino Duilio Porro, Stefano Pedò
Commissione SQNPI Consorzio Vini Trentino Maurizio Bottura, Roberto Zanzotti, Gastone Dallago Commissione Biologico Consorzio Vini Trentino Daniele Prodorutti, Roberto Lucin Commissione concorso enologico Vini di Territorio Luciano Groff Commissione concorso “La vigna eccellente” per il miglior vigneto di Marzemino, Comune di Isera Bruno Mattè, Duilio Porro Commissione Disciplinare di produzione integrata Consorzio vini Maurizio Bottura, Claudio Ioriatti Commissione metodi analitici dell’Organizzazione Internazionale della Vigna e del Vino (OIV Commission II “OENOLOGY”) Matteo Perini (esperto)
Commissione provinciale di gestione Disciplinare di produzione integrata del settore melo
Gastone Dallago, Tommaso Pantezzi, Maurizio Bottura
Commissione provinciale di controllo Disciplinare di produzione integrata del settore melo Dario Angeli, Lorenzo Turrini Commissione provinciale di gestione Disciplinare di produzione integrata del settore piccoli frutti, orticoltura e mais da polenta
Claudio Ioriatti, Tommaso Pantezzi, Maurizio Bottura Commissione provinciale di controllo Disciplinare di produzione integrata del settore piccoli frutti, orticoltura e mais da polenta
Dario Angeli, Lorenzo Turrini
Comitato tecnico per la nutrizione e la sanità animale - sez. B - Ministero della Salute Claudio Ioriatti Comitato tecnico-scientifico rivista Vite & Vino (Edizioni L’Informatore Agrario)
Comitato redazione rivista Frustula entomologica
Raffaele Guzzon
Claudio Ioriatti
Comitato redazione rivista Current Opinion in Agriculture Claudio Ioriatti
Comitato redazione (Responsible Editor in Applied Entomology) rivista Turkish Journal of Entomology Claudio Ioriatti Consiglio Scientifico della Biblioteca Internazionale "La Vigna" - Centro di Cultura e Civiltà Contadina, Vicenza
CREA - Albo esperti nazionale (SSD-AGR/12 Patologia vegetale)
CREA-AA - Albo melissopalinologia
Paolo Fontana
Umberto Malossini
Valeria Malagnini
Eufrin (European Fruit Institutes Network) - Sustainable Fruit Production to minimize residues Working group Claudio Ioriatti, Gino Angeli
Eufrin (European Fruit Institutes Network) - Economics Giorgio De Ros
Gruppo di lavoro permanente per la protezione delle piante MIPAAF sez. Materiali di moltiplicazione della vite (D.M. 30.06.2016 n. 1173)
Gruppo di lavoro per la rete laboratoristica nazionale MIPAAF
Umberto Malossini
Valeria Gualandri
Gruppo di lavoro Diabrotica del Servizio fitosanitario nazionale
Gruppo di lavoro Interlab (studio della fertilità del terreno attraverso la cromatografia di Pfeiffer)
Gruppo di lavoro per i Supplementi difesa de L'Informatore Agrario
Gruppo di lavoro post-raccolta SOI-ISHS
Roberta Franchi, Pietro Giovanelli
Michele Morten
Maurizio Bottura, Gastone Dallago
Dario Angeli
Gruppo di lavoro viticoltura SOI Duilio Porro
Gruppo Ricerca Italiano Modelli Protezione Piante (GRIMPP) Gastone Dallago
Gruppo di lavoro analisi impiego prodotti fitosanitari e impatto sulla salute presso Dipartimento Territorio Agricol. Amb. For./PAT Gastone Dallago
Gruppo di lavoro PAT: implementazione PAN trattamenti centri abitati Gastone Dallago Gruppo di lavoro PAT: implementazione PAN trattamenti in ambito extra agricolo Gastone Dallago, Cristina Salvadori
Gruppo di lavoro: Misure per il miglioramento dello stato qualitativo dei corpi idrici con impatti da fitofarmaci utilizzati in agricoltura (Art. 8 PAN)
Gino Angeli, Daniel Bondesan, Andrea Branz
Gruppo di lavoro sull'agro-omeopatia - Scuola di Medicina Integrata di Palermo Michele Morten International technical working group for the EGVM, California, USA Claudio Ioriatti ISHS Membership - Workgroup Mineral Nutrition of Fruit Crops, Commission Irrigation and Plant Water RelationsCommission Plant Substrates and Soilless Culture Duilio Porro National Technical Working Group (Gruppo Tecnico Nazionale GLOBALG.A.P.)
Fabrizio Benvenuti
NPVV - Nucleo di Premoltiplicazione Viticola delle Venezie Maurizio Bottura Nucleo di Premoltiplicazione Viticola “C. Naldi” Regione Emilia Romagna Umberto Malossini (Comitato Tecnico Scientifico)
OIV Organizzazione Internazionale della Vite e del Vino - Esperto permanente nella sezione SPECIFIC Matteo Perini Servizio di Ispezione ai Centri di controllo funzionale delle macchine irroratrici (delibera PAT n. 2008 del 2012)
Sistema di qualità nazionale per la produzione integrata MiPAAFGruppo di lavoro difesa (DM 2722 del 17 aprile 2008)
Sistema di qualità nazionale per la produzione integrata MiPAAFGruppo di lavoro agronomia (DM 2722 del 17 aprile 2008)
Daniel Bondesan
Gastone Dallago
Gastone Dallago (supplente)
Tavolo Energia Provincia autonoma di Trento Silvia Silvestri
Tavolo biometano Agenzia Depurazione PAT (ADEP)
Nuovo PEAP - Piano energetico ambientale PAT
Silvia Silvestri, Luca Tomasi
Silvia Silvestri, Luca Tomasi
Tavolo tecnico-scientifico su Elateridi della patata MiPAAF Luigi Bertoldi
Tavolo di lavoro Gestione sostenibile degli effluenti zootecnici (Accordo di Programma APPA, Servizio Agricoltura PAT, FEM, APOT, FPA, Consorzio Vini)
Tavolo di filiera della frutta in guscio MIPAAF - Sezione Castagno
Tavolo nazionale di coordinamento nel settore dell'agrometeorologia MiPAAF
Tavolo settore zootecnico PAT (FEM, FPA, APSS, Ordine medici veterinari, CONCAST, Latte Trento)
Working
Silvia Silvestri, Andrea Cristoforetti, Roberta Franchi, Pietro Giovanelli
Cristina Salvadori
Stefano Corradini (Rappresentante regionale)
Ioriatti Claudio Dirigente Bozza Federica, Cimarolli Donatella, De Oliva Sarah, De Ros Giorgio, Demattè Lidia, Pancher Sabrina, Paternoster Cristina, Pedrazzoli Rudi
Ioriatti Claudio Responsabile Candioli Erica, Dalpiaz Michela, Tomasi Arianna

Unità Frutticoltura e piccoli frutti
Pantezzi Tommaso Responsabile
Barchetti Daniele, Bertagnolli Andrea, Berti Michele, Brentari Luca, Chini Maurizio, Conci Sandro, de Concini Matteo, Defant Cristian, Dorigoni Alberto, Flaim Damiano, Ganarin Gianpiero, Giuliani Gianluca, Gottardello Angela, Grassi Alberto, Guerra Andrea, Ianes Piergiorgio, Iob Cristian, Micheli Franco, Miorelli Paolo, Pasqualini Jonathan, Prantil Massimo, Springhetti Mario, Torresani Roberto
Personale non strutturato
Angeli Mattia, Gabardi Deborah, Iachemet Davide, Iori Lorenzo, Puppato Simone
Unità Protezione delle piante agroforestali e apicoltura
Angeli Gino Responsabile
Bondesan Daniel, Bragagna Paola, Cainelli Christian, Chiesa Serena Giorgia, Endrizzi Emanuel, Fontana Paolo, Gualandri Valeria, Malagnini Valeria, Maresi Giorgio, Pedrazzoli Federico, Rizzi Claudio, Salvadori Cristina, Sofia Monica, Tolotti Gessica, Zanotelli Livia
Personale non strutturato
Bargna Sacha, Borri Giacomo, Chini Loris, Clappa Elena, Feltrin Angela, Fiaschetti Marco, Gallimbeni Luca, Marchesini Alexis, Tenci Maria Vittoria, Vicelli Bianca
Bottura Maurizio Responsabile
Andreatti Nicola, Bianchedi Pier Luigi, Cainelli Roberta, Delaiti Lodovico, Gelmetti Alberto, Ghidoni Franca, Malossini Umberto, Margoni Michele, Matte’ Bruno, Mattedi Flavio, Morten Michele, Panizza Claudio, Pedo’ Stefano, Pellegrini Ferruccio, Penner Francesco, Porro Duilio, Zaffoni Mattia
Personale non strutturato
Pezzè Massimo, Soini Matteo
Dipartimento Ambiente e agricoltura di montagna
Silvestri Silvia Responsabile
Unità Acquacoltura e idrobiologia
Faccenda Filippo Responsabile
Baruchelli Giovanni, Cappelletti Cristina, Ciutti Francesca, Faccenda Filippo, Tanel Marco
Personale non strutturato Povinelli Michele
Unità Agricoltura biologica
Prodorutti Daniele Responsabile
Bertoldi Luigi, Branz Andrea, Forno Flavia, Gobber Marino, Lucin Roberto, Maines Romano, Morelli Raffaella, Zanzotti Roberto
Personale non strutturato
Chiusole Marco, Cersosimo Ippolito Marco Cristiano, Rizzi Erica, Zanoni Paolo, Zanoni Sara
Personale in distacco Toniolli Fabio
Unità Agrometeorologia e sistemi informatici Corradini Stefano Responsabile Andreis Daniele, Biasi Alessandro, Paternolli Ugo, Piffer Ivan, Zottele Fabio
Unità Risorse ambientali energetiche e zootecniche Silvestri Silvia Responsabile Bona Daniela, Cristoforetti Andrea, Franchi Roberta, Giovanelli Pietro, Grandi Luca, Mazzucchi Massimiliano, Partel Erika, Peterlini Marco, Sandri Nicola, Sicher Adriano, Tomasi Luca Personale non strutturato Iussig Gabriele, Bellistri Elisa
Larcher Roberto Responsabile
Unità Chimica vitienologica e agroalimentare Larcher Roberto Responsabile Barbero Alice, Barchetti Paolo, Bertoldi Daniela, Ceschini Andrea, Colapietro Marco, Dalvit Federica, Malacarne Mario, Nardin Tiziana, Nicolodi Tullia, Paolini Mauro, Perini Matteo, Pianezze Silvia, Pilati Michela, Rossi Sergio, Sartori Loretta, Sigismondi Lorena, Todeschi Stefania, Tonidandel Loris, Trainotti Debora Personale non strutturato Decarli Fabrizio, Facchinelli Michele, Martinelli Francesca, Pozza Noemi, Zanoni Giorgio
Unità Centro di saggio Dallago Gastone Responsabile Baldessari Mario, Delaiti Marco, Mucci Massimo, Tomasi Cristina
Unità Trasformazione e conservazione Roman Tomas Responsabile Angeli Dario, Facchinelli Giovanna, Groff Luciano, Guzzon Raffaele, Moser Sergio, Schiavon Silvia, Turrini Lorenzo, Zeni Fabio Personale non strutturato Gabardi Davide, Torriani Michele, Villa Ilaria
Hanno collaborato con noi i dipendenti a tempo indeterminato dell’Azienda Agricola FEM: Caset Danilo, Delvai Walter, Giuliani Graziano, Moscon Renzo
Hanno frequentato le nostre strutture: 37 frequentanti per dottorati di ricerca, tirocini curricolari, tesi di laurea, alternanza scuola lavoro, tirocini formativi Erasmus Plus per un totale di 3.590 giornate lavorative.
• Centro Istruzione e Formazione
• Centro Ricerca e Innovazione
• Centro Trasferimento Tecnologico
• Ufficio Sviluppo e comunicazione
Dipartimento Innovazione delle produzioni vegetali
• Unità Certificazioni agroalimentari e ambientali
• Unità Frutticoltura e piccoli frutti
• Unità Protezione delle piante agroforestali e apicoltura
• Unità Viticoltura e olivicoltura
• Unità Agricoltura biologica
• Unità Acquacoltura e idrobiologia
• Unità Agrometeorologia e sistemi informatici
• Unità Risorse ambientali energetiche e zootecniche
• Unità Centro di saggio
• Unità Chimica vitienologica e agroalimentare
• Unità Trasformazione e conservazione
Finito di stampare nel mese di dicembre 2022
Da Nuove Arti Grafiche, Gardolo (TN)